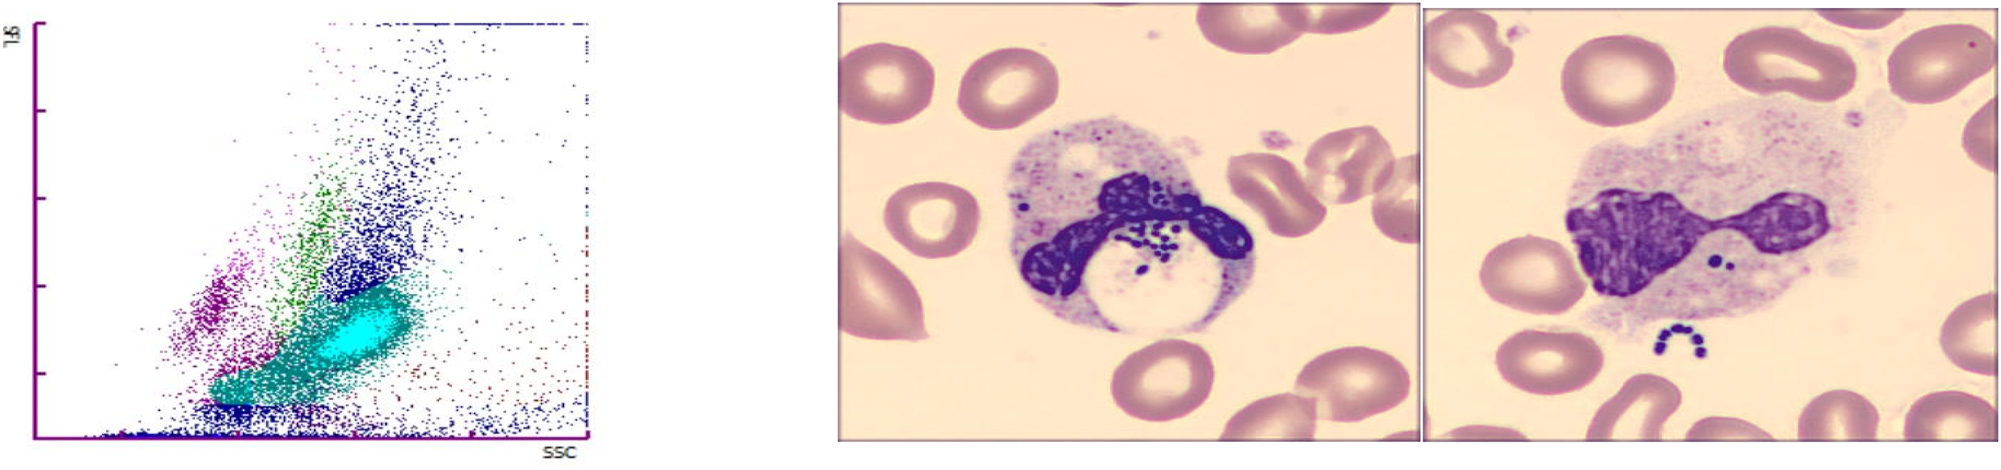
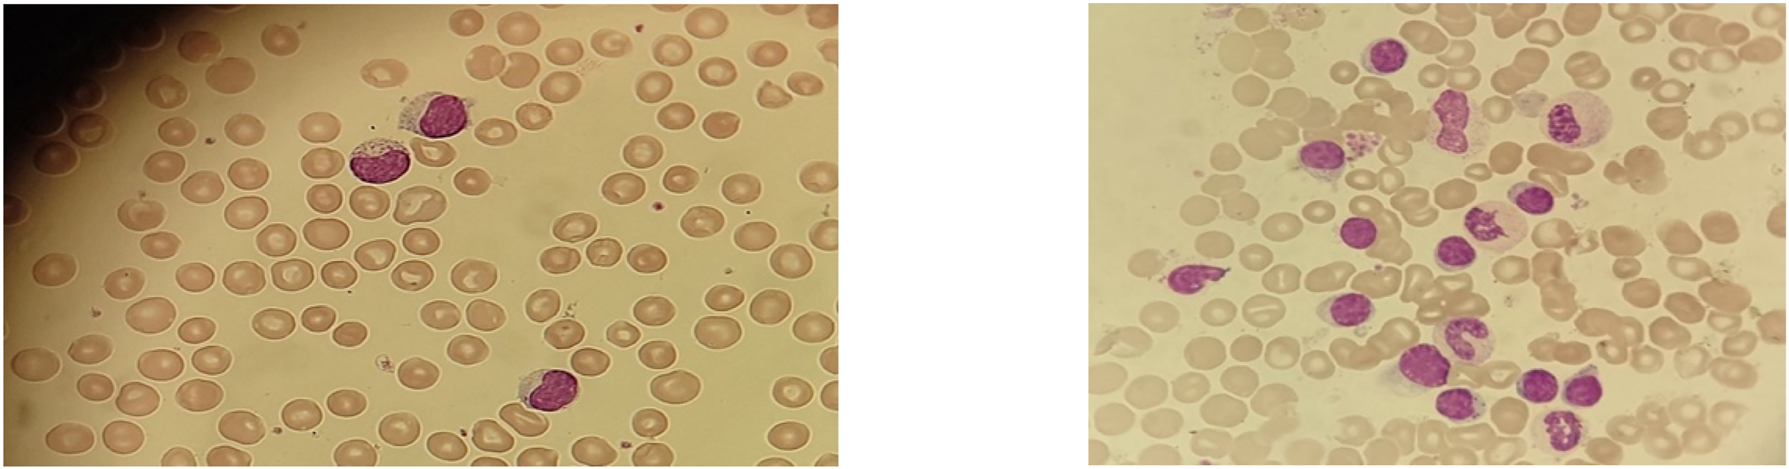
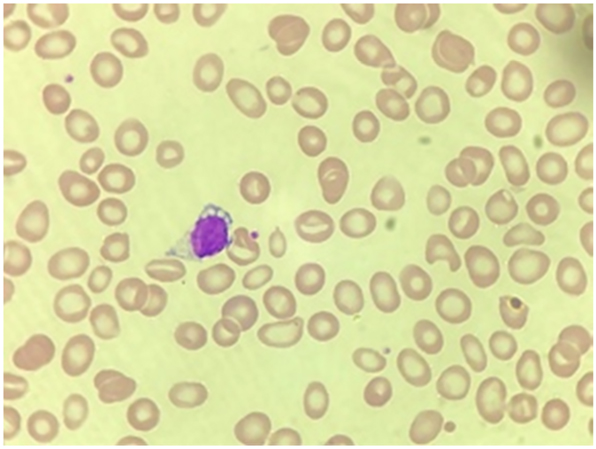
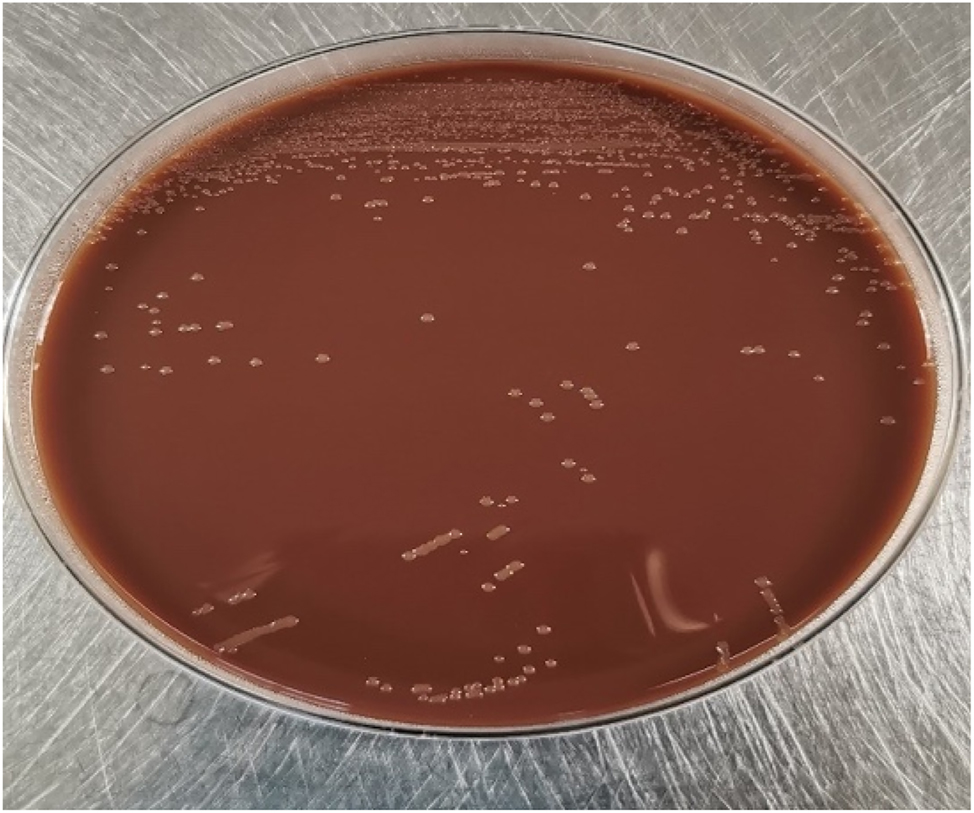

15th National Congress of the Portuguese Society of Clinical Chemistry, Genetics and Laboratory Medicine
Scientific Committee
Adriana Pedrosa
Ana Paula Azevedo
Ana Paula Castro
Ana Paula Faria
Caterina Faria Coelho
Elsa Gonçalves
Eulália Costa
Fátima Vale
Fernando Rodrigues
Henrique Reguengo
João Faro Viana
João Mário Figueira
João Tiago Guimarães
Jorge Nunes de Oliveira
Luísa Espinhaço
Lurdes Pereira
Manuela Ribeiro
Maria José Teles
Maria Luís Queirós
Rosário Luís
Rui Farinha
| ORAL COMMUNICATION AWARD SESSION
CO01
THE IMPORTANCE OF SYSTEMATIC ANALYSIS OF CHROMATOGRAMS: WHAT COULD HAVE BEEN MISSED?
Sandra Monteiro, Rui Figueiredo1, Mohsen Rostami1, Carlos Cortes1
1 Centro Hospitalar Médio Tejo
Keywords: chromatograms, hemoglobinopathies, diabetes monitoring, screening
Background: Hemoglobinopathies are the most common group of genetic disorders worldwide. They mainly result from autosomal recessive transmission of mutated genes behind the synthesis of globin chains, and fall into two main groups: thalassemia syndromes, and structural haemoglobin (Hb) variants. Although some Hb variants are silent in heterozygotes, they can be severe in homozygous forms.
Aim: To analyse the incidence of hemoglobinopathies in all samples studied both for guided screening and incidental finding, in the last 5 years and to show up the laboratory contribution in screening these conditions.
Methods: Data collection from LIS and Hospital Health Care System in our laboratory during Jan 2018 to Feb 2023. A total of 41003 samples were included in the study, 495 with directed request and 40508 for diabetes monitoring only. Hb A2, Hb F and Hb variants analysis was performed by HPLC. Then, electrophoresis was performed. Hb S was confirmed by the solubility test. In order to identify rare Hb variants, some samples were sent to a reference laboratory for alternative methods and/or by molecular biology analysis.
Results: After eliminating the duplicates, a total of 6144 individual samples were studied, of which 199 (3.2%) had genetic Hb disorders. From 495 requested tests by physician, 71 (14.3%) had disorders, while 128 (64.3%) were suggested by lab stuff. The main condition found in the studied population were sickle cell trait (46.2%), followed by β-thalassemia minor (26.1%), Hb Lepore (11.6%), and others. Rare cases were found with co-inheritance of heterozygous alpha thalassemia and sickle trait (0.5%), and Hb E in heterozygous condition (HBB: c.79G>A; p.Glu27Lys) and compound heterozigoty in the gene HBA del--SEA/ HBA2: c.369C>G; pHis123Gln (Hb Westmead) (0.5%).
Conclusion: This study revealed that few genetic Hb disorders derived from oriented study. Our results also highlighted that clinical pathology service is essential in routine chromatograms analysis to screening hemoglobinopathies. Most, came of unintentional lab findings of carriers unaware of their status. Our results show a significantly higher prevalence of hemoglobinopathies compared to last Portuguese population data. In addition, those data fully justify an accurate analysis of all chromatograms.
CO02
BORN WITH LEUKEMIA: A RARE DIAGNOSIS
Maria Matos Silva1, Maria Figueiredo1, Andreia Meireles1, Inês Paiva Ferreira1, Rita Francisco1, Cristina Fonseca e Silva1, Pedro Gouveia1, Joaquim Freitas1, André Silva1, Maria Calle1
1 Centro Hospitalar do Tâmega e Sousa
Introduction: Congenital Leukemia (CL) is an extremely rare diagnosis, with a reported incidence of 1 per 5 million births. It is a disorder that develops in utero, with clinical manifestations after birth or shortly thereafter. Most CL are myeloid in origin, unlike pediatric leukemias, which are usually lymphoid.
Case Report: A full term male newborn, adequate for gestational age, with no relevant family history, was born after an uncomplicated pregnancy apart from a prenatal diagnosis of alloimmunization by Kell antigen. Physical examination a few hours after birth was unremarkable except for the presence of widespread purple nodules on his skin. Blood test results revealed a complete blood count (CBC) with a mild non-regenerative anemia and hyperleukocytosis (106 600/µL), a positive direct antiglobulin test, and elevated AST and LDH without hyperbilirubinemia. Due to CBC abnormalities, a peripheral blood smear (PBS) was performed, which showed the presence of 71% of immature cells, with a high nucleus-cytoplasm ratio, fine chromatin, 1-2 nucleoli and some with granules on their cytoplasm. The presence of a high percentage of apparent blasts circulating in peripheral blood, with hyperleukocytosis and the widespread purple nodules on the skin, raised the suspicion of a probable CL. Given the lack of a Pediatric Haematology Department in the referring hospital, the newborn had to be transferred to another hospital for further studies and management of the disease.
Discussion: CL represent about 0,8% of all childhood leukemias, and can present a diagnostic challenge due to the heterogeneity of clinical presentation. Therefore, a multidisciplinary approach and cooperation between clinicians and the laboratory are fundamental. Analysis of the PBS can be indispensable as an auxiliary diagnostic tool to help in the guidance of patient management in a hospital where there is a lack of more specific diagnostic methodologies such as immunophenotyping through flow cytometry.
CO03
VELA® AUTOMATED NEXT GENERATION SEQUENCING PLATAFORM: THE EXPERIENCE OF A LABORATORY IN A CENTRAL HOSPITAL
Júlia Henriques1, Isabel Diogo1, Sandra Fernandes1, Inês Costa1, Maria de Fátima Gonçalves1, Joaquim Cabanas1, Perpétua Gomes1
1 Centro Hospitalar de Lisboa Ocidental
Introduction: Next generation sequencing is a new technology for nucleic acid sequencing and mutation/variant detection that allows to sequence thousands of genes in a short period of time. The application of this methodology to HIV-1 antiretroviral resistance tests (RT) allowed to increase significantly the sensitivity of resistance associated mutation detection (RAM) in the minority populations compared to the traditional Sanger sequencing (5% vs 20%).
Objective: To evaluate the experience of the implementation of NGS methodology to perform HIV-1 antiretrovirals RT (reverse transcriptase, protease and integrase inhibitors), between January 26, 2022 and January 31, 2023. Patient’s samples came from several hospitals in the center and south of Portugal.
Material and Methods: Plasma samples in EDTA/K3 tube were processed for sequencing in the Sentosa® system. The workflow includes viral RNA extraction and library preparation on the Sentosa® SX101; emulsion PCR and enrichment in Sentosa® ST401; Ion Torrent sequencing on the Sentosa® SQ301. The reports are generated by the Sentosa® SQ Reporter software according to the interpretation algorithms Rega 10.0, ANRS 30 and HIVdb 9.1. The data under analysis was taken from the Clinidata XXI® laboratory software.
Results: 966 samples were processed. 53 samples did not amplify (28 of which had CV < 500 cp/mL). Of the 913 samples that amplified: 730 samples were negative (no RAM detected) and in 183 samples RAM were detected – 176 samples in the RT/Protease region and 22 samples in the Integrase region. Samples with positive RT correspond to 54% of treated patients and 32% of treatment naïve patients. The most prevalent subtype was subtype B (35%) and the recombinant CRF02_AG (16%). The most frequent found mutations were: M184V (NRTI) in 33%, K103N/S (NNRTI) in 38%, L90M (IP) in 7% and R263K and N155H (integrase inhibitors) in 4% of the samples.
Conclusion: Currently NGS is a daily practice in our Molecular Biology Laboratory and its implementation was particularly challenging due to laboratory reorganization, cost management and technical team training. The greater sensitivity of NGS contributes to the detection of RAM or variants in minority populations (at a frequency >5%) that arise under pharmacological pressure and it is of extremely importance to help clinicians to choose the best antiretroviral therapy to overcame resistance in HIV patients.
CO04
COMPARISON OF RAST WITH CONVENCIONAL METHODS
Luís Albuquerque1, João Neves1, Aurélio Mesquita1
1 Serviço de Patologia Clínica - Hospital de Braga
Introduction: Sepsis is a complex process that is recognized as a cause of morbidity and mortality worldwide. The patient’s outcome is critically influenced by the delay in identifying the pathogen and implementing antimicrobial therapy.
To this end, the EUCAST proposed a direct and rapid antimicrobial test susceptibility (RAST), by disk-diffusion, directly from positive blood cultures, using a shorter incubation time and cut-off points for the interpretation of inhibition halos for different classes of antibiotics.
Objectives: This study was performed to evaluate EUCAST blood culture RAST for Gram-negative organisms.
Materials: Prospective and observational study performed during routine in a clinical microbiology laboratory of Braga Hospital. RAST was performed from positive BC for Eschirichia coli (n=28), Klebsiella pneumoniae (n=12) and Pseudomonas aeruginosa (n=8), and zones read after 4, 6 and 8 hours (h).
The results were compared with the standard breakpoints from EUCAST, through VITEK®2 (16-20h) and Categorical Agreement (CA) was analyzed. Very major errors (VME), major errors (ME) and minor errors (mE) were determined.
The identification of the microorganisms was obtained through MALDI-TOF MS.
Results: The non-readable zones (NRZ) decreased in time and were only observed at 4h for E. coli and K. pneumoniae, and at 6h for P. aeruginosa; the number of NRZ was higher for Piperacillin-Tazobactam at the 4h of reading.
There were no VME; ME decreased in time, being higher for Amikacin at the 4h of reading.
When CA was low, the number of mE increased in time (Gentamicin, Piperacillin-Tazobactam and Amikacin); on the other hand, when CA was high, the number of mE decreased in time (Meropenem, Ceftazidime and Ciprofloxacin). There was no false susceptibility.
Conclusion: RAST is a tool that improves the management of sepsis, by providing rapid phenotypic susceptibility data. This data indicate that the reading at 4h may be used for Ceftazidime and at 6-8h for Ceftazidime, Meropenem and Ciprofloxacin. The other antibiotic had lower CA and need further analysis and technical development.
CO05
A 5-YEAR ANALYSIS OF CAMPYLOBACTER SPP. INFECTION IN PATIENTS WITH COMMON VARIABLE IMMUNODEFICIENCY: CONCERNS WITH ANTIBIOTIC RESISTANCE
Ana Catarina B. Marques1, Yuliya Volovetska1, Dinah Carvalho1, Pedro Cabral1, L. Marques Lito1, J. Melo Cristino1
1 Clinical Pathology Department, Centro Hospitalar Universitário Lisboa, Lisbon, Portugal
Introduction: Common variable immunodeficiency (CVID) is a primary immunodeficiency disease characterized by reduced serum immunoglobulins and high predisposition to infections. Campylobacter spp. is a common cause of gastrointestinal infection in this population, associated with higher risk of reinfection with different strains and extradigestive complications.
Our objective was to evaluate the 5-year casuistry of Campylobacter spp. isolates in patients with CVID and compare data with non-CVID patients.
Methods: We conducted a retrospective observational study including positive results for Campylobacter species from stool and blood samples from 2017 until 2021, isolated on CCDA (Campylobacter Blood-Free Selective Medium - Preston modified) and identified by MALDI-TOF. For the antimicrobial susceptibility testing (AST), EUCAST breakpoints and guidance were used. Chi-square test was used in categorical variables.
Results: We analyzed 207 Campylobacter spp. isolates from 108 patients with CVID and 405 Campylobacter spp. isolates from 359 non-CVID patients, during 2017-2021. In both populations, positive cultures were more frequent in males (55% and 63%, respectively). Stool samples were the most frequent with positive results (96%, n=207). In CVID-patients C.jejuni (49%, n=207) and C.coli (44%, n=207) were the most frequently identified species. However, in non-CVID patients C. jejuni showed a higher expression (84%, n=405, ρ < 0,001).
AST results isolates from patients with CVID (n=207) showed high resistance to ciprofloxacin (96,4%) and tetracycline (73,5%), as well as in non-CVID patients (n=405), 94,6% and 73,1% respectively. Also, high resistance to erythromycin (55,2%) was observed in patients with CVID, in contrast to non-CVID patients (23,2%), ρ < 0,001. Actually, the higher resistance to erythromycin is associated with the C. coli isolates (ρ < 0,001).
Conclusion: Considering that in CVID-patients recurrent, prolonged, and complicated campylobacteriosis are frequent, the monitoring of isolates is relevant for follow-up.
Notable resistance for recommended antimicrobial therapeutic drugs, as also confirmed in our study, and known high risk of reinfections in these patients should encourage the implementation of continuous surveillance.
CO06
ALLOIMMUNIZATION IN HEMATO-ONCOLOGICAL PATIENTS
Susana Silva1, Gabriela Lima1, Cidália Vasconcelos1, Vanessa Borges1, Natércia Sousa2, Ana Spínola3
1 Serviço de Patologia Clínica, Centro Hospitalar de Entre o Douro e Vouga, E.P.E.
2 Serviço de Sistemas e Tecnologias de Informação, Centro Hospitalar de Entre o Douro e Vouga, E.P.E.
3 Serviço de Imuno-hemoterapia, Centro Hospitalar de Entre o Douro e Vouga, E.P.E.
As per current statistics, only 0.1 to 2% of transfused patients produce red blood cell (RBC) antibodies with the highest rate being noted in RBC transfusion-dependent patients, in which alloimmunization is around 10-38%but the clinic manifestations are quite rare, around 0,05%.
Aim: To evaluate the prevalence of alloimmunization by transfusion in cancer patients at the Hemato-Oncology Department between 2018 and 2022 and also prevalence of antibody type.
Methods: A cross-sectional study was carried out using clinical and laboratory records in which variables such as sex, age, clinical diagnosis, ABO blood group, Rh phenotype (D, C, c, E, and e) and antibody screening test were analysed. Auto-antibodies were excluded from this study.
Results: A total of 1335 transfusions episodes, corresponding to 176 patients (91 women ,85 men), were included. A median of 3 transfusion episodes per patient was observed (range 2 - 20). Patient’s median age was 81 years old (range 48-99) and the following clinical diagnosis were observed: 44 multifactorial anaemia, 44 myelodysplastic syndromes (MDS), 18 Non-Hodgkin lymphoma, 18 Multiple myeloma, 13 acute leukaemia, 10 iron deficiency anaemia, 9 symptomatic anaemia of unknown cause, 4 chronic anaemia, 4 chronic lymphoproliferative disorders, 4 chronic leukemia, 2 Hodgkin lymphoma, 2 myelofibrosis, 2 autoimmune haemolytic anaemia, 1 megaloblastic anaemia and 1 pancytopenia due to liver disease.
Alloimmunization was detected in 5.1% (9/176) of the transfused patients. In these 55.5% (5/9) patients had more than one alloantiboy detected. Alloantibodies identified were: 2 anti-D, 2 anti-C, 2 anti-K, 1 anti-E, 1 anti-e, 1 anti-c,1 anti-Cw, 1 anti-Kpa, 1 anti-Kpb, 1 anti-k,1 anti-Lub, 1 anti-Lua,1 anti-Jka, 1 anti-Leb and 1 anti-P1. The main diagnostic group of patients with alloantibodies was MDS, representing 44.4% (4/9) of all patients.
Conclusions: The alloimunization prevalence observed in our study is in line with the literature. Most fo the alloantibodies identified were against the Rh system despiste the blood bank routine protocol of crossmatching and providing ABO and Rh-identitical RBC units for transfusion. The adopted practice is an integral part of serological safety.
CO08
“KNOCK, KNOCK! ANY DUCT?” – A CASE REPORT OF VANISHING BILE DUCT SYNDROME (VBDS)
Ana Venâncio de Barros1, Ana Catarina B. Marques1, Carlos Lemos1, Filipa Paramés1, Cristina Vaz Carneiro1
1 CHULN
Introduction: VBDS is an acquired rare liver disease marked by a progressive loss of intrahepatic bile ducts and hepatic ductopenia, which leads to cholestasis. There are many diseases associated with the development of VBDS, including infections, autoimmune diseases, some neoplasms, and drugs toxicity. The mechanisms of this condition are not well established. Typically, patients present persistent pruritus, fatigue and jaundice, high alkaline phosphatase (ALP) and bilirubin levels, sometimes with hypercholesterolemia, higher serum bile acid and skin xanthomata. Prognosis is variable and markedly dependent on the etiology. Despite the therapy with ursodeoxycholic acid, the condition tends to result in biliary cirrhosis and end-stage liver disease, ultimately requiring liver transplantation.
Aim: To describe a rare case of VBDS.
Clinical Report: 23-year-old man with a history of vitiligo and psoriasis was referred to a Gastroenterology appointment in March 2020, due to slight jaundice and hyperbilirubinemia (2.8mg/dL). As upper abdominal ultrasound showed no changes, Gilbert’s syndrome diagnosis was raised. Further analysis included the search for several auto-antibodies: antinuclear cytoplasmic (ANA), anti-liver-kidney microsomal (anti-LKM), citrulline (CCP), anti-double stranded DNA (Ac. Anti-DS-DNA), antiparietal gastric cell (APCA), anti-mitochondria (AMA) and smooth muscle actin (ASMA), all undetected; liver enzymes, including ALP, and alpha-fetoprotein all within reference values; unchanged serum protein electrophoresis and total bilirubin still high (2,42mg/dL). One year later, the patient developed palmoplantar pruritus and he has kept an elevated total bilirubin level (3.2mg/dL). A magnetic resonance cholangiopancreatography revealed partial peripheral ductopenia, and since then, the patient has been medicated with ursodeoxycholic acid, clinical and analytically monitored as an out-care patient in gastroenterology.
Conclusion: VBDS is a rare disease, poorly studied and known, and this case exposes a different clinical and laboratory presentation on the subject. The clinical history is crucial to build diagnosis in a condition with such unspecific laboratory findings.
Disclosure: No conflicts of interest.
CO09
FOLIC ACID AND B12 VITAMIN DETERMINATION: WHEN MORE IS TOO MUCH
Bruno Esteves1, Anália Carmo2, Fernando Rodrigues2
1 Serviço de Patologia Clínica do Centro Hospitalar Universitário Cova da Beira
2 Serviço de Patologia Clínica do Centro Hospitalar e Universitário de Coimbra
Introduction: Folic acid (FA) and vitamin B12 (B12) deficits are associated with the development of neuropathy and anemia. Clinical laboratories play a central role in diagnosing these deficits since the associated symptoms can go unnoticed in the early phase of the pathological processes. However, there are no guidelines regarding when these parameters should be determined. Over the last few years there is a growing concern with the rational prescription of laboratory parameters to achieve an efficient management of the resources. Nevertheless, studies on the economic evaluation of FA and B12 dosage are scarce.
Objectives: We aim to evaluate the results and the costs associated to the determination of FA and B12 in the Emergency Department.
Methods: A retrospective and observational study to determine hematimetric indicators and the serum levels of FA and B12 from patients at the Emergency Department, between 1/1/2021 and 29/8/2022. Patients were grouped according to the concentration of haemoglobin and to the mean corpuscular volume. In patients without macrocytic anemia, but to whom the serum level of FA and B12 was low, the clinical file was analysed to identify risk factors associated to the deficits.
Results: Complete blood counts were requested to 63547 patients. Among them, FA and B12 were requested in 651 and 677 of the cases, respectively. FA deficit was present in 17.3% patients with macrocytic anemia, in 8.2% patients with microcytic anemia, in 11.3% patients with normocytic anemia and in 12.1% patients that did not presented anemia. In turn, B12 deficit was identified in 25.6% patients with macrocytic anemia, in 4.9% patients with microcytic anemia, in 5.0% patients with normocytic anemia and in 3.1% of patients that did not presented anemia. In patients without macrocytic anemia, B12 deficit was associated with iatrogenic risk factors such as metformin medication, proton pump inhibitors and bariatric surgery.
Conclusion: The levels of B12 and FA were normal in the large majority of the patients from the Emergency Department, indicating that there is a waste of resources associated to these two parameters and increase the costs. The deficits of B12 and FA were associated to macrocytic anemia and to iatrogenic factors suggesting that these two factors could help to establish a guidance for the request of these parameters.
CO10
“HEAVY OR LIGHT, THE RESULT MUST BE RIGHT” - AN IMPORTANT REFERENCE OF HEAVY/LIGHT CHAIN REAGENTS AS A COMPLEMENTING TOOL TO IMMUNOFIXATION
Ana Venâncio de Barros1, Ana Catarina B. Marques1, Andreia Calvário1, Carlos Lemos1, Filipa Paramés1, Cristina Vaz Carneiro1
1 CHULN
Introduction: Heavy chain diseases (HCD) are rare lymphoplasmacytic proliferative disorders that produce a truncated immunoglobulin (Ig) heavy chain with no light chain. Once the heavy chain is truncated, a localized monoclonal peak may not be present in a routine serum protein electrophoresis (SPEP), requiring immunofixation (IFE). Gamma HCD (γ-HCD) is one of the 3 rare B-cell neoplasms that constitute HCD. Less than 200 cases have been reported. Diagnosis is made through IFE.
Aim: To confirm a y-HCD diagnosis made by IFE using a nephlometric assay.
Materials and Methods: A serum sample from a patient previously diagnosed with y-HCD, was used to measure the intact total IgG (7,1-15.4 g/L), IgG kappa, IgG lambda and calculate the (IgGk+IgGλ) / IgGtotal ratio (0.8-1.12) and IgGk:IgGλ (0.71–3.23) in order to quantify the portion of IgG that is derived from monoclonal plasma cell clone. A nephlometric assay was performed on a BN™ II System (Siemens), using an immunoglobulin heavy/light chain reagent (HLCR) - Hevylite® (The Binding Site) which targets the unique junctional epitopes between immunoglobulin heavy chain and light chain combination.
Results and Discussion: SPEP showed a protein migration on beta/gamma fraction, and the IFE presented an IgG heavy chain band without a corresponding light chain band. Through nephlometric assay we obtained: IgGtotal = 4,57 g/L; IgGk = 0.67 g/L; IgGλ = 0.55 g/L; (IgGk+IgGλ) / IgGtotal ratio = 0.27; IgGk:IgGλ ratio = 1,218; IgGtotal - (IgGk+IgGλ) = 3,35 g/L.
The results obtained were the expected and similar to those described in the literature. The total IgG concentration is low - the majority of IgG is truncated. (IgGk+IgGl)/IgGtotal ratio is also low, suggesting the presence of a monoclonal heavy chain with little to no intact light chain. Since the IgG is not recognized by the HCLR, [IgG–(Gκ+Gλ)] is an indirect measure of the monoclonal heavy chain fragment concentration.
Conclusion: We confirmed the y-HCD diagnosis using HLCR. The heavy/light chain analysis is a simple and fully automated polyclonal antibody serum test for intact immunoglobulin monoclonal gammopathies. It may be very useful to confirm dubious results on IFE, once it relies on quantification rather than a subjective interpretation. This test provides rapid accurate results that play an important role in diagnosis, monitoring and prognosis of some important rare pathologies, such as HCD.
Disclosure: No conflicts of interest.
CO11
PRESEPSIN: A PROMISING BIOMARKER FOR THE DETECTION OF BLOOD STREAM INFECTIONS
Margarida Peixinho1, Bruno Esteves2, Catarina Chaves1, Fernando Rodrigues1
1 CHUC
2 CHUCB
Sepsis is a life-theatening entity causing millions of deaths worldwide. Early recognition of sepsis not only helps in the optimization of treatment but also improves the overall outcome. New biomarkers are emerging for prediction diagnosis and the severity of sepsis, such as presepsin.
Prospective observational study included 57 patients with systemic inflammatory response syndrome from different units, in a terciary hospital. The study was done between September 2021 and June 2022. Presepsin (PSP) and procalcitonin (PCT) were determinated in serum samples by immunoenzimatic assay and chemiluminescent microparticle immunoassay, respectively.
The aim of the study was to compare the diagnostic accuracy of serum levels of PSP and PCT in the diagnosis of sepsis.
The optimal cut-off value of the PSP level to discriminate between sepsis and non-infectious organ failure was 850.30 pg/mL showing areas under the receiver operating characteristic curve (AUC) of 0.974 (95% CI, 0.94 – 1.00). PSP shown 91.4% of sensibility and 91.0% of specificity to discriminate between sepsis and no sepsis patients.
For PCT, the cut-off value used for discrimination between sepsis and no sepsis was 0.6 ng/mL showing AUC of 0.821 (95% CI, 0.71 - 0.94). The analysis of 57 samples resulted in classification of 36 positive and 21 negatives, with a sensibility of 77,8% and a specificity of 76%.
In conclusion, presepsin levels were significantly higher in patients with bacterial infections. This biomarker has good sensibility and specificity and could be helpful in early diagnosis of sepsis.
CO12
THE FIRST OF US – ISOLATION OF RASAMSONIA ARGILLACEA FUNGUS IN A IMMUNOCOMPROMISED PATIENT
Gouveia Pereira1, Helena Peres1
1 CHULC
A 46-year-old man, born in Cape Verde, living in Portugal with a history of renopancreatic transplantation 4 years ago with a record of active tuberculosis 17 years ago, treated at the time.
He was hospitalized due to COVID 2 months ago and the CT-scan revealed “lung scarring, bronchiectasis and calcified nodules, apparently residual”.
In a periodic evaluation, for exclusion of active tuberculosis, a bronchofibroscopy was performed. It revealed diffuse edema of the bronchial mucosa, and a bronchial washing (BW) and bronchoalveolar lavage (BAL) were performed for microbiological analysis. No AARB were observed in both samples, and NAAT for TB in BW was negative. Mycobacteriological culture is negative until date.
BAL and BW Gram staining revealed scarce microbial population and rare leukocytes, and BW additionally revealed some epithelial cells.
BAL and BW cultural exams were reported as a scarce saprophytic polymicrobial population of the upper airways.
Mycological culture of BW in Sabouraud agar medium after 4 days of incubation at 37ºC showed several velvety cream-colored colonies, identified by MALDI-TOF as Rasamsonia Argillacea complex. Mycological culture for BAL was negative.
For the time being, the patient is hospitalized due to hydropneumothorax post-bronchofibroscopy with empyema having started empirically voriconazole.
Antifungal sensitivity testing revealed high minimal inhibitory concentrations (MIC) to fluconazole, amphotericin, itraconazole and voriconazole and MIC < 0.002 mg/L to anidulofungin. Although there are no breakpoints defined by EUCAST for this agent, MIC described were in agreement with those described in literature.
Rasamsonia argillacea is a rare thermotolerant fungal pathogen. In the past few years, rare cases of infection and colonization have been described worldwide in humans and animals, namely dogs. Human infections are mainly associated with pathologies such as cystic fibrosis and chronic granulomatous disease. The isolation of this fungus in immunocompromised patients requires surveillance due to increased susceptibility to severe infection and complications.
To date, only one case of isolation of Rasamsonia argillacea has been reported and published in Portugal (2021). The present case is the first ever isolated in our Hospital Medical Center.
|SESSÃO COMUNICAÇÕES ORAIS RÁPIDAS
CR01
THE NEED OF VITAMIN D SUPPLEMENTATION DURING PREGNANCY AND BREASTFEEDING; A DECISION BASED ON THE PREVALENCE OF VITAMIN D DEFICIENCY
Cristina de Mello-Sampayo1, Inês Stilwell2, Maria Cristina Marques3
1 1. Departamento Farmácia, Farmacologia e Tecnologias em Saúde da Faculdade de Farmácia da Universidade de Lisboa, 2 Research Institute for Medicines (iMed.ULisboa), Faculty of Pharmacy, Universidade de Lisboa
2 Clínica Cintramédica, Sintra, Portugal,
3 Departamento Farmácia, Farmacologia e Tecnologias em Saúde da Faculdade de Farmácia da Universidade de Lisboa
Portugueses have high predisposition for Vitamin D (vit.D) shortness. There is evidence that low levels of Vit.D or calcium during pregnancy and prenatal period predisposes the woman to pathologies such as pregnancy diabetes, hypertension or pre-eclampsia, eventual fragility fractures or osteoporosis.
WHO defines 25(OH)D scarcity in adults at values ≤30ng/ml, distinguishing insufficiency (20-30ng/ml) from deficiency (<20ng/ml), and recommends supplementation during pregnancy and lactation, to maintain serum levels above 30ng/ml. However, the DGS guideline (2019) does not recommend it.
Aim: assess 25(OH)D levels in women of childbearing age to infer the need for vit.D supplementation during pregnancy.
25(OH)D was measured by ECLIA 3rd generation (COBAS 6000), in women aged 20-44 years, random chosen, from January-November 2022. Data regarding vit.D supplementation were collected by questionnaire. The study was conducted in accordance with the ethical principles of Helsinki Declaration.
Of the 1535 women, mean age 34 years, 3 had values above the 25(OH)D upper limit (>120ng/ml). Near 70% of the 1532 women, with an average of 26.9±12.3ng/ml 25(OH)D, has scarcity in 25(OH)D, of which 58% are insufficient (24.8±3.1ng/ml), 42% are deficient (14.8±3.3ng/ml) of which 11% are severe (≤10ng/ml). Stratification into 5-year age intervals revealed identical incidences of 25(OH)D scarcity in all age groups, with the lowest incidence (67%) in the 25-29 age group and the highest (72%) in the 30-34 age group. Also in the last group there is a higher incidence of insufficiency in 25(OH)D (43%) while the highest incidence of deficiency is observed among 20-24 years-old (32%). Most women do not take vit.D.
Concluding, a large part of the female population at childbearing age has a scarcity of 25(OH)D and does not do any type of supplementation. Thus, health professionals awareness for monitoring 25(OH)D levels and vit.D supplementation during pregnancy and breastfeeding is crucial.
CR02
INFLAMMATORY NECROTIZING MYOPATHY ASSOCIATED WITH ANTI-HMGCR ANTIBODIES - A RARE CAUSE OF MYOPATHY
Luís Albuquerque1, Cátia Iracema Morais2, Ana Campar3, Otília Figueiras2, Tânia Longa2, Esmeralda Neves2
1 Serviço de Patologia Clínica - Hospital de Braga
2 Serviço de Imunologia - Centro Hospitalar Universitário de Santo António
3 Unidade de Imunologia Clínica - Centro Hospitalar Universitário de Santo António
Introduction: IIM are a group of rare diseases that share clinical manifestations of progressive muscle weakness, elevated muscle enzymes and histopathological findings of inflammatory infiltrates in muscle tissue.
IMNM are part of this group and account for 20-30% of the cases, distinguished from other IMM by the presence of muscle fiber necrosis associated with sparse inflammatory infiltrate. There are three subtypes: IMNM with anti-signal recognition particles (anti-SRP) autoantibodies, with anti-HMGCR autoantibodies, and without associated autoantibodies.
Half of the cases of IMNM are idiopathic, while the rest are associated with statin use, neoplasms, HIV infection or connective tissue disease.
Clinical case: We present a case of a female patient, former smoker, with no significant personal history and was not taking any medication. Since 2017, she reports muscle weakness in the lower limbs, with subsequent progression to the upper limbs, with continuous worsening and functional limitation, and also reveals the appearance of painful oral aphthous ulcers.
The objective examination revealed a decrease in proximal muscle strength in both the upper and lower limbs, with slight decrease in rotulian and brachial reflexes bilaterally.
The analytical study showed a marked elevation of total creatine kinase (4622.0 U/L; RV: 24-173 U/L), increase in myoglobin (679 µg/L; RV: 25-58 µg/L) and aldolase (35.4 U/L; RV: 1.2-7.6 U/L). The initial immunological study was negative.
Muscle biopsy was compatible with IMNM.
An inflammatory myopathies panel by immunoblot (EUROLINE Autoimmune Inflammatory Myopathies 16 Ag et cN-1A (IgG), EUROIMMUN) was performed and no autoantibody was detected. Anti-HMGCR antibodies were measured by ELISA (QUANTA® Lite HMGCR ELISA, Inova Diagnostics) and were positive (177.3 U/mL; RV:<20 U/mL). Initiation of treatment with prednisolone and methotrexate led to improvement of muscle complaints.
Conclusion: Although rare, IMNM is a pathology to be considered in the presence of a clinical picture of myopathy. It should be kept in mind that there is not always an association with statin use in anti-HMGCR-associated IIM, and is therefore not a necessary requirement for diagnosis. Recognizing risk factors, identifying the association with autoantibodies (anti-SRP and anti-HMGCR), timely muscle biopsy and aggressive immunotherapy are associated with better patients outcomes.
CR03
I ADRENAL TUMOR WITH A PUZZLING SECRETORY PATTERN
Francisca Marques1, Henrique Reguengo2, José Carlos Oliveira2, Isabel Palma2
1 Hospital Pedro Hispano - Unidade Local de Saúde de Matosinhos
2 Centro Hospitalar Universitário de Santo António
Case report: A previously healthy 49-year-old male presented with a four-month history of abdominal pain, constitutional and paroxysmal symptoms. He had no clinical stigmata and his blood pressure was low-normal. A CT scan showed a 16cm malignant left adrenal mass with abdominal and pulmonary metastasis. Catecholaminergic activity was assessed by LC-MS/MS over two months without drug or dietetic interferences. It revealed persistent normal plasma free metanephrine (MN) and normetanephrine (NMN) in four measurements. Plasma noradrenaline was elevated and adrenaline normal (measured once). In three 24h urine assessments fractionated 3-methoxytyramine was persistently elevated, while elevation of fractionated NMN and MN varied (elevated NMN and normal MN twice; elevated MN and normal NMN once); noradrenaline and dopamine were elevated twice and normal once; adrenaline persisted normal. The remaining laboratory tests documented hypercortisolism with non-suppressed ACTH, elevated 11-deoxycortisol, 21-deoxycortisol, estradiol, DHEA-s and delta-4 androstenedione. Primary hyperaldosteronism was excluded and CrgA was negative. PET/FDG was positive and MIBG scan negative. The patient awaits adrenal biopsy and treatment plan (besides adrenergic blockade).
Discussion: We present a very educational case of a highly aggressive stage IV adrenal malignancy with a rare and intriguing functional pattern. Co-secretion of cortisol, estradiol and steroid precursors indicates adrenocortical carcinoma, while catecholaminergic production suggests pheochromocytoma. Synchronous tumors, mixed corticomedullar tumor or metanephrine-producing adrenocortical carcinoma could explain it, but are exceptionally rare. Another disturbing finding is the discordant plasma and urinary metanephrines levels. We hypothesize that the short half-life of plasma free metanephrines, which can be rapidly conjugated within the tumor and peripheral tissues, could explain it; moreover, the responsible enzymes are possibly overinduced by the active hypercortisolism. We hypothesize that measuring plasma sulfoconjugated metanephrines could help solve this puzzle. Finally, the surprising non-suppressed ACTH may be justified by the subclinical hypercortisolism with rapid onset and local tumoral production of ACTH.
CR04
MYCOBACTERIA ISOLATES FROM A NORTHEN PORTUGAL HOSPITAL CENTER
Olímpia Varela1, Sara Sousa1, Sofia Costa1, Teresa Carvalho2, Ana Fontes1, Eliana Costa1
1 Centro Hospitalar de Trás-os-Montes e Alto Douro
2 Centro Hospitalar Universitário de São João
Background: Mycobacterium tuberculosis Complex (MTBC) is the first cause of death linked to a single pathogen worldwide, having an increasing level of resistance to antibiotics.
Nontuberculous mycobacteria (NTM) are commonly found in patients with structural lung disease and occurs in severely immunocompromised individuals.
The aim of this retrospective study, the first to be carried out in our Hospital Center is to characterize the epidemiology, clinical features, in vitro susceptibility pattern and antimicrobial therapy in mycobacteria isolates.
Casuistry: A total of 4675 mycobacteriological exams (auramine concentrated smear and culture test using the BACTEC™ MGIT™ automated mycobacterial detection system - Becton Dickinson) were performed in our Hospital Center from march 2020 to december 2022.
Drug susceptibility testing was carried out for first-line antituberculous drugs and streptomycin, using the same BACTEC system, when a MTBC strain was detected.
A total of 189 isolations were obtained from 141 patients, 65% male and 35% female and 96 cases occurred over 60 years of age. 55% corresponded to MTBC strains (77 patients), 37% to NTM (53 patients), 6% to Nocardia spp. (8 patients) and 2% presented with both MTBC and NTM (3 patients).
In MTBC strains, 83 isolations were obtained from sputum, 34 from lower respiratory tract and the rest from other various products.
In 60% (n=46) of the MTBC isolates, the concentrated smear was positive. As for the drug susceptibility testing, 3% of strains were resistant to streptomycin and all were suceptible to the first-line drugs tested (rifampicin, ethambutol, isoniazid and pyrazinamid), however in 23 cases (30%) it was not possible to perform due to strain inquination.
In patients with NTM (n=56), Mycobacterium intracellulare was found most often (68%), 11 patients (20%) were under immunosuppression and 20 patients (36%) had structural lung disease.
Discussion: Our Hospital Center has a positivity rate of 4% (n=189) in 4675 tests performed. Resistance to first-line treatment is not yet a problem in our Hospital although streptomycin resistance had already been identified. With regard no NTM, these mostly appeared in patients without structural lung disease or immunosuppression, which is currently not in line with literature.

CR05
RETROSPECTIVE STUDY OF THE SUSCEPTIBILITY OF CAMPYLOBATER JEJUNI/COLI TO ANTIMICROBIALS IN THE LAST 3 YEARS IN A HOSPITAL CENTER
Filipa Gamboa1, Judite Batista1, Elisabete Cristovam1, João Dias1, Cristina Toscano1
1 Centro Hospitalar Lisboa Ocidental
Introduction: Campylobacter spp. is a Gram-negative bacterium being responsible, especially Campylobacter jejuni, for the most frequent cause of acute gastroenteritis in humans in developed countries. Campylobacteriosis mostly manifests itself as inflammatory diarrhea associated with fever and abdominal pain. In most cases it is a self-limiting infection, but serious complications can occur. Symptomatic therapy is the most indicated, being antibiotic therapy reserved for more severe cases.
Description: The present study aims to review the susceptibility of Campylobacter spp. Isolated in the last 3 years in a tertiary Hospital.
This is a descriptive retrospective study based on antimicrobial susceptibility testing results of C. jejuni and C. coli isolates between 01/2019-01/2023. Data was collected from Clinidata XXI software. Strains were identified by mass spectrometry using the VITEK® MS system (BioMérieux) and antimicrobial susceptibility testing was performed by the disc diffusion method according to the European Committee on Antimicrobial Susceptibility Testing (EUCAST).
During the considered period 91 C. jejuni and 4 C. coli were isolated from stool (91) and blood samples (4). Overall, antimicrobial resistance was observed in 93.7% of isolates for Ciprofloxacin, in 70.2% for Tetracycline and only in 9.5% for Macrolides. The resistance profile of the C. coli studied revealed higher resistance rates for all antibiotics tested when compared with C. jejuni (100% vs 93.4% to Quinolones, 100% vs 67% to Tetracycline and 75% vs 6.6% to Macrolides).
Discussion: Studies found that Campylobacter resistance is increasing, particularly resistance to Ciprofloxacin and Tetracycline. In our study, Macrolides proved to be suitable for first line therapy, in contrast to Tetracyclines and Ciprofloxacin that showed higher resistance rates. Treatment of C. coli may pose serious problems due to high resistance rates.
CR06
CHLORIDE IN CEREBROSPINAL FLUID: “IF YOU CANNOT DO GREAT THINGS, DO SMALL THINGS IN A GREAT WAY”
Bruno Esteves1, Anália Carmo2, Gilberto Marques2, Celeste Pontes2, Catarina Chaves2, Fernando Rodrigues2
1 Serviço de Patologia Clínica do Centro Hospitalar Universitário Cova da Beira
2 Serviço de Patologia Clínica do Centro Hospitalar e Universitário de Coimbra
Introduction: Previous studies reported that cerebrospinal fluid (CSF) chloride (Cl) levels were decreased in bacterial meningitis (BM) and were not altered in viral meningitis. These studies also pointed that the reduction was more pronounced in tuberculous meningitis and for this reason it was considered that it could contribute to its diagnosis. However, there were conflicting results determining the loss of its diagnostic value. At a time when there is a wide range of methods for diagnosing meningitis, can the determination of CSF Cl level have diagnostic value?
Objective: To perform a retrospective study to evaluate the contribution of CSF Cl level to the diagnosis of BM.
Methods: It was performed a parameterized and anonymized research using the laboratory software considering the CSF samples collected from January 2018 to December 2022, evaluated for mycobacteria using culture and molecular methods or for other bacteria and virus using the BIOFIRE® FILMARRAY® Meningitis/Encephalitis panel with a simultaneously determination of CSF Cl levels (reference interval: 116-122mmol/L).
Results: Considering the CSF samples evaluated for mycobacteria and Cl: 889 samples were assessed and mycobacteria were identified in four of them. In these samples, the mean value of Cl was significantly reduced (107.3±2.4 mmol/L) as compared to that in the negative samples (122.5±5.1 mmol/L). Regarding the samples analysed using the BIOFIRE® FILMARRAY® that also presented Cl levels, 1032 samples were considered. In 971 samples (Group 1) no microorganism was identified and the mean value of Cl was 122.8±5.2 mmol/L. In 22 samples (Group 2), it was identified a bacteria from the panel and the mean value of Cl was 114.8±5.7 mmol/L. In 39 samples (Group 3), it was identified a virus and the mean value of Cl was 121.3±5.8 mmol/L. The statistical analysis revealed that the results from Group 2 were significantly lower than that from Group 1 (p<0.001) and Group 3 (p<0.001); the results from Group 3 were similar to that in Group 1 (p=0.086). Similar results were obtained when considering the ratio of serum Cl vs CSF Cl.
Conclusion: These results put in evidence that in spite of all complex methods available for diagnosing meningitis the quick determination CSF Cl may be helpful in increasing the sensitivity and specificity in the early diagnosis of BM.
CR07
A 5-YEAR BRIEF CASUISTIC STUDY OF CAMPYLOBACTER SPP. ISOLATES IN A TERTIARY HOSPITAL
Yuliya Volovetska1, Ana Catarina Marques1, Dinah Carvalho1, Pedro Cabral1, L.Marques Lito1, J. Melo Cristino1
1 Clinical Pathology Department, Centro Hospitalar Universitário Lisboa Norte, Lisbon, Portugal
Introduction: Campylobacteriosis is a zoonosis caused by infection with Campylobacter spp., Gram negative rod, spiral-shaped. C. jejuni and C. coli are the most frequently reported species in human disease, especially gastrointestinal infections. Campylobacter infections are generally mild, but can be severe among very young children, elderly and immunocompromised patients.
The authors present a 5-year casuistry of Campylobacter spp. isolates in a tertiary hospital centre, in Lisbon.
Description of the Casuistry: We conducted a retrospective observational study on culture positive results for Campylobacter species obtained from stool and blood samples from 2017 until 2021, isolated on CCDA (Campylobacter Blood-Free Selective Medium - Preston modified) and identified by MALDI-TOF. For the antimicrobial susceptibility testing (AST), EUCAST breakpoints and guidance were used.
We analysed 80 patients (108 Campylobacter spp. isolates) in 2017, 106 (157 Campylobacter spp. isolates) in 2018, 113 (135 Campylobacter spp. isolates) in 2019, 77 (107 Campylobacter spp. isolates) in 2020 and 91 (105 Campylobacter spp. isolates) in 2021. Campylobacter spp. isolates were more frequent in males (61%). Stool samples were the most frequent with positive results (93%, n=612). In each of 5 years, C. jejuni was the most identified species (5-years mean: 80,5%), followed by C. coli (5-years mean: 21.7%). Paediatrics and Immuno-Allergology Departments were the ones with more isolates (415 of 612, 68%). AST showed high resistance to ciprofloxacin (94.6%, n=612) and tetracycline (73.1%, n=612) and lower resistance to erythromycin (23.2%, n=612).
Discussion: The real incidence of gastroenteritis due to Campylobacter spp. is yet poorly known, since many cases are undiagnosed or unreported. In this hospital centre, we were able to isolate at least 3 different species, C. jejuni being the most frequent. We also verify high resistance to ciprofloxacin and tetracycline. Considering this important antibiotic resistance, more research on prevention and therapeutic strategies should be incentivized.
CR08
BACTEREMIA DETECTED ON THE PERIPHERAL BLOOD SMEAR
Eva Molnar1, Ana Rita Oliveira1, David Garcia1
1 Centro Hospitalar Universitário de São João
A sixty-year-old female patient with third-degree burns over the face, thorax and right upper extremity was transferred to the emergency department of our hospital. The lab results on admission showed leukocytosis with neutrophilia, normal C-reactive protein (CRP), elevated lactate dehydrogenase, creatine kinase and myoglobin levels. Bacteriological cultures of the wounds (face, ears, thorax, and right upper extremity) were positive for multi-sensitive Enterobacter cloacae, Staphylococcus aureus and Pseudomonas putida. Antibiotherapy with intravenous gentamycin was initiated, and the patient was transferred to the burn unit with a reserved prognosis.
During the following days, the patient underwent serial surgical debridement and partial thickness graft insertion. The microbiological samples – including blood cultures, bronchial secretions, urine – collected during this period were all negative or non-representative, except for a positive carbapenemase screening test (blaKPC) that was identified on day 6 as Escherichia coli.
On day 22, a routine complete blood count was ordered. The leucocyte count and CRP the level were decreasing (18.16 → 13.24 x 10˄9/L and 232.8 → 195.4 mg/L respectively). The whole blood sample was processed on the haematological analyser Sysmex XN-9100TM. The white blood cell differential was abnormal, so a peripheral blood smear (PBS) was made. The images showed numerous neutrophils with small, round, basophilic inclusions suggesting the presence of bacteria. To confirm this finding, Gram stain slides were prepared directly from the whole blood sample. The presence of gram-positive cocci was confirmed on all slides. Blood cultures were collected and were positive for Streptococcus anginosus and Enterobacter cloacae. Despite the antibiotherapy instituted, the patient developed sepsis and refractory shock, and died on day 28 of admission.
The presence of bacteria on the PBS can be an ominous sign of overwhelming sepsis that needs careful evaluation. If bacteremia is confirmed, antibiotherapy can be promptly initiated. In some cases, the presence of bacteria on the PBS can precede the elevation of the leucocyte count and CRP levels.
CR09
TUBERCULOSIS CHALLENGE – CASE REPORT
Ana Bernadete Cerqueira Aguiar1, Herminia Costa2, Mariana Silva2, Adriana Pedrosa2, Monica Baptista2, Amélia Afonso2, Fatima Silva2, Hugo Loureiro2, Ana Silva2
1 Serviço de Patologia Clínica Centro Hospitalar Entre Douro e Vouga
2 Serviço Patologia Clínica Centro Hospitalar Entre Douro e Vouga
Introduction: Tuberculosis (TB) is a serious public health problem worldwide, caused by Mycobacterium tuberculosis complex. Although the lung is the target organ par excellence, TB has the capacity to reach any organ. Up to 20% of cases have an extra-pulmonary location, with nodal presentation being more frequent.
Case report: Female, 51-year-old, was admitted to the emergency room due to fever and asthenia for 15 days. Without relevant epidemiological context. She denied previous TB and had a history of breast carcinoma, without recurrence.
On physical examination, she was apyretic and hypotensive. Blood tests showed anemia (Hb 9,7 mg/dL) and C-Reactive Protein elevated. Negative serology for hepatitis and HIV.
Thoracic-abdomen-pelvic CT scan revealed multiple necrotic infradiaphragmatic adenopathies requiring characterization.
An aspiration biopsy of the larger adenopathy was performed. The bacteriological examination was negative. Immunophenotyping showed no alterations. Ziehl-Neelson stained smear was positive. Mycobacterium tuberculosis complex DNA was detected by molecular biology.
Her condition progressively deteriorated requiring admission to an Intensive Care Unit due to respiratory failure accompanied by bilateral and diffuse interstitial ground-glass infiltrates.
The bronchoalveolar aspirate revealed acid-fast bacillis on direct examination and the DNA test for Mycobacterium tuberculosis complex was positive.
The diagnosis of pulmonar and limph nodes TB was assumed.
She started quadruple anti-tuberculosis therapy with isoniazid, rifampicin, pyrazinamide and ethambutol. After 11 days due to liver toxicity, pyrazinamide was suspended and the triple regimen was maintained with favorable clinical and radiological evolution.
Discussion: The diagnosis of ganglionic TB is very challenging, due to the non-specificity of symptoms and the mimicry with other pathologies. The case presented highlights this difficulty, demonstrating pertinence of considering this pathology in the differential diagnosis when studying adenopathies, even without previous history or favorable epidemiological context. A multidisciplinary approach, including clinical pathology, pneumology and internal medicine, is mandatory to set up the best diagnostic and therapeutic pathway.
CR10
LEPTOSPIROSIS AND ACUTE PANCREATITIS
Filipa P. Freitas1, Vanda Mota2, Teresa Reis2, Cláudia Janeiro2, Anália do Carmo2, Rui Soares3, Catarina Chaves2
1 Serviço de Patologia Clínica, Instituto Português de Oncologia de Coimbra Francisco Gentil, EPE
2 Serviço de Patologia Clínica, Centro Hospitalar e Universitário de Coimbra, EPE
3 Serviço de Patologia Clínica, Instituto Português de Oncologia de Coimbra Francisco Gentil, EPE | Instituto de Microbiologia da Faculdade de Medicina da Universidade de Coimbra
Introduction: Leptospirosis is caused by spirochetes of the genus Leptospira, and is associated with direct or indirect contact with body fluids or organs of infected animals, especially rodents. It is considered the most common zoonosis in the world affecting mainly kidneys and liver. Leptospirosis may present as two clinical entities: an anicteric leptospirosis, self-limited and an icteric leptospirosis (Weil disease) a severe illness characterized by the triad of jaundice, renal impairment and haemorrhages.
Clinical Case: A 65 years-old male presented to the emergency room (ER) with fever that persisted for 5 days with peak temperature of 39ºC without improvement with paracetamol and ibuprofen. He also reported diarrhoea without blood or mucus with 2 days of evolution, myalgia and “brownish cough”. He denied abdominal pain, vomiting and dysuria. On objective examination, he was hemodynamically stable. Analytically, he presented acute kidney injury (creatinine 3.35 mg/dL), elevation of hepatic parameters (AST 130 U/L, ALT 84 U/L), direct hyperbilirubinemia (11 mg/dL), elevation of pancreatic enzymes (α amylase 1046 U/L, lipase 2528 U/L), and of C-reactive protein (21 mg/dL), normocytic normochromic anaemia (Hb 10 g/dL) and severe thrombocytopenia (platelets 6 x109 /L). Haptoglobin presented a normal result. During the stay in the ER, he presented a hypotensive profile, a mild hypoxemia and jaundice. Abdominal ultrasound and CT showed a mild hepatosplenomegaly, without dilatation of the biliary tract or gallbladder stones. The patient had a rural context with the possibility of exposure to the urine of rats that led to the suspicion of a leptospirosis. Serology tests for the most frequent microorganisms were negative with the exception of the results for Leptospira (IgG 26,3 U/ml and IgM 87,82 U/ml) that were compatible with infection. Leptospira were also detected in urine by polymerase chain reaction. The patient started doxycycline with a significant improvement.
Discussion: Our patient presented two features of the Weil disease (jaundice and acute renal failure) and acute pancreatitis that is considered a rare complication of leptospirosis. This case report emphasizes the importance of identification of acute pancreatitis as a common complication of Leptospirosis, in order to reduce mortality and morbidity.
CR11
COVID-19: RAPID ANTIGEN TESTS AS INFECTIOUSNESS MARKER
Marco P. B. Pinto1, J. Melo Cristino1
1 Centro Hospitalar Universitário Lisboa Norte, EPE
Introduction: One of the objectives of SARS-CoV-2 testing is to identify people who are transmitting the virus. The high sensitivity of the “gold standard” method for detection of SARS-CoV-2 (Real-Time Reverse Transcription - Polymerase Chain Reaction (RT-PCR)), can be a pitfall because it can detect noninfectious virus particles and can remain positive for a prolonged period of time (even for months).
Previous studies documented no recovery of infectious SARS-CoV-2 virus from specimens that produced cT (cycle threshold) values higher than 30. Others studies showed that people with cT above 33–34 are not infectious and can be discharged from hospital care or confinement.
Rapid Antigen Tests (RATs) have a higher positive predictive value (90%) than RT-PCR (70%) when compared to culture positive results, they can give quick results and can be used massively by trained non-laboratory health care personnel as point-of-care tests (POCTs).
Abbott PanbioTM COVID-19 Ag Rapid Tests (from now on called “Panbio”) is an immunochromatographic SARS-CoV-2 rapid antigen tests which detect the SARS-CoV-2 nucleocapsid protein.
GeneFinderTM COVID-19 RealAmp Kit (from now on “Genefinder”) is a RT-PCR assay for the qualitative detection of SARS-CoV-2 nucleic acids, that targets the N, RdRp and E genes.
Aim: A comparison between “Panbio” positive tests and RT-PCR results (i.e., positive/negative and cT values) was performed using the “Genefinder” kit to assess if a positive RAT test is indicative of risk of infectiousness.
Materials and Methods: Retrospectively (November 2021 to June 2022) the results of RT-PCR (“Genfinder”) performed in the QuantGene Bioer thermal cycler of all positive “Panbio” tests were analyzed.
Results: The sixty positive “Panbio” tests obtained between November 2011 and June 2022, were positive in RT-PCR (“Genefinder”).
In the sixty positive RT-PCR the cT (mean±standard deviation) for each gene was respectively: E (20.53±3.78), RdRp (22.15±3.25), N (19.42±3.53).
Conclusion: A positive “Panbio” test result is highly indicative of risk of infectiousness, since all the cT (RT-PCR) results of the sixty analyzed samples were below 34. More sample data should be analyzed to reinforce this conclusion.
CR12
ROSEOMONAS BACTEREMIA: A RARE REPORT
Ana Bernadete Cerqueira Aguiar1, Amélia Afonso2, Mariana Silva2, Fatima Silva3, Adriana Pedrosa2, Arménia Santos2, Herminia Costa2, Hugo Loureiro2, Ana Silva2
1 Serviço de Patologia Clínica Centro Hospitalar Entre Douro e Vouga
2 Serviço Patologia Clínica Centro Hospitalar Entre Douro e Vouga
3 Serviço de Patologia Clínica Unidade Local Saúde Nordeste
Introduction: Roseomonas spp. is an opportunistic agent, with low pathogenic potential for humans, but some species may cause clinically significant or even fatal disease. Published cases have described catheter-related bacteremia with immunosuppression, bacteremia during chemotherapy, and peritonitis during peritoneal dialysis. However, infection in immunocompetent individuals has also been reported.
The genus Roseomonas includes pink-pigmented gram-negative bacteria, slow growing in cultures, taking up to 5 days to identify. It is rarely isolated in clinical laboratories.
Case presentation: A 66-year-old Caucasian woman went to the emergency department with history of suprapubic pain with three days of evolution associated with vomiting. No other symptoms were noted.
Her past medical history highlighted a neoplasm of the uterine cervix submitted to radiotherapy and recurrent urinary infections due to nephrolithiasis that led to left nephrectomy. Hydronephrosis of the right ureter, radiotherapy sequela, with percutaneous nephrostomy of a single kidney.
She was apyretic and hemodynamically stable and physical examination showed a depressive but painful abdomen. The rest of the examination was unremarkable.
Blood tests showed leukocytosis (WBC 13,4x109/L) with neutrophilia, normochromic normocytic anaemia (HB 10,4g/L). Creatinine of 1,9 mg/dL and C-reactive protein of 318,5mg/L.
Urinalysis revealed proteinuria (300mg/dL) with leukocytes (500/µL) and erythrocytes (200/µL).
Renovesical ultrasound with increased echogenicity of the renal parenchyma.
Aerobic blood cultures were positive after 50 hours and culture on blood and chocolate agar plate grew slowly mucoid pink coloured colonies. The catalase reaction was positive. Finally, identification by using the API system, revealed Roseomonas spp.
The patient started intravenous ceftriaxone, with a clinical response, and was later transferred to a tertiary hospital nephrology service.
Discussion: Authors alert for the rarity of Roseomonas bacteremia and identification relevance of this colonies and their fastidious growth, as essential for the high suspicion of positive cultures.
The diagnosis of Roseomonas blood infection must be established as soon as possible in order to prevent possible complications.
CR13
DIAGNOSIS IN INFECTIONS DISEASES- THE PERIPHERAL BLOOD IMAGING AID
Eliana Cajigas Silva1, Gouveia Pereira1, Vitória Cabral1
1 CHULC
Introduction: The imaging information offered by the observation of the peripheral blood smears (PBS), is very importante in several areas, not only in Hematology but also in many others, both in terms of diagnosis and therapeutic monitoring.
The blood count is a first-line analysis in the study of a patient with suspected infectious disease, not only the quantitative changes but also the morphological ones, including the search for parasites, is of a great importance.
Objective: To convey the importance of careful observation of the PBS in certain infectious clinical situations
Material and methods: A review of clinical cases in which imaging proved decisive for diagnosis in infectious diseases.
Results: 5 clinical situations were selected and ilustrated:
1: Male 54 years. Febrile, unconscious on admission to the emergency room. PBS revealed intra (neutrophil) and extracelular gram positive diplococci, which was identified as pneumococci.
2: Male 49 years with drepanocytosis. Recurred to the emergency room for fever after arrival from Africa where he was on transfusion support. PBS revealed P. falciparum, 5% parasitized erythrocytes.
3: Male 53 years. Inaugural HIV/AIDS, pneumocystosis. PBS revealed Leishmania donovanni.
4: Female, 2 years. Fever since 1 week. Altered liver function tests. Negative mononucleosis rapid test. BPS: Kissing cells. Subsequently Ac. Anti CMV positive.
5: Female, 34 years. Couhg and fever. 1st COVID test negative, 2 COVID test positive. BPS: Neutrophils with dysmorphism (Pelguer-Huet like; ringe dor fern-like nucleus and cytoplasmic degranulation)
Conclusion: In infectious diseases, along with knowledge of the clinical history, observation of the BPS is very important tool in several situations, providing help im diagnosing emergency cases and prolonged febrile situations.
CR14
CASE REPORT: INVASIVE NON TYPE B HAEMOPHILUS INFLUENZAE IN IMMUNOCOMPROMISED
Sara Ribas Moura1, Antónia Read2, Valquíria Alves2
1 Unidade Local de Saúde de Matosinhos / Hospital Distrital de Santarém, EPE
2 Unidade Local de Saúde de Matosinhos, EPE
Introduction: Haemophilus influenzae (H. influenzae) is a Gram-negative, pleomorphic coccobacillus, that requires factor X and V for growth. Have a polysaccharide capsule and can be serotyped into 6 types (a-f). Due to the severity of type b infections, the vaccine was implemented, reducing the number of cases of type B and bacteremia.
The resistance of these bacteria to β-lactam antibiotics has increased; develops via two mechanisms: β-lactamase production, a change in the penicillin-binding proteins (PBPs), or both.
We present a rare case of pneumonia with bacteremia in a hemato-oncology patient from the community.
Clinical Case: A 74-year-old man with a medical history of newly diagnosed multiple myeloma and penicillin allergy.
Patient reports a productive cough progressively worsening, starting two days ago, associated with chest pain that worsens with deep inspiration and coughing. No fever.
Laboratory findings revealed anemia (Hb 8.9g/dL) without leukocytosis, CRP of 400mg/L and ProBNP 6294pg/mL.
The chest radiograph showed a hypotransparency at the left lung base.
Streptococcus pneumoniae and Legionella pneumophila urinary antigen test were negatives.
Blood culture was positive for H. influenzae. Agglutination typing with antisera revealed a strain of H. influenzae not b.
B-lactamases research was negative.
The antimicrobial susceptibility testing (AST) with disk diffusion test was resistant to penicillin (screen test) and ampicillin, susceptible to amoxicillin-clavulanic acid, ciprofloxacin, trimethoprim-sulfamethoxazole, ceftriaxone and cefotaxime.
Since it is β-lactamase-non-producing strains; sensitivity to amoxacillin and amoxicillin-clavulanic acid was confirmed with gradient test, being seusceptible.
Sputum bacteriology also identified H. influenzae not b, with AST equal to blood culture.
The patient received targeted antibiotic therapy with subsequent clinical improvement.
Discussion: H. influenzae is still responsible for community-acquired respiratory tract infections and invasive diseases such as bacteremia and meningitis.
This case highlights the importance of chocolate agar in blood cultures, favoring the growth and subsequent identification of demanding microorganisms that are difficult to visualize in Gram stain.
In β-lactamase negative strains, the mechanism of resistance is PBP3 mutations.
CR15
A SIMPLE AND INEXPENSIVE METHOD TO CONFIRM A LEISHMANIA SPP INFECTION IN A BONE MARROW ASPIRATE
Marco P. B. Pinto 1
1 Centro Hospitalar Universitário Lisboa Norte, EPE
Introduction: Visceral leishmaniasis is a disseminated protozoan infection caused by Leishmania donovani complex.
The gold standard for diagnosis relies on the observation of the amastigote form of the parasite within macrophages by microscopic examination of tissue aspirates (e.g. bone marrow). But the diagnosis of Leishmania spp infection in bone marrow aspirates is sometimes difficult because some morphological features of amastigotes cannot be observed (e.g. kinetoplast) and other differential diagnosis must to be considered. In these cases, more expensive diagnostic methods could be used to reach the final diagnosis, such as Polymerase Chain Reaction (PCR).
Aim: This work aims to present a simple and inexpensive method to confirm Leishmania spp infection in a bone marrow aspirate.
Materials and Methods: As previously described by Barros Pinto et al (Br J Haematol. (2020)), a bone marrow aspirate sample was left at room temperature since collection and a bone marrow film was made daily. Bone marrow films were stained with May-Grünwald Giemsa stain.
Conclusions: On the third day, amastigotes developed into different promastigote forms, confirming the diagnosis of Leishmania spp infection. Costs related to this method included the staining procedure and the microscope slides.
CR16
COVID-19 VACCINATION AND ATYPICAL HEMOLYTIC UREMIC SYNDROME. A CASE STUDY
Luís Afonso1, Luís Morais1, Rui Figueiredo1, Carlos Cortes1
1 Centro Hospitalar do Médio Tejo
Introduction: Hemolytic uremic syndrome (HUS) is a clinical syndrome characterized by microangiopathic hemolytic anemia, thrombocytopenia, and acute renal failure. However, atypical cases (aHUS) without preceding diarrhea also occur.
Case description: We present a patient who developed atypic hemolytic uremic syndrome in native kidneys, 8 days after adenoviral (AstraZeneca, ChAdOx1 nCoV-19) COVID-19 vaccination. This patient, a middle-aged woman, on admission, present a serum creatinine of 3.8 mg/dL, a platelet count of 23 g/L, a haemoglobin of 9.2 g/dL, a lactate dehydrogenase of 4380 U/L, and schistocytes were detectable on peripheral blood smear. She had a novel subgroup of aHUS characterized by a genetic homozygous deletion of CFHR1/CFHR3, after Covid-19 vaccination.
In the present case study, plasma complement profiles were measured and genetic analysis of the CFH, CD46 (MOPC), CFI, C3, THBD, CFB, CFHR5, CFHR1, CFHR3, CFHR4, DGKE+ADAMTS13 genes were performed with a Next-Generation Sequencing panel (NGS) of 12 genes in a female patient diagnosed with aHUS.
The patient revealed plasma CFHR1 deficiency and homozygous genomic deletion of CFHR1/CFHR3 associated with anti-CFH.
Discussion and conclusion: Although genetic defect of complement factor H (CFH) is a common cause of atypical hemolytic uremic syndrome (aHUS), development of autoantibodies to CFH (CFH-Ab) is also known to be an acquired cause of aHUS.
Recently, a correlation between the development of CFH-Ab and the deficiency of the CFH-related proteins, CFHR1 and CFHR3, was identified.
The patient was treated with plasmapheresis, application of fresh plasma concentrate in dialysis sessions, required additional immunosuppressive therapy, and the introduction of the complement C5-inhibitor eculizumab.
In conclusion, aHUS should be included in the differential diagnosis of patients with vaccine-induced thrombocytopenia, with mechanical hemolytic anemia and acute renal failure. Screening for CFH-Ab and the CFHR1/CFHR3 deficiency should be included in the diagnostic tests for patients with aHUS.
As the risk of aHUS recurrence after COVID-19 vaccination appears to be acceptable, we advise continuation of COVID-19 vaccination in aHUS patients, as this evidently reduces the risk of severe COVID-19 infection.
| SPML POSTER AWARD SESSION
P01
LEUKOERYTHROBLASTOSIS IN SICKLE CELL DISEASE: THINK OF PARVOVIRUS B19 INFECTION!
António Figueiredo1, Teresa Ferreira2, Filipa Salazar1, Alexandra Santos1, Lucinda Silva1, Luísa Sancho1
1 Serviço de Patologia Clínica, Hospital Prof. Doutor Fernando Fonseca E.P.E.
2 Serviço de Pediatria, Hospital Prof. Doutor Fernando Fonseca E.P.E.
Introduction: Leukoerythroblastosis is a rare condition, particularly in pediatric ages, characterized by leukocytosis and the presence of myeloid and erythroid precursors in the peripheral blood. Few cases of Parvovirus B19 (PB19)-associated leukoerythroblastosis have been reported. In a setting of Sickle Cell Disease (SCD), PB19 infection can cause transient aplastic crisis which can be life-threatening. However, leukocytosis and thrombocytosis are rarely seen.
Case presentation: A 27-months-old girl with HbSS presents to the emergency department due to intermittent fever in the last week, associated with cough, vomiting and progressive sick feeling. Of note, SCD was diagnosed at 11 months in a setting of dactylitis. On physical examination she was prostrated and mildly dehydrated; no splenomegaly noticed. CBC showed a WBC of 92,300 × 109/L (36%N, 42%L), hemoglobin 3,3 g/dL (baseline 7,5 g/dL), platelets 607 × 109/L, and 113 NRBCs/100 WBCs; reticulocyte count was 11,000/ul which raised the suspicion of PB19 infection. Morphologic examination of the peripheral blood showed a marked leukoerythroblastosis, rare myeloblasts (<2%), abundant NRBCs, and thrombocytosis; CRP 1,49 mg/dl. The patient was transfused with packed RBC, received intravenous hydration and ceftriaxone. Within 48 hours her reticulocyte count rose to 391,000/ul (652,000/ul at 72h) and 325 NRBCs/100 WBC; the WBC had fallen to 19,500, the platelets to 419,000. Two weeks later her CBC had normalized; PB19 IgM was positive (index 24, rf >=1.1), as well as IgG (>48).
Discussion: The child described presented with blood counts concerning for a MPN but was ultimately diagnosed with transient leukoerythroblastosis. This case is unique in the sense that it describes the unusual association between leukoerythroblastosis and thrombocytosis, in conjunction with transient aplastic crisis secondary to parvovirus B19 infection. Moreover, it documents perfectly the reticulocyte/erythroblastosis response in the timeline of a PB19 infection, specifically in the setting of SCD. Our patient’s presentation suggests that PB19 serology should be considered in the workup of children who present with leukoerythroblastosis and that watchful waiting might be a wise initial approach.
P02
EXCLUDING SERIOUS CAUSES OF THROMBOCYTOPENIA: A CASE REPORT OF HEPARINE-INDUCED THROMBOCYTOPENIA
Tânia Cardoso1, João Pego1, Anália Carmo1, Cesar Pereira1, Rita Vicente1, Fernando Rodrigues1
1 Centro Hospitalar e Universitário de Coimbra
Introduction: Heparin-induced thrombocytopenia (HIT) is a rare potentially fatal form of drug-induced immune-mediated disease. In patients receiving heparin for thrombosis prevention or treatment, antibodies against the heparin-PF4 complex are generated, leading to platelet activation and aggregation. Thrombocytopenia is induced and a state of hypercoagulability is promoted, which can lead to thrombosis.
The diagnosis is based on clinical assessment based on the use of 4Ts score and laboratory determination of anti-PF4 antibodies (AFP4). There is limited data on the epidemiology of HIT in cancer patients due to its associated complications. Studies refer that the frequency of HIT is higher after surgeries. The authors present a case of HIT after a oncological orthopaedic surgery.
Case report: A 66-year-old man was admitted to the Orthopaedic Unit for resection of a single metastasis of prostatic adenocarcinoma in the left femur. The patient had history of urinary incontinence secondary to radical prostatectomy, hypertension and dyslipidaemia. At the admission, no significant alterations were detected on the blood tests. There was no previous history of HIT.
The patient was submitted to an extended resection of metastasis and to a reconstruction with megaprosthesis of the left femur without complications. Postoperatively, the patient was maintained on enoxaparin, 40mg. Despite the hemodynamic stability, nine days after the surgery, laboratory tests revealed a significant thrombocytopenia (a fall of 71% in platelet count) that raised the suspicion of intravascular disseminated coagulation. This suspicion was not confirmed. As platelets continued to decrease, the hypothesis of HIT was raised. The 4T score was 5 points, indicating an intermediate probability (∼14%) of HIT. AFP4 showed a positive result. Enoxaparin was interrupted and alternative anticoagulation was initiated.
Discussion: Diagnosis of HIT in the postoperative setting of oncological orthopaedic surgery is difficult since these patients usually present multiple possible causes for thrombocytopenia. The use of 4T score and AFP4 is important to establish the diagnosis of HIT. In this case is crucial to interrupt enoxaparin and to initiate an alternative anticoagulation.
P03
MYELODYSPLASTIC/MYELOPROLIFERATIVE NEOPLASMS WITH RING SIDEROBLASTS AND THROMBOCYTOSIS (MDS/MPN-RS-T): BORDERLINE CASES WITHOUT ANEMIA
António Figueiredo1, Máriam Calú2, Carlos Severino2, Rui Barreira2
1 Serviço de Patologia Clínica, Hospital Prof. Doutor Fernando Fonseca E.P.E.
2 Laboratório de Hematologia, Serviço de Patologia Clínica, Instituto Português de Oncologia de Lisboa Francisco Gentil E.P.E.
Introduction: MDS/MPN-RS-T diagnostic criteria (WHO 2016 classification) include persistent thrombocytosis (>450 × 109/L), anaemia, dyserythropoiesis with ring sideroblasts (RS), and SF3B1 mutation (in its absence, there must be no history of recent cytotoxic or growth factor therapy). Borderline cases without anemia albeit very rare exist, and the absence of anaemia in the presence of disease-specific major criteria should not exclude the diagnosis of MDS/MPN-RS-T.
We describe three such cases with a presumptive diagnosis of MDS/MPN-RS-T but without anaemia.
Cases description. Case 1: an 71-year-old woman, with Hgb 172 g/L 590 x109/L platelets, EPO 1.8 mU/ml (4.3 – 29.0) and positive JAK2V617F mutation. The bone marrow aspirate was hypercellular, with dyserythropoiesis including RS 15%, megakaryocytes in high numbers with accentuated pleomorphism. Karyotype 46,XX. Awaits SF3B1. Case 2: an 65-year-old man with marked thrombocytosis (894 x 109/L)M Hgb 151 g/L ; Hgb 151 g/L; EPO 11.2 mUI/ml, JAK2V617F mutation positive. Bone marrow evaluation evidencing hypercellularity, dyserythropoiesis with RS 36% and augmented megakaryocytes with marked pleomorphism. Karyotype 46,XY. SF3B1 ongoing. Case 3:an 81-year-old man, presented with thrombocytosis (820 x 109/L); Hgb 146 g/L; EPO <1mUI/ml and JAK2V617F mutation positive. Bone marrow evaluation showed a hypercellular marrow with dyserythropoiesis with RS 18%, clustering of atypical (hyperlobated) megakaryocytes. Karyotype 46,XY, inv(9). SF3B1 ongoing.
Discussion: We describe three borderline cases of MDS/MPN-RS-T without anemia but otherwise showing all the other features (cytomorphologic, cytogenetic, and molecular) typical of this entity. These may represent a more benign spectrum of the disorder, (before overt anaemia occurs), supporting the fact that anaemia may not be necessary for the diagnosis of MDS/MPN-RS-T and simultaneously highlight the need to perform a Perls´ Prussian blue stain whenever the entity is suspected albeit anaemia might be absent.
P04
SICKLE CELL ANEMIA: ASSESSMENT OF FETAL HEMOGLOBIN IN A GROUP OF ANGOLAN CHILDREN BEFORE AND AFTER TREATMENT WITH HYDROXYUREA
Priscilla Almeida1, Alcina Costa2, Cristina Vieira2, Filomena Seuane2, Raquel Romão2, Miguel Brito3, Isabel Moreira da Silva4, Armandina Miranda2
1 Faculty of Pharmacy, University of Lisbon, Portugal
2 Department of Health Promotion and NCD Prevention, National Institute of Health Doutor Ricardo Jorge, Lisbon, Portugal
3 3H&TRC - Health & Technology Research Center, ESTeSL - Higher School of Health Technology, Polytechnic Institute of Lisbon, Portugal; Angola Health Research Center (CISA), Caxito, Angola
4 Faculty of Pharmacy, University of Lisbon, Portugal; Department of Pharmaceutical and Medicine Sciences. Research Institute for Medicines (iMed.ULisboa), Portugal
Introduction: Sickle cell anemia (SCA) is an autosomal recessive hereditary disease characterized by the presence of the hemoglobin S (HbS) allele in homozygosity, being among the most common genetic diseases. Its clinical phenotype is heterogeneous, being modulated by several factors, highlighting the level of fetal hemoglobin (HbF) expression. Increased HbF levels are associated with smoother disease progression and fewer clinical complications. Hydroxyurea (HU) is an antineoplastic agent whose biological effects include increasing HbF. It has been used in the treatment of SCA.
Aim: The aim of this work was to analyze the levels of HbF, before and after 6 and 12 months of treatment with HU, in the studied population, to evaluate the efficacy of the drug.
Methodology: The study was carried out with 36 Angolan children with SCA from Hospital Pediátrico David Bernardino and Centro de Investigação em Saúde de Angola (CISA)- Hospital Geral do Bengo, 19 female and 17 male, whose average age was 7 years. The HbF level was quantified by ion exchange liquid chromatography before and after 6 and 12 months of treatment with HU. Tests were performed using IBM SPSS 20.0 and Jamovi software. To assess the normality of data distribution, the Kolmogorov-Smirnov and Shapiro-Wilk tests were performed. The results were evaluated by Student’s t test, Independent t test, Wilcoxon test and Mann-Whitney test. The significance level considered in the study was p<0.05.
Results: The mean HbF in the 36 children was 6.3% pre-treatment, 14.7% after 6 months and 12.9% after 12 months of treatment. HbF levels after 6 months of treatment doubled in 47.2% % of patients. About 50% of patients acquired an HbF level between 10% and 20% and 22.2% of patients obtained HbF levels ≥20%. The results showed that HU was effective in raising HbF levels after 6 months of treatment. After 12 months of treatment there was a stabilization or a slight decrease in HbF levels. No statistically significant differences were found in the increase in HbF level after HU treatment between genders and age groups.
Conclusion: HU was an effective drug in raising HbF levels in the first 6 months of treatment and, therefore, can contribute positively to the treatment of SCA in the studied population, since HbF is one of the main modulators of disease severity.
P05
TWO YEARS OF PIMS-TS AT CENTRO HOSPITALAR UNIVERSITÁRIO DE SÃO JOÃO
Teresa Almeida1, Rita Oliveira1, Angélica Ramos2, João Tiago Guimarães3, Maria João Cardoso1, Sandra Rebelo4
1 Serviço de Patologia Clínica, Centro Hospitalar Universitário de São João, Porto, Portugal
2 Serviço de Patologia Clínica, Centro Hospitalar Universitário de São João, Porto, Portugal. EPIUnit – Instituto de Saúde Pública, Universidade do Porto, Portugal. Laboratório para a Investigação Integrativa e Translacional em Saúde Populacional (ITR), Universidade do Porto, Portugal
3 Serviço de Patologia Clínica, Centro Hospitalar Universitário de São João, Porto, Portugal. EPIUnit – Instituto de Saúde Pública, Universidade do Porto, Portugal. Laboratório para a Investigação Integrativa e Translacional em Saúde Populacional (ITR), Universidade do Porto, Portugal. Departamento de Biomedicina, Faculdade de Medicina da Universidade do Porto, Portugal
4 Serviço de Patologia Clínica, Centro Hospitalar Universitário de São João, Porto, Portugal. Departamento de Biomedicina, Faculdade de Medicina da Universidade do Porto, Portugal. Instituto de Investigação e Inovação em Saúde, i3S, Porto, Portugal.
Introduction: Among children, coronavirus disease 2019 (COVID-19) is milder than in adults, or asymptomatic. However, in rare cases, a severe hyperinflammatory response termed Pediatric Inflammatory Multisystem Syndrome Temporally Associated with SARS-CoV-2 (PIMS-TS) develops, and can progress to hypotensive shock, myocardial dysfunction, and multisystem organ failure. According to WHO and CDC criteria, PIMS-TS is characterized by persistent fever, laboratory evidence of inflammation and multisystem (>2) organ involvement, and evidence of SARS-CoV-2 infection.
Objective: Characterization of PIMS-TS cases identified from March 1, 2020 to March 23, 2022.
Methods: 2-year observational retrospective analysis of children (0-18 years) admitted to the hospital and tested for SARS-CoV-2, by molecular (RT-qPCR), antigenic or serological tests (anti-RBD, S1, S2, N antibodies). Data was collected from hospital records: SClinicoV2, Alert, jONE and ClinidataXXI.
Results: A total of 43085 children were submitted to a SARS-CoV-2 test, and 1283 (3,0%) had a positive result. Twenty-two children had a diagnosis of PIMS-TS, 21 were SARS-CoV-2 positive (1,8%), and 1 was diagnosed by epidemiological link, with negative SARS-CoV-2 test. Two children were transferred from the hospital, and excluded from the study. Thus, the 20 children with PIMS-TS diagnosis included had evidence of SARS-Cov-2 infection from RT-qPCR (4), serology (3) or both (12), or epidemiological link (1). 13 were male (62%), and the average age was 8 yo. All children had fever at admission, and involvement of at least two organ systems. All children had three or more laboratory biomarkers of inflammation, and those with cardiovascular involvement all had elevated troponin and pro-BNP levels. Nine patients were admitted in intensive care unit, 3 received invasive mechanical ventilation, none received extracorporeal membrane oxygenation (ECMO) support and no fatal outcome was observed. The median length of hospitalization was 13 days. All patients were treated with intravenous immune globulin (IVIG), systemic glucocorticoids and acetylsalicylic acid.
Conclusion: Although rare, PIMS-TS occurs in about 1% of children with SARS-CoV-2 infection, with multisystemic involvement, evidence of inflammation and heart damage.
P06
DETERMINATION OF FOSFOMYCIN SUSCEPTIBILITY USING AN AUTOMATED SYSTEM AND THE DISK DIFFUSION METHOD
Ana Catarina Faria Guerreiro1, João Lago1, Gizela Santos1
1 Laboratório análises clínicas Dr J Leitão Santos
Introduction: Fosfomycin trometamol is a bactericidal antibacterial agent derived from phosphonic acid that inhibits bacterial cell wall formation by interfering with peptidoglycan synthesis. It has excellent activity against Escherichia coli (E.coli), including extended-spectrum beta-lactamases (ESBL) producing strains isolated from patients with urinary tract infections (UTIs). The AST-N355 card of the Vitek 2 system is a usual method to determine fosfomycin susceptibility to E.coli, with breakpoints of S ≤ 16 and R > 16 mg/L. In 2021, the European Committee on Antimicrobial Susceptibility Testing (EUCAST) defined a minimum inhibitory concentration (MIC) breakpoint for oral fosfomycin in E.coli of S ≤ 8 and R > 8 mg/L, which raised some concerns about the interpretation of fosfomycin susceptibility using the Vitek 2 AST-N355 card.
Objective: To compare the two methods of determining fosfomycin susceptibility (VITEK 2 AST-N355 card and disc diffusion method) to assess whether results using the VITEK-2 system remain adequate for routine use without the need to be verified by another method.
Methods: A retrospective study (6 months) was performed with E.coli strains isolated from urine samples of community patients (n=336). The susceptibility of the strains to fosfomycin was determined by the VITEK 2 Compact automated method using the AST-N355 card and by the disc diffusion method (R < 24, S ≥ 24 mm), according to the EUCAST recommendations.
Results: Of 336 patients, 297 (88.4%) were female, and 39 (11.6%) were male. Eleven patients (3.3%) were pregnant. Of the 336 E.coli strains tested, 7.4% were BLSE producers. 99.1% (n=333) showed a good correlation between the two methods. Discordant results were obtained in 0.9% (n=3).
Conclusions: Despite the limitation of VITEK 2 to present breakpoints with MIC higher than those recommended by EUCAST, these results show evidence that the VITEK 2 AST-N355 card is an acceptable method for routine use to determine the susceptibility of E.coli to fosfomycin.
P08
SIX YEARS OF CARBAPENEMASE POSITIVE CITROBACTER FREUNDII, IDENTIFIED IN CARRIER SCREENING TESTING, IN AN HOSPITAL FROM THE NORTH OF PORTUGAL
Fernanda Brites1, Dolores Pinheiro1
1 CHUSJ
Introduction: Carbapenem-resistant Enterobacterales (CRE) infections are a very serious public health problem. To prevent microorganism dissemination into hospitals, a fecal screening test is performed whenever a patient is admitted.
In our hospital, the procedure is done since 2016. The most common isolated strain is Klebsiella pneumoniae KPC positive, among others. Here, it’s reported, the identification of carbapenemase positive Citrobacter freundii strains between 2016 and 2021.
Material and methods: Two swabs were collected for fecal screening test. One was used for the detection of KPC, VIM, OXA-48, NDM and IMP carbapenem’s genes employing the Genexpert® system (Biomerieux®). When positivity was detected, the other swab was cultured on MacConkey agar medium and CromoID medium. All strains growing on both media were tested by immunochromatography (Resist 5, Coris®); positive strains were further identified on Vitek MS Prime or on Vitek 2 and their antimicrobial susceptibility test were made on Vitek 2. In these six years, three Citobacter freundii KPC positive and two Citobacter freundii VIM positive were identified.
Discussion: From all over the world, CRE presence is well documented in literature, being Klebsiella pneumoniae KPC positive the commonest strain. They pose important problems to patient treatment, as antimicrobial options are few.
Citobacter freundii carbapenemase positive reports are fewer 1˙2. They can cause invasive infections, particularly in immunocompromised patients, and can act as a reservoir of relevant carbapenemase resistance genes³. This emphasises the importance to test all strains present in culture.
1. Infect Drug Resist. 2019; 12:3935-3942. Fecal Carriage and Epidemiology of Carbapenem-Resistant Enterobacteriaceae Among Hospitalized Patients in a University Hospital. Liu Q, Liu L, et al.
2. Jpn J Infect Dis. 2020; 73(6):431-436. Prevalence and Characteristics of Carbapenemase-Producing Enterobacteriaceae in Three Tertiary-Care Korean University Hospitals between 2017 and 2018. Kim SH, Kim GR, et al.
3. J Antimicrob Chemother. 2021; 76(10):2697-2701. Three clusters of carbapenemase-producing Citrobacter freundii in Finland, 2016-20. Räisänen K, Sarvikivi E et al.
P09
THE VALUE OF KAPPA INDEX AS A SCREENING METHOD FOR REFLEX OLIGOCLONAL BAND DETERMINATION
Dulce Alves Martins1, Joana Lopes2, Ivete Lima1, Esmeralda Neves1
1 Serviço de Imunologia, Centro Hospitalar Universitário de Santo António
2 Serviço de Neurologia, Centro Hospitalar Universitário de Santo António
Introduction: Kappa free light chains (KFLC) in cerebrospinal fluid have been extensively explored for their ability to reflect intrathecal chronic inflammation in multiple sclerosis (MS) and the next revision of MS diagnostic criteria is likely to consider their utility. Fast and metric KFLC results provided by automated analytical methods support their widespread use in clinical laboratories, which could help overcome technical difficulties and result interpretation in oligoclonal band (OCB) detection. Several KFLC based parameters have been explored and among them K index has shown comparable diagnostic performance to OCB. Previously, we demonstrated slightly higher sensitivity for K index (cut-off 7.25) than for OCB (85% vs. 77%). Its use as a screening test in clinical practice could greatly reduce the sample load where OCB determination is required. We suggested a 2.55 screening cut-off level for reflex OCB determination would lead to significant improvements in turnaround time and use of human resources in the laboratory.
Objective: Our objective was to ascertain the value of K index as a screening step for reflex OCB analysis in a real-world setting.
Materials and Methods: K index was assessed in adults with a first OCB test ordered at our hospital (N, 104) from August 2022 to February 2023. We determined the degree of agreement between both methodologies in samples with K index below the 2.55 screening cut-off, estimated the decrease in OCB determinations and compared workload involved in both methods.
Results: Our study showed 98.5% of samples with K index below the screening cut-off were negative for OCB determination. A 62.5% decrease in OCB tests would be attained with a concurrent estimated 91.5% reduction in workload for samples with no OCB determination required. A higher proportion of OCB positive samples was associated with increasing K index results.
Conclusions: K index is an effective strategy to screen for negative OCB samples. In our hospital a decrease in OCB testing to almost a third could be achieved and the 2.55 cut-off previously determined seemed suitable in a real-world clinical context. This reflex approach would decrease laboratory workload and improve turnaround times, hence, it should be considered in the diagnostic work-up of MS.
P10
EVALUATING THE INTRAINDIVIDUAL BIOLOGICAL VARIATION OF A HOSPITAL CENTER POPULATION TO DEFINE TRIGLYCERIDES MAXIMUM ALLOWABLE UNCERTAINTY
Jorge Pinheiro1, Alvim A.2, Anastácio M.;2, Costa N.,2, Cardeira S.,2, Camara A.,2, Carpalhoso B.,2, Carriço A.,2, Carvalho A.,2, Constantino F.,2, Cunha R.,2, Ervilha C.,2, Ferreira F.,2, Figueiredo M.,2, Galvão S.,2, Gaspar N.,2, Gomes D.,2, Lopes C.,2, Louro N.,2, Marrão G.2, Mendes S:,2, Menezes M.,2, Morgado D.,2, Oliveira A.,2, Pedrosa J.,2, Pinto V.,2, Pires L.,2, Roda S.,2, Santos L.,2, Santos M.,2, Silva A.,2, Silva C.,2, Silva F.,2, Simões Isabel,2, Simoes Inês,2, Vieira L.,2, Vieira M.,2, Vieira R.,2, Ostapenko N.,2, Castro Ricardo2
1 Centro Hospitalar de Leiria EPE (CHL)
2 CHL
Introduction: Biological variation is widely studied has a reference for analytical performance specification to clinical laboratories.
New data from the European Biological Variation Database (EFLMBV) (1), reveals that within-subject biological variation (CVi) for triglycerides (TG) is 19.9% with a confident interval between 18.4% (lower CVi)-21.6% (Higher CVi).
EFLM defines the Maximum Allowable Uncertainty (MAU) for TG to be desirable under the median CVi for TG (19.9%).
Previous studies found that patients distribution (PD) data´s charts on Modulab Gold can be used to ascertain CVi for biological magnitudes.
Objective: To define MAU for TG, evaluating the TG´s lower CVi for our Hospital Center´s population.
Material and Methods: We induce analytical bias for TG on an AU 5800, of -3%, -8%, +5%, +8%, +17% and + 25%.
We evaluate the impact of the induced analytical errors on the PD data´s charts on Modulab Gold LIS.
Results: We observed that with an analytical bias of +17%, the PD revealed a small upward shift on the baseline PD for TG (figure 1). This shows that there are some individuals of our population that TG´s CVi is slight smaller than 17%.
With the induced bias of +25%, we observed a total upward shift on the PD for TG (figure 2), with the median values of TG from 1.51 to 1.91 and distribution width from 0.87 to 1.44. This confirms that all the individuals of our population were affected by the analytical bias. Therefore, TG CVi is smaller than 25% for all individuals of our population.
We observed a stabilized PD for TG, on all the other induced analytical bias, confirming that the TG´s CVi is higher than those bias values (3%, 5%, 8%), for all the individuals of our population.
Conclusion: EFLMBV recommends a TG´s MAU desirable of 19.9%, assuming the lower interval CVi of 18.4%.
The results of our experiment shows that some individuals of our population might have a TG CVi smaller than 17% and thus we must define our MAU for TG at least as 17%, to minimize the impact of analytical errors above 17%, on our population.
It is important that each laboratory evaluates if the minimum CVi for its population is the same as on EFLMBV lower interval CVi, to define the analytical MAU that is safe for the vast majority of the individuals of its population.

P11
SAMPLE TRANSPORT PROCESS MANAGEMENT IN CLINICAL LABORATORIES USING THE IFCC QUALITY INDICATORS: PATHWAY TO CONTINUOUS IMPROVEMENT
Alcina Mateus1, Paula Leal1, Ângela Maresch1, Cristiana Canha1, Eulália Costa1, Fernando Rodrigues1
1 Serviço de Patologia Clínica, Centro Hospitalar e Universitário de Coimbra, Coimbra, Portugal
Introduction: Quality indicators are useful tools to improve laboratory quality[1] and safety, promoting a strategy in process management and monitoring, which allows to identify intervention points. The IFCC Working Group on "Laboratory Errors and Patient Safety" (WG-LEPS) promotes Key Process Indicators (KPI)[2] in different laboratory processes, including the pre-analytical phase and sample transport. Real-time monitoring of sample traceability and transport conditions/incidents that affect sample integrity and extend the laboratory’s response time, which are critical for sample quality impacting on the quality of the patient care[3]. The National Committee for Clinical Laboratory Standards (NCCLS) suggests a sample transport time lower than 2 hours at 10-22°C[4]. ISO 15189:2014[5] normalises sample traceability. The use of thermal bags with iCase® logger and iRacks® of the Indexor® sample system is an excellent tool for traceability and monitoring of temperature evidence during inter-hospital laboratory transport.
Objective: Evaluate the IFCC/WG-LEPS transport KPIs in our laboratory.
Materials and Methods: Analysis of monthly transport incidents between our three hospitals, using Makesense Analytics® software, during 2021 and 2022. Evaluated KPIs[6] were: 1) samples transported at inappropriate temperature (Pre-InTem); 2) samples damaged by shock during transportation (Pre-DamS); 3) samples with excessive transport time (Pre-ExcTim).
Results: A total of 3.789.911 blood samples were processed, of which 237.154 (6,26%) were transported inter-hospital. Pre-InTem samples corresponded to 0,0327% (0,0483% in 2021; 0,0169% in 2022), Pre-DamS corresponded to 0,7464% (1,2257% in 2021; 0,3330% in 2022) and Pre-ExcTim to 0,0003% (0,0004% in 2021; 0,0002% in 2022). On average, during this two years, 126 samples were compromised each month, 4 every day. 75% of the incidents occurred in 2021.
Conclusion: The use of IFCC quality indicators had a positive effect in the laboratory’s continuous improvement. In the end of 2021, interventions were applied, as an increase in the frequency of cold pack exchanging in the transport bags, resulting in better performance in 2022. Sample traceability, transport monitoring and process performance measurement are crucial to the quality of results.
P12
LYSOZYME-INDUCED NEPHROPATHY - A RARE ENTITY WITHIN MYELOMONOCYTIC LEUKAEMIA
Carlos Miguel Oliveira1, Paulo Dias Silva1, Nuno Gonçalves1
1 Instituto Português de Oncologia do Porto Francisco Gentil E.P.E.
Intro: About one third of patients with haematological malignancy develop acute kidney injury (AKI), usually of pre or post-renal cause. However a minority of cases relate to intrarenal causes, in particular leukostasis and lysozyme-induced nephropathy (LIN), a rare and under-valued entity.
Lysozymes are lytic proteins produced by monocytes. In monocytic leukaemias there’s an excess of production, which exceeds the reabsorption capacity at the proximal tubule. In addition to the inherent nephrotoxicity of lysozyme, aggravated by chronic renal disease, nephroticic-range proteinuria occurs, without albuminuria.
Although proteinuria and increased serum and urinary levels of lysozyme may suggest the diagnosis, it is definitively established with renal biopsy, with immunohistochemical evidence of tubular damage and accumulation of lysozyme.
There is no specific treatment described for NIL but improvements have been reported after treatment of the underlying pathology.
Clinical Case: A 72-year-old man with a history of CKD presented to the emergency department with altered language, atypical chest pain and weight loss. Analyses showed leukocytosis (403.240/µL, 74% blasts), severe electrolyte disturbances and proteinuria. He was admitted for suspected acute leukaemia with multifactorial AKI. He started cytoreduction and underwent 2 sessions of leukopheresis.
Bone marrow study reinforced the diagnosis of acute myelomonocytic/ monoblastic leukaemia with alteration in the KMT2A gene, associated with a poor prognosis. After exclusion of common AKI causes, serum lysozyme levels of 27,8 mg/L (normal: 2,5-8,0) and urinary lysozyme levels of 13,1 mg/L (N < 3) were obtained, strongly suggesting NIL.
The patient slowly improved his renal function and leukocytosis, but died about one month after admission and renal biopsy was not performed for definitive diagnosis.
Discussion: This clinical case reinforces the importance of a multidisciplinary view in the approach of the complex oncological patient. It is a rare case of intrarenal lesion in the context of haematological malignancy that clinicians should take into consideration after exclusion of the most common causes of AKI. The pathologist has an important role to suggest and provide relevant analytical tests that may aid the diagnosis of rare situations.
| EXHIBITION POSTERS
P07
SARS-COV-2 VARIANTS IN THE REGION OF LISBON: COMPARISON AND VALIDATION STUDY BETWEEN RT-PCR AND NGS METHODOLOGIES
Magda Franco1, Laura Cainé2, Joana Rodrigues1, Vânia Mofreita3, Rui Nascimento4, Olena Mukan1, Jennifer Fadoni1, Francisco Corte Real5, António Amorim6
1 Instituto Nacional de Medicina Legal e Ciências Forenses
2 Faculdade de Medicina da Universidade do Porto
3 Vânia Mofreita
4 Faculdade de Ciências e Tecnologia da Universidade de Coimbra
5 Faculdade de Medicina da Universidade de Coimbra
6 Faculdade de Ciências da Universidade de Lisboa
Introduction: SARS-CoV-2 is a coronavirusthat was detected in China in 2019. Since the pandemic started new variants have been emerging. Among them, Alpha, Beta, Gamma and Delta, defined as VOCs (Variants of Concern) 2–4 . Aims of the study The aim of this project is to identify the main VOCs and VOIs circulating in the region of Lisbon, applying the methodology of real time RT-PCR in cadavers that tested positive for SARS-CoV-2. To meet this goal, we used three assays: Allplex™ SARS-CoV-2 Variants I, Allplex™ SARS-CoV-2 Variants II and Allplex™ SARS-CoV-2 Variants V. The first one detects defining mutations of the Alpha, Beta and Gamma variants (N501Y, E454K and HV69/70del), the second assay detects mutations present in the Delta, Beta, Gamma and California variants (L452R, K417T, K417N and W152C) and the third one detects defining mutations of the Delta and Lambda variants (L452R, P681R, L452Q and F690S). We also compared the results obtained through RT-PCR with two methods of NGS: NGS-ONT (Oxford Nanopore Technologies) e NGS-Sanger based.
Methodology: In this study 72 SARS-CoV-2 positive swabs were used. RNA was extracted using an automatic extractor, according to the manufactor recommendations. With Allplex™ SARS-CoV-2 Variants I Assay, 72 samples were tested. With Allplex™ SARS-CoV-2 Variants II Assay 33 and with Allplex™ SARS-CoV-2 Variants
V Assay 14 samples. PCR preparation was performed according to the manufactor instructions. To validate the RT-PCR results, each sample was sequenced with at least one of the NGS methods indicated in the aims.
Results and conclusion: With the three assays together we concluded that 18 samples belong to the Alpha variant and 42 to the Delta variant. In 12 samples it was not possible to compare the RT-PCR and NGS results. The variants assigned by RT-PCR were coincident with the variants attributed by at least one of the sequencing methods in 100% of the samples (n=60). The percentage of the concordant results between the two methodologies suggests a huge efficacy of the three assays tested in this study in the correct identification of the different SARSCoV-2 variants.
P13
AUTOMATED HAEMATOLOGY ANALYSIS IN THE DIAGNOSIS OF MALARIA – MALARIA FACTOR AND ABNORMAL SCATTERGRAMS
Maria Matos Silva1, Rita Francisco1, Vanessa Pereira1, Maria Figueiredo1, André Silva1, Cristina Fonseca e Silva1, Pedro Gouveia1, Joaquim Freitas1, Maria Calle1
1 Centro Hospitalar do Tâmega e Sousa
Introduction: Malaria is a public health problem on a global scale, caused by Plasmodium spp.. It’s endemic in 85 countries, and although not endemic in Portugal, cases of imported malaria are more and more frequent. Therefore, there is a growing need for the development of a rapid, sensitive and cost-effective screening methodology of this disease. Studies using Beckman Coulter® automated cell counters described statistically significative changes in the standard deviation of the volume of monocytes and lymphocytes when malaria is present, which allowed the definition of a calculated discriminant factor, called the Malaria Factor (MF), whose value above 3,7 may be indicative of malaria.
Case Report: A 46-year-old male, emigrant in Luanda, was admitted to the Emergency Department with an intermittent fever for 5 days, with sweating, chills, headache, myalgia and nausea. Physical examination revealed apyrexia, a normal heart rate and blood pressure, with a pheripheral oxygen saturation of 98%. Blood test results were unremarkable apart from thrombocytopenia The automated complete blood count (CBC) showed an abnormal scattergram in the nucleated red blood cells (nRBC) channels. A peripheral blood smear (PBS) revealed the presence of Plasmodium spp. trophozoites incorporated in the erythrocytes. Rapid diagnostic testing (RDT) was positive for malaria, and the MF was calculated, with a value of 7,4.
Discussion: Malaria was not initially considered a differential diagnosis due to the absence of suggestive symptoms. However, the nRBC scattergram abnormalities combined with thrombocytopenia, raised the suspicion of malaria, which led to the observation of the PBS, RDT and the calculation of the MF, whose value confirmed the suspicion.
Malaria is an often forgotten differential diagnosis, and its gold standard for laboratory diagnosis – the observation of the PBS – is a difficult, slow and, particularly in cases of low parasitemia, dependent on the experience of the observer. Therefore, a rapid, sensitive screening method could prevent the underdiagnosis of malaria and accelerate its management. Since the CBC is an inexpensive, globally requested test, the analysis of its scattergrams and the MF could alert for the presence of malaria, leading to the targeted search of Plasmodium.
P14
LARGE GRANULAR LYMPHOCYTIC LEUKAEMIA - AN OVERLOOKED COMPLICATION OF SOLID ORGAN AND STEM CELL TRANSPLANTATION
Ricardo Oliveira1, Diogo Paulino2, Máriam Calú2, Carlos Severino2, Rui Barreira2
1 Serviço de Patologia Clínica, Centro Hospitalar Universitário do Algarve, Unidade Hospitalar de Portimão
2 Laboratório de Hematologia, Serviço de Patologia Clínica, Instituto Português de Oncologia de Lisboa Francisco Gentil
Introduction: Post-transplant T-cell large granular lymphocyte leukemia (PT-LGLL) is the most frequent form of large granular lymphocyte (LGL) lymphocytosis after transplantation, with some authors reporting an incidence of up to 9%. Its pathogenesis seems to be related to chronic antigenic stimulation (either from graft alloantigens or viral infections) associated with immunosuppression. Diagnosis is based on an otherwise unexplained lymphocytosis with a predominance of LGLs in the peripheral blood, immunophenotyping and an eventual assessment of clonality through TCR gene rearrangement or KIR restriction. Most patients have an indolent course, similar to de novo T-cell large granular lymphocyte leukaemia (T-LGLL) and treatment in most cases relies on immunosuppressive therapy.
Case Presentation: We present a 65-year-old male with a history of kidney transplants in 1987, and again in 1999, referred for persistent anaemia. His physical examination was unremarkable with no hepatosplenomegaly or lymphadenopathy. Initial blood tests showed macrocytic anaemia (9.6 g/dL Hb, 114 fL MCV), leukocytosis (10.7x103/uL), lymphocytosis (8.7x103/uL) and mild neutropenia (1.27x103/uL). Examination of peripheral blood smear showed the presence of large granular lymphocytes (LGLs) with moderate to abundant cytoplasm and fine or course azurophilic granules, which made up the predominant cell type (72%).
Bone marrow aspirate revealed infiltration with LGLs and erythroid hypoplasia. Bone marrow biopsy showed infiltration by lymphomatous TCRdelta T-cells, suggesting T-LGLL. Flow cytometry (bone marrow) revealed 35% of pathologic T-cells with the following immunophenotype: CD1a-, CD2+, CD3+, CD4-, CD5-, CD7, CD8-, CD16-, CD38+, CD45+, CD57+, Gamma-Delta TCR+. Based on the morphology and immunophenotype, the patient was diagnosed with T-LGLL.
A monoclonal IgG kappa protein was identified by immunofixation electrophoresis.
Discussion: PT-LGLL is an often overlooked complication of solid organ and stem cell transplantation that may be misinterpreted as a reactive condition. When an LGL expansion occurs in these patients, it is important to differentiate reactive from neoplastic lymphocytes in order to avoid delays in the definitive diagnosis, allowing for appropriate intervention.
P15
DELETIONAL ALPHA-THALASSEMIA AND HEMATOLOGICAL PHENOTYPE: PREDICTIVE PARAMETERS OF DIFFERENT DELETIONS
Gisela Gaspar1, Rita de Mira Ramalho2, Filomena Seuanes1, Carla Feliciano1, Guida Duarte1, Sandra Copeto1, Alcina Costa1, João Xavier Santos1, Armandina Miranda1
1 Department of Health Promotion and NCD Prevention, National Institute of Health Doutor Ricardo Jorge, Lisbon, Portugal
2 Clinical Pathology Service, Portuguese Institute of Oncology of Lisbon Francisco Gentil, Lisbon, Portugal
Introduction: Thalassemias are characterized by a quantitative imbalance of the globin chains due to the reduction or suppression of the synthesis of one of the globin chains.The hematological tests usually used as indicative for the investigation of α-thalassemia are the blood count with MCV (Mean Cell Volume) < 80 fL and/or MCH (Mean Cell Hemoglobin) < 27 pg and normal Hb A2 (< 3.5%).
Aim: This study aimed to correlate the different deletional α-thalassemia genetic alterations with the corresponding hematological phenotype, based on casuistry from 2015 to 2019.
Methodology: Was evaluated retrospectively 496 cases suspected of deletional α-thalassemia from 2015 to 2019 and correlated them with the hematological data available. We searched for α-thalassemia deletions by Gap-PCR and Multiplex Gap-PCR.
Haematological evaluation was carried out by the erythrogram, Hb isoelectric focusing and quantification of Hb A2 and Hb F (Ion exchange high performance liquid chromatography).
The statistical analysis of the results was carried out through calculating the mean, standard deviation, median, and t-Student test, with a significance level of 0.05.
Results and discussion: Most patients (n=190) had a normal genotype (αα/αα), followed by heterozygosity (-α3.7/αα) (n=148) and homozygosity (-α3.7/α3.7) (n=141) for the 3.7kb deletion. We also detected 5 cases of heterozygosity for the 4.2Kb deletion (-α4.2/αα), 4 of double heterozygosity (α3.7/α4.2), 7 heterozygosity α0 (--SEA /αα) and 1 of HbH (--SEA/-α3.7).
The results showed that the MCV and the MCH are excellent hematological indices for screening and selection of patients for molecular testing (their value being the lower the greater the number of deleted genes). Our results are in line with those described in the literature and reinforce that the cut-off value of 25 pg (MCH) is sensitive enough to infer the presence of α0 -thalassemia deletion.
The detection of the α0 deletion is very important in preventing the occurrence of Hb Bart’s in the offspring of a carrier couple.
The diagnosis of deletional α-thalassemia is realised by genetic testing, however hematological indices are relevant predictive markers of the number of deleted alpha genes and the phenotype /genotype correlation.
P16
A CASE OF NPM1/FLT3 ACUTE MYELOID LEUKEMIA AND MYELODYSPLASIA
Eliana Cajigas Silva1, Joana Caldas1, Isabel Poças1, Vitória Cabral1, Carla Carvalho1
1 CHULC
Introduction: Acute myeloid leukemia (AML) is associated with a variety of clinical, morphological, immunophenotypic and genetic presentations. The NPM1 mutation is a relatively common recurrent genetic alterations present in approximately 27-35% of total adult AML cases with normal karyotype. NPM1 usually confers good prognosis while FLT3 mutation es related to unfavorable prognosis as well as multilineage dysplasia that is not present in “de novo AML cases”. Therefore the concomitant presence of the NPM1 mutation and multilineage dysplasia is seldom observed. The association of FLT3 to the NPM1 mutation, is frequent and independent of the presence of dysplasia feature.We present a case of “de novo” AML with NMP1/FTL3 mutation, normal karyotype, and trilineage dysplasia.
Clinical Case Report: A 60-year-old woman was refered to Hematology consultation for de novo bicytopenia. Full blood and chemical count showed anemia (Hb8.3g/dL, MCV101.7 fL) Leuc 8,4x10˄9/L, Neut 2,75x10˄9/L, Monocytosis 3,19x10˄9 and Blasts 1,65X10˄9(15%), PLT 94x10˄9/L.Bone marrow aspirate showed increased cellularity, blasts 22%, promonocytes 7% and trilineage dysplasia. Cytochemistry: Positive Black Sudan B, NASDA inhibited by NaF. Perls: increased hemosiderinic iron without ring sideroblasts.Immunophenotyping identified a pathologic population with myeloid differentiation (homogeneous CD33+, strong homogeneous CD13+, MPO, CD7+) immature component CD34-, CD117+, weak CD45+, HLA-DR-+. Subdivision into neutrophilic and monocytic populations, with signs of dysplasia and altered CD13/CD11b maturation patterns, as well as in the erythroid lineage, which constituted 51% of the sample cellularity.Molecular Biology confirmed the mutation NPM1and FLT3/ITD and cytogenetics with a normal karyotype (46 XX). FISH 5q-, 7q31, 20q12 negative.
Conclusions: The rare association between AML NPM1 mutation and dysplasia remains unclear, apparently does not confer a worse clinical prognosis but it remains to be seen.

P17
THROMBIN GENERATION TEST AS A POWERFULL TOOL IN CLINICAL DECISION – CASE REPORTS
Tânia Cardoso1, João Pego1, Anália Carmo1, Isabel Guiomar Rasteiro1, Ana Correia1, Fernando Rodrigues1
1 Centro Hospitalar e Universitário de Coimbra
Introduction: One of the major health challenge is the ability to predict the risk of bleeding or thrombotic disorders. The conventional haemostatic tests provide limited assessment of thrombin generation and are insensitive to natural anti-coagulants. Therefore, global coagulation assays, like the fully automatized thrombin generation test from Diagnostica Stago® (STG), have been developed in order to assess the overall coagulation potential. Three kits are available with distinct goals: STG-BleedScreen to assess the bleeding risk in haemophilia patients; STG-ThromboScreen, to evaluate thrombotic risk in patients with thrombophilia or history of thrombosis; STG-DrugScreen to monitored the anti-thrombotic drugs.
Case Reports: A 60-years-old man was referred to neurology consultation due to a left sensory lacunar stroke one year ago. The patient was under acetylsalicylic acid since then, without new neurological events. However, he maintained paraesthesia in the hemiface and left hand and sexual impotence. The patient had smoking history and hypertension. Complementary study found atherosclerotic pathology. Analytically, no significant alterations were detected on the blood tests, except hypercholesterolemia and the STG-Thrombocreen show ETP Inhibition of 53% indicating that thrombosis risk was not likely.
A 48-years-old woman was referred to neurology consultation due to a ischemic stroke with thrombectomy, two years ago, with full recovery of neurological deficits and no new events. She was discharged anticoagulated with dabigatran. An etiological study was performed and a patent foramen ovale (FO) was identified. A cardiac procedure was performed to close the FO, the anticoagulant was suspended and she started dual antiplatelet therapy. The patient had no relevant personal history. No significant alterations were detected on the blood tests. STG-Thromboscreen was performed with ETP Inhibition of 24% predicting thrombotic risk.
Discussion: Although both clinical case-reports refer to ischemic events, in the absence of supporting clinical data, the decision to anticoagulated can be difficult. STG-Tromboscreen presents itself as an extremely useful tool to evaluate the thrombotic risk and to establish the adequate therapeutic plan.
P18
VACUOLATED LYMPHOCYTES IN GALACTOSIALIDOSIS: A CASE REPORT
Sofia Costa1, Olimpia Varela1, Ana Bento Pinto1, Sara Sousa1, Ana Paula Castro1, Eliana Costa1
1 Centro Hospitalar de Tras-os-Montes e Alto Douro
Introduction: Galactosialidosis (GSD) is an hereditary lysosomal disease, autosomal recessive, resulting from alterations to the CTSA gene that cause a deficit of β-galactosidase and neuraminidase enzymes. It is a multi organic disease with cognitive, ocular, muscular and skeletal manifestations. It can manifest itself in several age groups, the most common being the juvenile/adult form. The early-infantile form has more severe earlier symptoms and limited survival. The diagnosis is based on clinical presentation and genetic tests. Since it is a very rare pathology, case reports are particularly important.
Clinical Case: We report the case of an 18-month-old child with a personal history of ascites/neonatal subcutaneous edema, anemia, severe bronchopulmonary dysplasia, patent foramen ovale with left-right shunt, mild pulmonary hypertension and multiple infectious episodes. She was admitted to the emergency department due to respiratory difficulty. On physical exam she presented polypnea with subcostal indrawing, abdominal distention with hepatosplenomegaly and peripheral edema. The most relevant analytical findings were pancytopenia (hemoglobin 7.8g/dL (10-16g/dL); leukocytes 4.86x103/µL (6-14x103/µL); platelets 71x103/µL (150-400x103/µL)) and presence of numerous lymphocytes with cytoplasmic vacuoles in the peripheral blood smear (PBS), suggestive of lysosomal disease. Following these findings the clinical file was consulted, and we found it to be a case of GSD in the early infantile form (diagnosed during the gestational period due to fetal hydrops that led to amniocentesis) confirmed by Array-CGH that revealed homozygosity in the CTSA gene.
Discussion: GSD is a rare pathology making its diagnosis challenging. The presence of lymphocytes with vacuolated cytoplasm in the PBS (or bone marrow smear) associated with a suggestive clinical history, is an important finding for suspecting lysosomal disease, with the advantage of being a quick, non-invasive low-cost test.
P19
CHARACTERIZATION OF ACUTE MYELOID LEUKEMIA WITH TRIPLE-NEGATIVE IMMUNOPHENOTYPE FOR CD34, CD11B AND HLA-DR, CONTRIBUTION OF LABORATORY HEMAT
Laís Simonato Altoé1, Rita Marinho3, João Pessanha Moreira2, Catarina Faria Coelho1, Paulo Paulino1, Filipe Santos1, Catarina Lau3, Maria dos Anjos Teixeira3.2
1 CHUdSA Laboratory Hematology Service CHUdSA
2 Clinical Chemistry Service CHUdSA
3 Flow Cytometry Laboratory of the Diagnostic Hematology Unit Margarida Lima CHUdSA
Introduction: Frequent the triple negative profile (CD34, HLA-DR and CD11b), shows high specificity and positive predictive value for the diagnosis of Acute Promyelocytic Leukemia (APL). However, the absence of immunophenotypic expression of these antigens in leukemic cells also occurs in other subtypes of Acute Myeloid Leukemia (AML). The current clinical case highlights the contribution of Laboratory Hematology to the differential diagnosis through the morphological characterization of the leukemic cells.
Clinical Case: A 74-year-old woman was referred to a Clinical Hematology consultation for peripheral blood leukopenia, confirmed on admission. Peripheral blood smear (PBS) revealed the presence of 2% immature cells, increased nucleus-cytoplasm ratio, poorly condensed chromatin, sometimes delineating the nucleolus and small Auer rod. The cytomorphological study of bone marrow aspirate (BMA) was described as slightly hypocellular, also revealed the presence of 65.0% blasts, with some heterogeneity in size and morphology, being mostly medium sized cells, with high nucleus/cytoplasm ratio, loose chromatin nucleus and presence of one or more nucleoli, rarely showed Auer’s rod. Most of the blasts observed also showed cytoplasmic "blebs" and positive Myeloperoxidases reaction. Suggesting the diagnosis of cup-like AML. Flow cytometry immunophenotyping (FCI) of BMA showed 63.9% immature cells of the myeloid lineage with positivity for CD45, MPO (myeloperoxidase), CD13, CD33, CD38, CD71 (weak), CD117 and variable CD36; and negative for CD11b, CD14, CD15, CD34, CD56, CD64, CD65, CD123 and HLA-DR. The molecular study detected no mutations in the FLT3 gene, nor a t(15;17) PML:RARA transcript, but a mutation in the NPM1 gene was found. The cytogenetic study of the BMA found karyotype 46, XX, with no visible chromosomal numerical or structural changes. The patient is under chemotherapy for cup-shaped AML with NPM1 mutation.
Final Remarks: Therefore, morphological characteristics can be useful in predicting molecular alterations that are of prognostic expression and also useful in the differential diagnosis with ALP - which requires, due to its particular characteristics, immediate therapeutic initiation. Thus, the morphological and phenotypic study of PBS and BMA proved to be fundamental in the diagnosis, and the role of Laboratory Hematology and Flow Cytometry Laboratory were crucial.
PO20
EOSINOPHILIAS IN PEDIATRIC AGE
Tiago Ramalho1, Catarina Fraga1, Cacilda Magalhães1, Luís Salazar1, Sílvia Duarte Costa1, Rui Almeida1, Georgeta Oliveira1, Yuliana Eremina1
1 Unidade Local de Saúde de Matosinhos
Introduction: Eosinophilia is defined as an absolute eosinophil count greater than 500/uL in peripheral blood. It is divided into three grades: mild (500 to 1500/uL), moderate (1500 to 5000/uL) and severe (above 5000/uL).
Objective: The aim of this study was to carry out an epidemiological characterization of this entity in the pediatric population of a Local Health Unit.
Materials and Methods: A retrospective, observational and unicentric study was conducted, which included all blood counts with leucocyte differential from patients under 18 years of age, processed in the central laboratory of a Local Health Unit (which encompasses primary and hospital health care), between January 2012 and December 2021. They were organized into groups corresponding to the eosinophilia grade and duplicates within each group (patients with more than one blood count) were removed. Each group was descriptively characterised. Sazonality influence was assessed using Kruskall-Wallis Test. Data were retrieved using the Laboratory Information System (Clinidata® XXI, Maxdata) and analysed using Microsoft Excel and Prism5.03® (GraphPad).
Results: A total of 51378 blood counts were obtained (51% boys), distributed as follows: mild eosinophilia - n=7830 (92.90% of eosinophilias), median age 5.4 years, 58% boys and 71% hospital origin; moderate eosinophilia - n=588 (6.98%), median age 5.1 years, 63% boys and 76% hospital origin; severe eosinophilia - n=10 (0.12%), median age 4.3 years, 50% boys and 80% hospital origin. Regarding seasonality, no statistically differences were found, although moderate eosinophilia was slightly more frequent in the third trimester (31.63%). The years 2020 and 2021 showed a decrease in the absolute number of blood counts, without affecting the relative frequency of eosinophilia.
Conclusions: The present study allowed to conclude that there is a higher relative frequency of eosinophilia in boys, it appears around ages of 4-5 years old and is mainly detected in hospital settings. It was also found that the greater the eosinophilia degree, the earlier the age and the greater the relative frequency of hospital origin of the patients. The influence of seasonality in this cohort was not significant. An articulated study with clinical findings will now be relevant to determine the most prevalent etiologies.
PO21
SEPSIS UNDER THE MICROSCOPE AND THE TIME TRIAL CHALLENGE
Virginia Martinez1, Ana Simoes, Ana Couto, Isabelle Carrilho,Joana Costa,Ana Catarina Dias, José Alves ,Jorge Loureiro1
1 CHTV
Introduction: Sepsis is a clinical syndrome that appears as result of a systemic inflammation due to infection, leading to multiple organ dysfunction and death.
In Portugal, up to 22% of hospitalizations in intensive care units are due to episodes of septic shock with mortality rate that can rise to 38%, three times higher than the rates for stroke in 2007.
Clinical evaluation presupposes screening for patients with sepsis and septic shock using the qSOFA score. Laboratory test results can be nonspecific, such as leukocytosis or hyperlactatemia, since elevated lactate is associated with poor prognosis. Additional laboratory studies that help characterize the severity of sepsis include a low platelet count, elevated INR, creatinine and bilirubin. Elevated serum procalcitonin levels are also associated with bacterial infection and sepsis.
Clinical Case: Woman,74 years old, autonomous, history of diabetes with appropriate medical therapy.
On arrival at the ER the patient presented with hyperthermia, hypotension, tachycardia and prostration.
To rule out a septic shock, a battery of laboratory tests were requested. The arterial blood gas presented with metabolic acidosis, with progressive increasing lactates. Whole blood count revealed anemia, leukocytosis with neutrophilia. Acute renal failure with elevated C-reactive protein and procalcitonin levels were also found. A peripheral blood smear revealed dysplasia of the myeloid elements with presence of Dhöle bodies, cytoplasmic vacuoles and toxic granulations, suggestive of an acute infectious context.
Although all efforts were made, the patients clinical status worsened and she passed away.
Discussion: Examination of the peripheral blood smear is an inexpensive but powerful diagnostic tool that often provides rapid, reliable access to information about a variety of hematologic disorders. Review of the smear is an important addition to other clinical data; in some cases, the peripheral smear alone is sufficient to establish a diagnosis.
In cases where sepsis is suspected, the review of the smear takes less time than the remaining analytical results required for diagnosis, and can thus provide information needed for a quick therapeutic decision.
PO22
HAIRY CELL LEUKEMIA OR HAIRY CELL LEUKEMIA VARIANT? – A CLINICAL CASE
Cláudia Lopes1, Fernanda Tomé1, Hugo Sousa1, Joana Ferreira1, Isabel Loureiro1
1 Centro Hospitalar Entre Douro e Vouga
Introduction: Hairy cell leukemia (HCL) is an indolent haematologic neoplasm of mature B-type lymphoid cells which involves the peripheral blood and diffusely infiltrates the bone marrow and splenic red pulp. It is a rare disease, responsible for only 2% of lymphoid leukemias.
Neoplastic cells are found mostly in the bone marrow and spleen, with few circulating cells. Its typical course includes splenomegaly and pancytopenia. Monocytopenia is common. Morphologic features include: lymphoid cells with small to medium size, oval or kidney-shaped nuclei with homogeneous chromatin, slightly looser, with no evident nucleoli and abundant cytoplasm with “hairy” projections.
The hairy cell leukemia variant (HCL-v) includes cases that resemble classic HCL, but are associated with: leukocytosis, presence of monocytes, lymphoid cells with different morphological, immunophenotypic and cytogenetic characteristics and different response to conventional therapy.
Clinical case: We present the case of a 56-year-old patient, admitted to the Internal Medicine Department of Centro Hospitalar Entre Douro e Vouga on 14/11/2022 for pneumonia.
The complete blood count revealed macrocytic anemia (Hb 10.5g/dL), 7.7x109/L leukocytes, with 1.86x109/L neutrophils, 3.25x109/L lymphocytes and monocytosis (2.5x109/L). In the peripheral blood smear it was observed a sub-population (predominant) of lymphocytes with cytoplasmatic projections, very suggestive of clonality.
Taken into account the morphological findings, with suspected HCL, the patient was referred to the CHEDV´s Haematology Department, having carried out an immunophenotypic study (ISF) of the peripheral blood (PB), that revealed the presence of >99% of B Lymphocytes with a phenotype, very suggestive of Hairy cell leukemia. In the BM, the ISF showed hairy cell leukemia infiltration.
Discussion: The clinical case presented combines typical features of HCL as well as its variant.
Since the definition of the nosological entity is essential for therapeutic guidance, in the initial approach it is crucial to establish a correct clinical evaluation and characterization (morphological, immunophenotypic and cytogenetic) of the cell population involved.
PO23
COMPARISON OF TWO AUTOMATED HEMATOLOGY ANALYSERS: BECKMAN COULTER® DXH900 AND MINDRAY® BC6800
Nídia G. Neves1, Marlene A. Pires1, Sónia Freitas2
1 Serviço de Patologia Clínica, Hospital Central do Funchal
2 Centro de Investigação Dra Maria Isabel Mendonça, Serviço de Saúde da Região Autónoma da Madeira
Background: For clinical laboratories, it is very important to evaluate the agreement of the different automated hematology analysers available, in order to guarantee the quality of the reported results. The DxH900 is the newest haematology system from Beckman Coulter®, able to perform a cell blood count (CBC) with enhanced Coulter principle using digital impedance. BC6800 is a multiparameter haematology counter from Mindray® which uses a combination of impedance and flow cytometry for the CBC.
Aim: To compare the analytical performance of the two analysers, in terms of white blood cells count (WBC), red blood cell count (RBC), haemoglobin (Hb), hematocrit (Ht), mean red cell volume (MCV), RBC distribution width (RDW), platelet count (PLT) and mean platelet volume (MPV).
Methods: A comparative analysis of 114 K3-EDTA-anticoagulated blood samples was performed (71 from female and 43 from male gender) in both analysers. The obtained results were evaluated using Bland-Altman analysis, performed with MedCalc® Software.
Results: Both analysers showed very good agreement for PLT and MCV. Statistically significant differences were found for WBC, RBC, Hb, Ht, RDW and MPV (p<0.05). From the Bland-Altman display, there is evidence that the DxH900 counted lower results for WBC, RBC, Ht and MPV (bias was -2.8%, - 6.5%, -5% and -7.8%, respectively) and higher results for Hb and RDW (bias was +0.4% and +3.5%, respectively). There were also a proportional difference between the 2 analysers for WBC, RBC, Ht, RDW and MPV.
Conclusion: It can be considered that there are statistically significant differences between the compared analysers for the majority of the parameters (except for PLT and MCV, which demonstrated excellent agreement). Therefore, the analysers were not entirely interchangeable.
Nonetheless, we do not have a comparison for each analyser against a reference method, so we cannot conclude that one is more accurate than the other.
PO24
NEXT GENERATION SEQUENCING FOR VARIANT DETECTION OF SARS-COV-2 IN A MEDICO-LEGAL CONTEXT IN THE SECOND YEAR OF THE PANDEMIC
Joana Rodrigues1, Laura Cainé2, Vânia Mofreita1, Rui Nascimento3, Olena Mukan1, Jennifer Fadoni1, Francisco Corte Real4, António Amorim5
1 Instituto Nacional de Medicina Legal e Ciências Forenses
2 Faculdade de Medicina da Universidade do Porto
3 Faculdade de Ciências e Tecnologia da Universidade de Coimbra
4 Faculdade de Medicina da Universidade de Coimbra
5 Faculdade de Ciências da Universidade de Lisboa
Introduction: In 2019, the SARS-CoV-2 virus emerged in China and spread around the world 2019 1 . Most patients develop pneumonia with symptoms such as fever, fatigue, anosmia, hypogeusia and cough 2 . Diagnosis is made by serological and molecular tests. Molecular tests are more effective in the early detection of infection, detecting viral RNA with PCR techniques 3 . Next-Generation Sequencing (NGS) technologies have rapidly become the preferred method for many applications in virology. One of the advantages of this technology is the reconstruction of whole viral genomes directly from clinical samples, even for unknown or poorly characterized viruses 4 . In the case of SARS-CoV-2, NGS technologies are being developed in variant identification and control. These variants may be more effective in their spread, due to mutations that give the virus a selective advantage, making its characterization important 5 . Aims: Determination of SARS-CoV-2 variants by application of the NGS Oxford Nanopore method in positive samples from corpses.
Material & Methods: Every day, samples of corpses are received by the medico-legal services of Lisbon region for SARS-CoV-2 diagnosis. As the n in study was low, n=40, we added a group of 36 living individuals, with respiratory symptoms, whose samples were collected in the same period. RNA extraction from nasopharyngeal samples was performed with the EZ1 DSP Virus Extraction Kit (QIAGEN). An RT-PCR assay was performed to detect the N and E genes as well as the human RNase P gene. For sequencing, we used the NEBNext® ARTIC SARS-CoV-2 Companion Kit. The files obtained from the samples were imported in the INSaFLU platform. The results were sent to NEXTCLADE for variant analysis.
Results & conclusions: Constant surveillance for new variants is of utmost importance, both in living individuals and in cadavers, and this study is a contribution to the epidemiological panorama in the Lisbon region. Studying corpses samples for the presence of SARS-CoV-2 virus leads to better screening for its presence in the population. In both groups we detected SARS-CoV-2 variants and identified several SNVs (single nucleotide variants). Analyzing the distribution of the variants of the samples, in the semesters of 2021, it was found that in the 1st semester there was a predominance of the variants 20A (EU1) and 20I (Alpha), being, in the 2nd semester, replaced by the variant 21J (Delta). Our data were according to the available bibliography.
PO25
RESULTS OF THE PORTUGUESE EQA PROGRAM FOR MOLECULAR DETECTION OF SARS-COV-2, 2020-2022
Helena Correia1, Susana Silva2, Catarina Ventura1, Aryse Melo3, Raquel Guiomar3, Ana Faria1
1 INSA-DEP AEQ
2 INSA-DEP
3 INSA-DDI
Portuguese National External Quality Assessment Program (PNAEQ) in collaboration with National Reference Laboratory for Influenza and Other Respiratory Viruses (NRL) organized an External Quality Assessment Program (EQA) for detection of SARS-CoV-2 virus by molecular methods. The majority of the rounds included extra-analytical questions.
We aim to evaluate the results of implementation of a national external quality assessment program for the molecular detection of SARS-CoV-2 virus during 2020 – 2022.
The participants were national public, private hospitals and ambulatory/academic laboratories.
Twenty four samples were distributed (15 positive and 9 negative) from extracted nucleic acid or inactivated virus. Each round consisted of 5 samples (500 µL) distributed twice a year, with exception on 2020 where only one round was available with four samples (30µL).
The samples were prepared by the expert laboratory (NRL) who also conducted the homogeneity and stability tests according to ISO 13528:2015 6.1.1.a.
The programme documentation was available online (instructions and result form).
Qualitative results were evaluated according to the expected results. Inconclusive results were considered discordant.
Different laboratories (100) participated on the 5 rounds for molecular detection of SARS-CoV-2. The mean participation rate for the molecular detection SARS-CoV-2 was 97%.
Samples were considered homogeneous, stable and suitable for laboratory performance assessment.
For the 9 negative samples the mean percentage of concordant results was 99% with a total of 7 false positive results and 5 inconclusive corresponding to a mean average of 1% discordant results.
For the 15 positive samples the mean percentage of concordant results was 94% (68%-100%) with a total of 55 false negative results reported and 27 inconclusive results corresponding to a mean average of 6% discordant (0%-32%).
It was observed a high percentage of returned results. The performance was better for the negative samples.
Overall, the program results indicate a good performance of the Portuguese Laboratories participating in EQA, although we consider that more attention should be paid to the samples within the clinical decision. To improve inconclusive results, education regarding interpretation must be performed.
PO26
EVALUATION OF DRUG SENSITIVITY IN TUBERCULOSIS (MOLECULAR AND PHENOTYPIC METHOD), PNAEQ RESULTS (2018-2022)
Edna Pereira 1 , Helena Correia1, Anabela Silva2, Ana Faria1
1 INSA-DEP AEQ
2 INSA DDI
Detection of resistance allows an adequate therapeutic scheme, contributing to an increase in therapeutic success and a decrease in mortality. Participation in external quality assessment programs allows laboratories that perform drug sensitivity in tuberculosis to evaluate their results.
The objective is evaluate performance of participants of National Program for External Quality Assessment in 2 programs Micobacteriology, molecular detection of multidrug resistance (DMMR) and Micobacteriology, sensitivity to first-line drugs (TSA) in 2018-2022.
Each program consists of 5 strains, with instruction letters and result forms.
The expert laboratory for tuberculosis prepares the samples and evaluates results by comparing with those obtained in Proficiency Testing of the WHO Supranational Laboratories Network.
For DMMR participants determine the most frequent mutations that confer resistance to isoniazid (ISO) and rifampicin (RIF).
Were sent 25 samples, of which 9 are sensitive and 12 are resistant to both drugs. The remaining samples are either resistant to ISO or RIF.
For TSA participants determine sensitivity to first-line drugs ISO, RIF, ethambutol (EMB) and pyrazinamide (PZA).
Of the 25 samples sent, 10 are sensitive and 8 are resistant for all drugs. The remaining samples are resistant to one or more drugs.
In the 5 rounds the mean participation in DMMR was 73% and in TSA was 82%.
The evaluation of DMMR results for samples without resistance to the two drugs was 100%.
In samples with resistance to both drugs, 6 false sensitive (FS) results to ISO (19%) and 1 FS result to RIF (3%) were found. In the 2 samples resistant to RIF all answers were correct. In 2 samples resistant to ISO, one of the laboratories presented 1 FS result for ISO and false resistant (FR) for RIF for the same sample.
The evaluation of TSA results for the non-resistant samples was 99.5% with an FR result for the PZA. In the samples with resistance for 4 drugs, 3 FS (2%) were observed (1 ISO and 2 EMB). For samples with resistance to one or more drugs, 2 FR (2%) for PZA were reported.
In DMMR, no discordant results were found for strains sensitive to 2 drugs and for strains resistant to RIF. In the remaining samples, the most frequently found errors were false sensitivity. This error can compromise therapeutic success. In TSA, the results found for ISO and RIF are quite good. The results for EMB and PZA reflect the known technical difficulties in testing these drugs.
PO27
IN HOUSE REAL-TIME PCR MULTIPLEX FOR SIMULTANEOUS DETECTION OF HUMAN INFLUENZA A AND B VIRUS AND RESPIRATORY SYNCYTIAL VIRUS
Jennifer Fadoni1, Laura Cainé2, Joana Rodrigues1, Vânia Mofreita1, Rui Nascimento1, Olena Mukan1, Francisco Corte Real3, António Amorim4
1 Instituto Nacional de Medicina Legal e Ciências Forenses
2 Faculdade de Medicina da Universidade do Porto
3 Faculdade de Medicina da Universidade de Coimbra
4 Faculdade de Ciências da Universidade de Lisboa
Introduction: Human influenza infection typically causes minor and self-limiting respiratory symptoms, although it can potentially lead to severe clinical illness, hospitalization, and death. Respiratory syncytial virus (RSV) is a highly contagious pathogen with rates of morbidity and mortality similar to seasonal influenza. The seasonality and clinical presentations of influenza and RSV infections are very similar, therefore, the simultaneous detection of influenza A/B and RSV by multiplex PCR allows the discrimination of different infections, requires less hand-on time, and enables the reduction of analysis costs. In addition, recent case reports have suggested that concurrent infections of SARS-CoV-2 with RSV or influenza A might influence the morbidity and mortality of patients with COVID-19, which reinforces the importance of developing rapid, reliable and specific assays for viral infections detection and differential diagnosis.
Methodology: Primer, probe, and assay design was performed in our laboratory. Primers and probes were designed to highly conserved regions of the influenza A, influenza B and the RSV genome, and the ribonuclease P (RNase P) protein gene (internal control). The probes for Influenza A, Influenza B, RSV and RNase P were labelled with the fluorescent dyes FAM, HEX, CALRED 610 and QUASAR 670, respectively. From 85 nasopharyngeal swabs collected post-mortem that demonstrated to be positive for SARS-CoV-2, RNA was extracted using the Qiagen EZ1 Virus mini kit v2.0 according to the manufacturer’s instructions. The amplification and detection of influenza A/B and RSV viral RNA, and RNase P were performed in a one-step RT-PCR, combining the reverse transcription and amplification reaction in a single protocol.
Results and conclusions: From the 85 samples analysed, no cases of human influenza B or RSV virus were identified. One of the samples, extracted from a 50-year-old female, demonstrated to be positive for human influenza A. In the present cohort, the prevalence of coinfection was 1.18%. Our multiplex PCR assay is a useful option of a high-throughput test, with the simultaneous detection of influenza A/B and RSV viruses. This study highlights the usefulness of a fast and sensitive multiplex method for the detection of viral infections, necessary in order to discriminate different types of infections as well as to detect the presence of coinfections, which in turn can reduce transmission and gather data for surveillance purposes.
PO28
ANTIMICROBIAL RESISTANCE PROFILE AND ASSOCIATED RESISTANCE GENES OF S AUREUS ACCORDINGLY TO ADVANCED EXPERT SYSTEM (VITEK2.0)
Luís Morais1, Rui Figueiredo1, Afonso Santos1, Jóni Mota1, Paula Gama1, Carlos Cortes1
1 Centro Hospitalar do Médio Tejo
Introduction: Multidrug-resistant S. aureus especially methicillin-resistant (MRSA) strains are a major human health concern causing severe morbidity and mortality. MRSA is one of twelve priority pathogens that threaten human health as classified by the World Health Organization (WHO). S. aureus is commonly present in human infections. We analysed AMR profile and genetic resistance mechanisms associated using the Advanced Expert System (AES), which interprets MICs generated by the VITEK 2.
Methods: Samples were processed in Clinical Pathology Service, identified by Vitek 2.0 (BioMerieux) and Maldi-Tof (Bruker). There were analysed samples from 2018 to 2022 using P648 card. AMR MICs were accessed by AES Vitek 2.0. Data were collected from Vitek 2.0.
Results: A total of 1685 samples were analysed. The most S. aureus analysed belong to exudates (n=585; 34.6%), and bloodstream infections (n=495; 29.4%). From all S. aureus, 1520 (90.2%) were resistance to at least one antimicrobial agent tested. In aminoglycosides resistance the association of aph(2”) more aac(6’) was observed in 60 (3.6%) of isolates. Gene aph(3’)-III and ant(4’)(4”) were observed in 1596 (94.7%). Generally, resistance to oxacillin were observed in 690 (40.9%), associated in all cases to mecA gene. In exudates samples, MRSA prevalence was 186 (31.6%), and in bloodstream isolates were 226 (45.3%). Vancomycin resistance was observed in 2 (0.1%) isolates, one from blood other from urine. MRSA rate decrease from 47.8% (n=142) in 2018 to 35.1% (n=106) in 2022. Quinolones resistance was observed in 778 (46.2%) of S. aureus isolated, with a decreased from 51.3% (n=158) in 2018 to 44.6% (n=136) in 2022.
Simultaneously resistance to quinolones and aminoglycosides were observed in 39 (2.3%) of isolates.
Conclusions: This is a quick observation of results given by AES of Vitek 2.0. The antibiotic-resistance rates varied among MRSA isolated from different sources. More accurate and alternative methodology could improve our knowledge about antimicrobial resistance genes present in S. aureus. Further research on the molecular epidemiology of antibiotic resistance genes in the study area to effectively control the spread of multidrug resistant pathogens must be performed.
PO29
INFLUENZA A AND B AND RSV VIRUSES PREVALENCE DURING SARS-COV-2 PANDEMIC (2020-2022)
Diogo Gregório1, Carolina Salteiro1, Ana Lory1, Olga Costa1, Rita Côrte-Real1, Carlos Flores1
1 Centro Hospitalar Universitário de Lisboa Central
Introduction: Influenza A and B and Respiratory Syncytial Virus (RSV) may cause acute viral respiratory tract infections with large sintomatology spectrum and can be responsible for cardiopulmonary diseases exacerbation with poor prognosis in some patients. They predominate in Autumn and Winter.
Objective: To analyse Influenza A, B and RSV distribution in pandemic years, according to gender and age groups: ≤ 5, 6-18, 19-64, ≥ 65 years.
Material And Methods: Retrospective study of 44055 upper respiratory tract samples, 14730 of Influenza A, 14628 Influenza B, 14697 RSV from ER and wards patients in an Hospital Centre between 01/2020-12/2022.
Patients demographic, clinical and laboratorial data collected from LIS. Laboratorial identification was performed by real time RT-PCR using reagents for Influenza, RSV and SARS-CoV-2 simultaneous detection in nasal aspirate and naso/oropharyngeal swab samples.
Results: The 14730 Influenza A tests were distributed: 3743 in 2020, 2508 in 2021 and 8479 in 2022, with 1304 positives, of which 25% detected in final 2022. The majority of positive cases, 35%, were detected in 18-64y followed by ≤ 5y, 22% in 3880 tests. ≥65y had the most tests, 4845 and 22% detected.
Concerning Influenza B, 14628 tests were performed and 228 were positive. 3780 were performed in 2020, 2512 in 2021 and 8336 in 2022. 6-18y had the least tests, 1779, but the majority of positives, 34%.
For RSV, 3771 tests were performed in 2020, 2529 in 2021 and 8397 in 2022, with a total of 14697 and 8% positive. From 358 positives during 2021, 41% were from summer months. The age group ≤5y had the majority of detected cases, 709 (54%) followed by ≥65y with 209 (24%). There was a slight prevalence of the male gender (51%) for Influenza A and RSV (53%) and female gender (55%) for Influenza B; mean age was 34, 22 and 30 years old, respectively.
Conclusions: Seasonal Influenza and RSV spreading declined markedly in 2020-21 after SARS-CoV-2 emerged but increased in 2021-22 likely due to applied measures during the pandemic. For Influenza A the majority of detected were in 18-64y and for Influenza B in 6-18y who have a low vaccination rate. RSV showed a rise in positive cases by June, July and August 2021 related to a breakthrouh in paediatric population. RSV burden in older patients was important; its surveillance must include adults mainly 65 years or older.
PO30
CHARACTERIZATION OF RSV AND INFLUENZA ATYPICAL DISTRIBUTION IN CENTRO HOSPITALAR TRÁS-OS-MONTES E ALTO DOURO PACIENTS – SEASON 2022/2023
Carlos Caldas1, Eliana Costa1, Carla Simões1, Marisa Castro1, Maria Martins1, Joana Pina1, Vera Ribeiro1, Rafael Vilamarim1
1 CHTMAD
Respiratory infections are a major global health problem. Respiratory Viruses (RV) are the most common causative agents of disease in humans, mainly in children and elderly, with significant impact on mortality and morbidity worldwide. Common respiratory agents from several virus families are well adapted to efficient person-to-person transmission and circulate in a global scale.
Our aim was determining the prevalence and distribution through time of RV present in patients who recurred to our hospital center with respiratory tract infections, between October 2022 and February 2023.
We studied the prevalence of RV in respiratory samples, between the 40th week of 2022 and the 7th week of 2023. A total of 18716 samples were tested and the detection of the viruses was performed by RT-PCR, using the Xpert®Xpress CoV-2 plus and Xpert®Xpress CoV-2/Flu/RSV plus (Cepheid); Liferiver Novel Coronavirus (Shanghai ZJ Bio-Tech Co., Lda); VIASURE SARS-CoV-2, Flu & RSV and Respiratory Panel I (CerTest Biotec, S.L.). Results were analysed using GraphPad Prism Software 6.0.
During this study, 4791 positive samples for RV were found, with predominance of Influenza (1738), SARS-CoV-2 (1407) and RSV (1131). Other RV (515) were represented mainly by hRV (249), AdV (68) and hEV (57). Coinfections were detected in 64 cases, 24 of these by Influenza virus and SARS-CoV-2.
The beginning of the season was later than usual (week 46) and we noticed a high prevalence of the two main vectors, Influenza and RSV, accompanied by the decline of SARS-CoV-2. On week 52, Influenza and RSV reached the peak of prevalence with 253 and 141 positive cases, respectively. Others RV were present during the whole season without a significant variation. We also noticed an unusual prevalence of RSV, especially among the population over 80 years old, which peak of infection was caused by this virus with 45 positive cases. RSV was also responsible by the higher number of positive cases in patients with age between 0 and 4 years old. For this range of ages, the season was characterized by the presence of two peaks, one in week 46 with 39 positive cases of RSV and another one in week 51 with 26 positive cases of Influenza.
The prevalence and distribution of RV is not linear in time, therefore the study of these factors on the population is crucial to better understand and prevent acute respiratory diseases.

PO31
CLOSTRIDIOIDES DIFFICILE INFECTION – IS THERE ANY CLINICAL DIFFERENCE BETWEEN DIAGNOSTIC METHODS?
Tiago Ramalho1, Carolina Silva1, Mafalda Felgueiras1, Isabel Neves1, Valquíria Alves1
1 Unidade Local de Saúde de Matosinhos
Background: Clostridioides difficile (CD) is the main cause of healthcare-associated diarrhoea in Europe. The rapid microbiologic diagnosis is made by two methodologies: immunochromatography (IC) and molecular biology (MB). Our main goal was to evaluate CD diagnostic flowchart in all positive cases in our laboratory and characterise the clinical manifestations and treatments that were used, according to infection risk factors (RF).
Materials and Methods: an unicentric, retrospective, observational study was carried out between January 2014 and December 2021, which included all patients with a positive toxin test. Each patient was characterised according to the diagnostic methodology (IC or MB) and flowchart: positive IC test (IC+) or negative IC test followed by positive MB test [IC-(=MB+)]. Severe disease criteria (leucocytosis, acute renal injury, hypoalbuminemia), RF described in literature, prescribed treatment and all-causes of mortality in that episode were also characterised. Categorical variables were described as absolute and relative frequencies. Statistical significance was set at 0.05 for all tests performed (SPSS®v.28.0.1).
Results: A total of 318 patients were included [53.5 % (n=170) IC+ and 46.5 % (n=148) BM+], of whom the majority were women (n=193; 60.7 %), with a median age of 75 years old.
IC+ patients were more likely to have severe disease criteria (OR MB+ = 0.80) (Table 1). Regarding RF, it was shown that recent hospitalization and chronic kidney disease increased the chance of infection in BM+ group (OR=1.28 and 1.29, respectively). Similarly, a positive tendency was verified for mortality (OR=1.55) for BM+ group (Table 2). However, none of the variables studied was significantly different between the IC+/BM+ groups.
Regarding treatment options, a shifting from metronidazole to vancomycin was shown: in 2014, 83% of cases were treated with metronidazole, whereas in 2021, 78% were treated with vancomycin (Figure 1).
Conclusions: This study showed no statistical difference between the two CD diagnostic methodologies, regarding patients’ clinical characteristics and risk factors. Thus, this diagnostic flowchart seems to be effective in identifying CD infections. Also, it showed that there was evidence that our centre accompanied the changes in the treatment guidelines.
PO32
ACCELERATE PHENO™ SYSTEM: COMPARISON OF THE IDENTIFICATION AND THE ANTIBIOTIC SUSCEPTIBILITY TEST RESULTS WITH A ROUTINE LABORATORY METHOD
José Sousa-Baptista1, Catarina Chaves2
1 1 Serviço de Patologia Clínica, Centro Hospitalar e Universitário de Coimbra, Coimbra, Portugal | 2 Instituto de Microbiologia, Faculdade de Medicina da Universidade de Coimbra, Coimbra, Portugal
2 1 Serviço de Patologia Clínica, Centro Hospitalar e Universitário de Coimbra, Coimbra, Portugal
Introduction: The rapid identification of the etiological agent of bloodstream infection and its antimicrobial susceptibility report culminates in a significant improvement of the clinical outcomes. Increasingly faster methodologies have been recently developed.
The Accelerate Pheno™ system is an example of an automated system that performs rapid identification of a panel of microorganisms frequently associated with bloodstream infections.
This system allows the reporting of identification in less than 90 minutes, and the results of antibiotic susceptibility tests in less than 7 hours, which represents a considerable gain compared to routine methodologies.
Objective: The aim of this study was to compare the results obtained by the Accelerate Pheno™ system with the results obtained by the routine methodology used in the clinical microbiology laboratory of the Centro Hospitalar e Universitário de Coimbra, regarding the identification and antimicrobial susceptibility testing results of gram-negative bacilli isolated from positive blood cultures.
Methods: A retrospective cohort study was performed involving blood cultures processed in the Accelerate Pheno™ system between September 2019 and December 2021 at Centro Hospitalar e Universitário de Coimbra.
Data were extracted from the laboratory information system and included: date of blood culture collection, microorganism identification, and interpretation of antibiotic susceptibility tests.
Blood cultures were incubated in the BacT/ALERT® Virtuo® automated system for a maximum of 5 days. After detecting a positive blood culture, the sample was processed, in parallel, according to the routine laboratory practices and according to the Accelerate Pheno™ system manufacturer’s instructions.
Results: 98.82% of pairs of observations (n=84) were concordant regarding the identification of the microorganism. The global discordance of the antimicrobial susceptibility testing interpretation was 0% for
Citrobacter spp.
(n=3), 5.88% for
Enterobacter spp.
(n=5), 6.67% for
Escherichia coli
(n=30), 9.22% for
Klebsiella spp.
(n=34), 6.45% for
Proteus spp.
(n=3), 16.36% for
Pseudomonas aeruginosa
(n=7), and 38.89% for
Serratia marcescens
(n=2).
Conclusions: Accelerate Pheno™ system allows an expedited results reporting with an acceptable overall disagreement.
PO33
INVASIVE INFECTION WITH FUSOBACTERIUM SPECIES
Mariana Sofia Pinto da Silva1, Amélia Afonso1, Ana Aguiar1, Fátima Silva1, Mónica Baptista1
1 Centro Hospitalar de Entre o Douro e Vouga
Introduction: Fusobacterium species (spp) are considered opportunistic pathogens in humans, in which they are a component of the normal microbiota of the oral cavity and the intestinal tract and they are able to produce abscesses and necrotizing infections such as pneumonia and brain infections.
The species of Fusobacterium seen most often in clinical infections are Fusibacterium nucleatum, Fusibacterium necrophotum, Fusobacterium mortiferum and Fusobacterium varium. Fusibacterium nucleatum predominates in clinical specimens and is often associated with oral, pulmonary and intracranial infections. They are frequently isolated from abscesses, obstetric and gynecologic infections, blood and wounds.
Case presentation: Man, 55 years, came to the emergency service with pain on the right knee, with 10 days of evolution. Due to hypertension and high lactate levels, he was transferred to the emergency room. Complementary diagnostic tests were performed, namely knee ultrasound, which reveals the presence of a thick liquid collection.He was observed by the orthopedics team, who considered that the patient met the criteria to go to surgery. Collects multiple tissue samples intraoperatively and bloodcultures for processing in microbiology lab. He was admitted to the intensive care unit postoperatively, with a diagnosis of septic shock with multiorgan dysfunction.
Discussion: Among the countless thousands of cases of human infection with non-spore-forming anaerobes, Fusobacterium necrophorum constitutes a tiny proportion (fewer than 1% of bacteremias), with only a few hundred case reports in the literature. However, it is arguably unique among the non-spore-forming anaerobes for its very strong association with clinically distinctive, severe septicemic infections.Although Fusibacterium spp is not an agent frequently implicated in orthopedic infections, this clinical case demonstrates that we should also think that it could be a case of osteomyelitis and skin infections.
PO34
VITEK 2 ADVANCED EXPERT SYSTEM (AES) AS A RAPID TOOL FOR REPORTING ANTIMICROBIAL SUSCEPTIBILITY TESTING IN E. COLI
Luis Morais1, Rui Figueiredo1, Afonso Santos1, Jóni Mota1, Paula Gama1, Carlos Cortes1
1 Centro Hospitalar do Médio Tejo
Introduction: Antimicrobial resistance (AMR) is a major global public health threat. Control measures are urgently needed to slow the trajectory of AMR but are vulnerable by an incomplete understanding of the interplay between pathogens, and AMR encoding genes. We analysed AMR profile and genetic resistance mechanisms associated using the Advanced Expert System (AES).
Methods: Samples were processed in Clinical Pathology Service, identified by Vitek 2.0 (BioMerieux) and Maldi-Tof (Bruker). There were analysed samples from 2018 to 2022 using N355 and 426 cards. AMR MICs were accessed by AES Vitek 2.0.
Results: A total of 8645 samples were analysed. The most E. coli analysed belong to urines (n=7400; 85.6%), and bloodstream infection (n=809; 9.4%). From all E. coli, 5287 (61.2%) were resistance to at least one antimicrobial agent tested. Overall, resistance to aminoglycosides were observed in 1236 (14.3%), conferred mainly by 942 (10.9%) of ant(2”) and 935 (10.8%) of aac(3)-I. These two genes were associated in 935 of E. coli isolates; there were reported in 927 isolates the genes aac(3)-I and aac(3)-II. In E. coli urine resistance mechanism more common were ant(2”) (n=808; 10.9%), and aac(3)-IV (n=808, 10.9%). In blood resistance mechanism more common were ant(2”) (n=97; 11.9%), and aac(3)-IV (n=97, 11.9%). Aminoglycosides resistance increased from 12.8% (n=166) in 2018 to 15.9% (n=313) in 2022. β-lactam resistance decreased from 60.4% (n=780) in 2018 to 55.8% (n=1092) in 2022. Resistance to β-lactam were observed in 4884 (56.5%), being the most common family genes identified the penicillases 2799 (32.4%). In urine resistance mechanism more common was acquired penicillases (n=2415; 32.6%), as well in blood (n=250; 30.9%). In urine isolates, nitrofurantoin (1.2-2.3%) and fosfomycin (2.8-3.1%) resistance was very low across the years. E. coli resistance to quinolones was identified in 2648 (39.7%) isolates.
Conclusions: Data analysed were accordingly AES Vitek 2.0, and should be improved with alternative molecular methods. There is the need for further research on the molecular epidemiology of antibiotic resistance genes in the study area to effectively control the spread of multidrug resistant pathogens. In addition, an effort to build the capacity of health professionals on infection prevention and control as well as diagnostic and antimicrobial stewardship needs urgent attention.
PO35
HAEMOPHILUS PARAINFLUENZAE BACTEREMIA IN A CHILD WITH RHEUMATIC VALVE DISEASE.
Joana Oliveira Costa1, Ana Catarina Dias1, Ana Maria Simões1, Virginia Martinez1, José Alves1, Isilda Carneiro1, Jorge Loureiro1
1 Centro Hospitalar Tondela Viseu
Introduction: Haemophilus parainfluenzae is a gram-negative coccobacillus, not capsulated, very common in the oral cavity, respiratory tract, and lower urinary tract. Despite low pathogenicity, occasionally it can cause systemic infections such as bacteremia, endocarditis, or osteomyelitis.
Case Description: An 8-year-old boy from a PALOP, with a past medical history of rheumatic valvular disease with severe congestive heart failure, presented to the pediatric emergency department displaying a 1-day history of fever, nausea, and diarrhea. The mother denied that he had any acute respiratory disease or other symptoms.
On admission, his temperature was 38.6ºC and bloodwork revealed leukocytosis (21,9*109/L) with neutrophilia (85%), hyponatremia (Na 131 mEq/L) and elevated C-reactive protein (15,20 mg/dL) and procalcitonin (15,28 ng/dL). Blood, urine, and stool cultures were drawn, and the patient was started on empiric antibiotic therapy with ceftriaxone. Only the blood cultures returned positive for Haemophilus parainfluenzae (that was also confirmed by the National Institute of Health, Dr. Ricardo Jorge). Susceptibility to antimicrobial agents was determined and confirmed for ceftriaxone, which was continued for a total of 10 days. Due to the high suspicion of infective endocarditis, an echocardiographic control was performed which did not show any alterations. After a few days of antibiotic therapy, our patient’s fever and clinical symptoms resolved and the analytics normalized.
Discussion: Haemophilus parainfluenzae is a commensal microorganism that resides in the upper respiratory tract and oropharynx that rarely causes systemic disease. Requires factor V (NAD) as a substrate for growth and a specific laboratory medium, such as chocolate agar.
In our clinical case, it was not possible to determine the origin of the systemic infection. According to some authors, Haemophilus parainfluenzae can colonize the intestinal mucosa due to the presence of factor V in the duodenum, and by mucosal damage, reach the bloodstream.
As Haemophilus parainfluenzae can be a possible etiologic cause of infective endocarditis, both in adults and children especially in those with known heart disease, it requires high clinical suspicion and prompt identification for accurate treatment.
PO36
S. GALLOLYTICUS (S. BOVIS) BACTEREMIA – A CLINICAL CASE
Cláudia Lopes1, Fernanda Tomé1, Hugo Sousa1, Mariana Pinto Silva1, Maria Amélia Afonso1, Maria Fátima Silva1, Ana Cristina Silva1
1 Centro Hospitalar Entre Douro e Vouga
Introduction: Streptococcus gallolyticus (formerly S. bovis) is a clinically important species included in group D streptococci (mainly present in the intestinal flora of vertebrates).
It causes bacteremia, meningitis and endocarditis (in native or prosthetic valves), with an important correlation with colorectal carcinoma.
Penicillin remains highly active against most strains of S. gallolyticus, although occasional isolates may show decreased susceptibility.
Clinical case: We present the case of an 80-year-old woman with a history of valvular heart disease (with a mechanical mitral valve), heart failure, permanent atrial fibrillation (with a pacemaker), interstitial lung disease and multiple hospitalizations due to respiratory infections.
She resorted to the Emergency Service of Centro Hospitalar Entre Douro e Vouga due to severe dyspnoea. On the admission, she showed respiratory distress, tachycardia and fever. The analytical study showed leukocytosis with neutrophilia, elevation of C-reactive protein and NT-proBNP, without other relevant changes. Chest X-ray showed a greatly increased cardio-thoracic index, congestive pattern and parahilar reinforcement. It was assumed decompensated heart failure due to acute bronchitis, she was hospitalized and empirical antibiotics were started: amoxicillin + clavulanic acid (A + CA) and azithromycin.
In the set of blood cultures (BC) collected on admission, multisensitive S. gallolyticus was isolated. A transesophageal echocardiogram was performed, which excluded endocarditis and the reassessment BC were negative.
After had completed 10 days of A + CA, having shown a good response with a sustained decrease in inflammatory parameters, she was discharged with indication to end antibiotic therapy and perform an outpatient colonoscopy. Follow-up in Internal Medicine Consultation was settled.
Discussion: In this case, the presentation frame pointed to a respiratory infection, but decompensated heart failure due to S. gallolyticus bacteremia is postulated.
The patient’s history of valvular heart disease constitutes an alert for endocarditis, which was ruled out.
Given the association between S. gallolyticus bacteraemia and colorectal neoplasms, patients presenting with these condition should undergo a colonoscopy, which was considered.
PO37
HEPATITIS A: ULTRASENSITIVE ENZYME-LINKED FLUORESCENCE ASSAY IN OCCASIONAL DETECTION OF PRIOR CONTACT IN A MEDICO-LEGAL SAMPLE IN LISBON
Vânia Mofreita1, Laura Cainé2, Joana Rodrigues1, Rui Nascimento3, Olena Mukan1, Jennifer Fadoni1, Francisco Corte Real4, António Amorim5
1 Instituto Nacional de Medicina Legal e Ciências Forenses
2 Faculdade de Medicina da Universidade do Porto
3 Faculdade de Ciências e Tecnologia da Universidade de Coimbra
4 Faculdade de Medicina da Universidade de Coimbra
5 Faculdade de Ciências da Universidade de Lisboa
Introduction: Hepatitis A virus (HAV) continues to be a public health issue worldwide . HAV infection is caused by the hepatitis A vírus and transmission occur mainly via the fecal-oral route . The level of endemicity of this virus can be determined by the prevalence of total antibodies directed against HAV (anti-HAVtotal) in the adult population . Due to the improvement of socioeconomic and sanitary conditions and vaccination, Portugal has become a country in transition from endemicity: from high to intermediate.
Material and Methods: From 43 individuals involved in medico-legal expertise, between 2021 and 2022, in the Lisbon region, carried out by the medico-legal services in that region, blood was collected with informed consent whenever applicable and and a VIDAS® Anti-HAV Total enzyme immunoassay was carried out. PORDATA was used to understand the constitution of the Portuguese population at that time. Anti-HAVtotal laboratory results greater or equal than 15 mUL/mL were considered seropositive, revealing previous infection or vaccination.
Results and Conclusions: Females represented 65.12%. Most were aged between 55 and 64 years (32.56%). The Portuguese population also reflected a higher incidence of females (52.43%), but aged over 64 years (23.50%). The prevalence of anti-HAVtotal was 60.47%, with emphasis on females (53.85%) and age groups aged over 54 years (46.15% and 34.61%, between 55 and 64 years and over 64 years, respectively). These results are only indicative, therefore have no statistical statistical significance as they result from a convenience sample in which it was not yet possible for us to determine the presence of IgG. Seropositivity comprised 60.47%. The analysis of these results reveals that the lowest proportion of seropositivity was concentrated in younger people, reaching higher values at ages over 54 years, corroborating what was described in the National Serological Survey, as well as the fact that the seropositivity rate does not present significant differences between female and male, in the different age groups. Since vaccination is not mandatory and due to the low rate of the vaccinated population, it is presumed that the majority of seropositive individuals are a reflection of previous HAV infection, mainly in the presence of IgG. Thus, it will be interesting to study anti-HAV IgM antibodies in that population, to understand prior exposure to the virus – as a result of infection or vaccination.
PO38
B HEPATITIS - TWO CASES OF ATYPICAL SEROLOGIC PROFILES
Cláudia Lopes1, Catarina Sousa Neves1, Luísa Almeida1
1 Centro Hospitalar Entre Douro e Vouga
Introduction: Hepatitis B virus (HBV) is a hepatotrophic virus and the laboratory has the most important role in the diagnosis, confirmation and notification of its infection. When assessing the serological and virological status, atypical profiles of discrepant and inconclusive viral markers may appear in our laboratory routine.
Cases description:
Case 1 – a pregnant woman in the third trimester tested positive for HBsAg and Anti-HBs with an undetected molecular hepatitis B load. There was no past history of hepatitis B infection. The fact that Anti-HB core was negative allows us to think that the patient has not been in contact with the virus and that positive Anti-HBs came from vaccination. In pregnant women, false positive HBsAg are frequent but this lack of specificity usually translates into a lower sample/cutoff value. The confirmatory HBsAg test (not available in our laboratory) would have been important for us to conclude if this was a false positive as we suspected. Meanwhile the patient was referred to gastroenterology and remains in follow-up with requested HBsAg determinations but without any treatment as there were no signs of viral replication.
Case 2 – an 88-year-old woman with very low platelets and suspected idiopathic immune thrombocytopenia. This patient was not vaccinated for B Hepatitis. Two days before treatment with platelet pool and corticotherapy, she tested negative for anti-HBs and HBsAg and had a positive Anti-HB core, however after this treatment, she tested positive for AntiHBs, Anti-HB core and Anti-HBe. A new sample was requested for confirmation and all tests confirmed the same results. We tested for molecular DNA marker to clarify a possible occult infection with undetectable HbsAg but the result was undetectable viral load. No past history of this patient explained the results obtained and no literature explained its possible relevance. It is unclear where this positive anti-HBs came from. A possible action would be notification of blood transfusion center and further investigation in the next blood collection of this patient. A new blood marker that is now in the market that could help us in this situation is HBsAg quantitative test.
Discussion: It is of utterly importance to reflect on the kinetics of viral markers in the light of the new knowledge that has been developed regarding HBV infection.
PO39
BURKHOLDERIA CEPACIA COMPLEX: A RARE PERITONITIS CASE REPORT
Márcia Tavares1, Isabel Pereira1, Marta Nicolau1, António Carvalho Mendes1, Cláudia Ferreira1
1 Unidade Local de Saúde do Baixo Alentejo
Introduction: Burkholderia cepacia complex (BCC) is a group of at least 21 closely related bacterial species.
BCC is a non-glucose fermenter aerobic Gram-negative bacillus commonly found in soil and water. These opportunistic pathogens are associated to cystic fibrosis and immunocompromised patients and very rarely reported to cause community acquired peritonitis.
Case Report: We describe the case of an 87 year old woman, with comorbidities (asthma and heart valve disease) presented to the emergency department with worsening symptoms of dyspnoea, hypotension and enlarged and painful abdomen. Relevant clinical findings were leucocytosis with neutrophilia and protein C reactive of 49 mg/dL. A CT scan revealed pneumoperitoneum with moderate quantity of free fluid suggestive of bowel perforation. Patient was put on piperacillin/tazobactam empirically and referred to urgent laparotomy. Peritoneal fluid was collected for microbiological culture identification (ID) and antimicrobial susceptibility testing (AST) and a diagnosis of peritonitis with septic shock secondary to duodenal ulcer perforation was established.
The peritoneal fluid culture performed with VITEK®2 (bioMérieux) identified BCC.
There are no breakpoints interpretation in the EUCAST, so manual AST was performed with disk diffusion for the antibiotics: meropenem, ceftazidime and trimethoprim-sulfamethoxazole (TMP-SMX). Breakpoints were interpreted with CLSI criteria.
AST revealed resistance to ceftazidime and meropenem and susceptibility to TMP-SMX.
Admitted to the ICU the patient´s clinical condition worsened with refractory septic shock. Once the BCC was identified the clinician switch to meropenem according to the literature. Blood cultures were also positive for BCC at this time.
After obtaining AST result, directed antimicrobial therapy with TMP-SMX was selected.
Despite directing antimicrobial therapy the patient died due to refractory septic shock with multiorgan failure.
Discussion: This rare presentation of BCC infection highlights the essential laboratorial collaboration with clinicians to guide decision making.
It is important to gather more evidence and harmonize orientations as BCC infection exhibits high intrinsic antibiotic resistance and in this special case also presented an acquired resistance to meropenem, which contribute to the dire outcome.
PO40
MYELIN OLIGODENDROCYTE GLYCOPROTEIN ANTIBODY-ASSOCIATED DISEASE: CASUISTRY OF A TERTIARY HOSPITAL CENTER
Luís Roseta1, Joana Oliveira Costa2, Alice Mendes1, Ângela Maresch1, Rosário Cunha1, Fernando Rodrigues1
1 Centro Hospitalar e Universitário de Coimbra
2 Centro Hospitalar Tondela-Viseu
Introduction: Myelin-oligodendrocyte glycoprotein antibody (MOG)-IgG-associated disease (MOGAD) is a recently described autoimmune-mediated inflammatory demyelinating disease of the central nervous system.
The clinical manifestations of MOGAD are heterogeneous, typically manifested as acute disseminated encephalomyelitis (ADEM), optic neuritis (ON), transverse myelitis (TM) or encephalitis.
In patients with MOGAD-compatible clinical-MRI phenotypes, the diagnosis is confirmed by the detection of serum MOG-IgG antibodies (Ab).
We aimed to compare the clinical, laboratorial and demographic data between our study population and the literature. For that purpose, we made a retrospective evaluation of clinical and laboratory data of adults and children with suspected MOG-IgG [Indirect Immunofluorescence in cell-based assays (Euroimmun®)], over a period of 4 years (YO) and 3 months.
Results: A total of 889 MOG-IgG tests were carried out mostly in adults (93%) and requested by the Neurology Service (91%), with positive results in 77 of these tests (9%). These positive results corresponded to 50 patients, female/male ratio 1:1 and with a median age of 32 YO (38 vs 27.5 for female vs male). 26% of these patients were children.
Pediatric MOG-IgG positive patients mostly manifested as ADEM (58%) or encephalitis (17%). Adults presented with ON (59%), optic neuromyelitis (17%) or TM (10%).
40% of the positive MOG-IgG tests had a titer of 1:10, 29% 1:32 and 31% a titer ≥1:100.
9 patients with positive MOG-IgG tests were not diagnosed with MOGAD, being mostly adults (88.9%), of which 56% had a titer of 1:10 and 33% a titer of 1:32.
Discussion: Most positive results for the MOG-IgG test support and confirm the clinical and imaging diagnosis of MOGAD.
MOG-IgG positive patients had a female/male ratio identical to that described in the literature. Regarding the older than expected age (MOGAD is more frequent in children) we suspect that this is due to the detection of MOG-IgG Ab having been started recently in our laboratory.
As described in the literature, pediatric MOGAD patients often manifested as ADEM, while adult patients usually present with ON.
Most of the patients with a positive MOG-IgG test but without a diagnosis of MOGAD had a low titer, so it is assumed that those might be false positive results.
PO41
QUALITY INDICATORS FOR THE PREANALYTICAL PHASE – WHERE DO WE STAND? EXAMPLE OF A PORTUGUESE CENTRAL HOSPITAL
Paula Leal1, Alcina Mateus1, Ângela Maresch1, Teresa Reis1, Eulália Costa1, Fernando Rodrigues1
1 Serviço de Patologia Clínica do Centro Hospitalar e Universitário de Coimbra
Introduction: Laboratory results play a key role in medical health associated decisions and, because of that, trustful is need. Quality and error detection are fundamental priorities. The majority of laboratory errors occur in the preanalytical phase, where most process steps occur outside the laboratory, with samples handled by a variety of professionals. Haemolytic samples are described as the most burdensome and most frequent problem but other errors occur. The definition, implementation and monitoring of valuable quality specifications and indicators (QIs) is of the essence. In order to promote the harmonized use of QIs and reduce errors in laboratory testing, the International Federation of Clinical Chemistry and Laboratory Medicine (IFCC) Working Group on ‘‘Laboratory Errors and Patient Safety’’ (WG-LEPS) developed a project on QIs.
Objective: The aim of the study was to determine some preanalytical phase QIs from our laboratory and to compare obtained data according to the desired quality specifications values proposed by IFCC WG-LEPS.
Materials and methods: Evaluation of the number of rejected samples, using the laboratory information system - Clinidata® and the national preanalytical external quality assessment program, according to the QIs of the IFCC WG-LEPS (clotted: Pre-Clot; haemolysed: Pre-HemR; lipemic; insufficient volume: Pre-InsV), during one year (2022).
Results: A total of 1.888.175 samples were studied. Clotted and haemolysed had the highest mean values for rejection: 0,31% and 0,21%, respectively. Insufficient volume had 0,03% and lipemic had <0,01%. Compared to the IFCC WG-LEPS QIs goals, Pre-Clot QI was unacceptable; Pre-HemR and Pre-InsV QIs were acceptable. Lipemic samples were residual.
Conclusions: Despite of the Pre-Clot QIs, the others showed good concordance with the goals, suggesting that some action is still needed. In fact, quality improvement is now a part of the daily routine for laboratory professionals, but quality cannot be improved without being measured nor without standardization of sample rejection criteria and data collection methods. The QIs of the preanalytical phase are essential tools that contribute to improving the quality of laboratory medicine and patient safety.
PO42
HEAVY/LIGHT CHAINS ASSAY FOR THE DIAGNOSIS AND FOLLOW-UP OF MONOCLONAL GAMMOPATHIES
Maria Manuela Rebordão1, Sara Batalha1, Sandra Francisco1, Maria José Bailão1
1 HFAR
Monoclonal gammopathies (MG) require precise analysis of the monoclonal component (MC) as well as other immunoglobulins (Ig) isotypes, which might be limited by the sensitivity of standard laboratory methods. The heavy/light chain assay enables individual identification and quantification of chain pairs of IgG, IgA and IgM. They measure both the involved (clonal) and the uninvolved (non-clonal) Ig giving prognostic information about immune suppression of the uninvolved Ig isotype.
Aim: To determine the performance of heavy/light chain assay, in the study of MG patients at different stages.
Materials and methods: We studied 22 patients with a median age 74.2 years; 15 were men (68,1%); 17 patients (7IgGκ, 6IgGλ, 4IgAκ) had a MG of undetermined significance (MGUS) and 5 patients (2 IgGκ, 2 IgGλ and 1 IgAκ) had multiple myeloma (MM). Freelite and Hevylite (The Binding Site Group Ltd.) assays were used for FLC determination and HLC isotype quantification, respectively. Proteinogram (EPS) and serum immunotyping were used to quantify and characterize MC, by capillary electrophoresis (Capillarys 3-Sebia). Total IgA, IgG and IgM were determined by turbidimetry (Roche Diagnostics).
Results: An abnormal HLC-pair ratio was detected in 52,9% and 60% of MGUS and MM patients, respectively, but the frequency differed depending on the isotype. Patients with IgG MC presented with an abnormal HLC-pair ratio in only 38,5% of cases, whereas all IgA MGUS had abnormal HLC-ratios. In this last group the FLC is abnormal in 50%. Abnormal HLC-pair ratios were common in the IgA MGUS even at low MC concentrations. HLC-pair suppression was observed in 50% of the IgA MGUS and 23% of IgG. Only 17,6% of total Ig suppression was observed despite the good correlation between HLC-pair sum and total Ig(R2=0,91). There was also a good correlation between the M-spike size and the HLC quantification (R2=0.99)
Discussion: HLC assay helps to quantify the MC not suffering interference from other proteins as observed in EPS. This technique has a promising potential because it enables to assess the concentration and ratio of the levels of both tumour and polyclonal Ig (HLC pair suppression) which is not possible with EPS and total Ig quantification.
PO43
PROCALCITONIN: WHEN NOT TO ASK?
Carlos Miranda Costa1, Ana Catarina Monteiro1, Ramona Bindean1, Rosário Luís1
1 Hospital Distrital de Santarém
Introduction: Procalcitonin (PCT), C-reactive protein (CRP), neutrophile count, and neutrophile/lymphocyte ratio (NLR) are indicators of infection useful in the diagnosis, antibiotic therapeutic monitoring, and prognosis of patients with infectious diseases. Since the SARS-CoV-2 pandemic, there has been a substantial increase in the PCT tests. The present study focuses on the cost-benefit and relevance of PCT testing in the emergency department (ED).
Purpose: To verify the need of PCT testing considering other infection markers on an ED setting.
Materials and Methods: 19883 episodes of 2022, with PCT and CRP tests, neutrophile and lymphocyte counts. After selecting the adults, 8724 ED episodes were obtained. We evaluated the correlation between PCT and CRP, and NLR. We categorized PCT into PCT<0.5, 0.5-2 and ≥2 ng/ml, according to the risk of sepsis. We considered NLR normal between 1-3, and the neutrophil count between 1.5-7x109/L. CRP was categorized into <5 (<2 and 2-5) and >5 mg/L. All the values are consistent with the laboratory methods. Using Microsoft Excel®, Spearman’s rank correlations were calculated and data was analysed according to the categories above.
Results: Correlation between PCT/CRP is strong (rs=0.698) and moderate for PCT/NLR (rs= 0.497).
Analyzing the 8724 episodes, according to the defined categories:
Of the 2765 with CRP>5, 16.8% have PCT>2; Of the 6174 with NLR >3 or <1, 8,7% have PCT>2; Of the 2480 with both previous conditions, 18% have PCT>2;
When PCR<5 and normal NLR, 2266 episodes were selected: 99% have PCT<0.5; 0,7% have PCT between 0.5 and 2; 0,3 have PCT>2, 5 of which have neutropenia.
Conclusions: CRP is a better predictor for PCT than NLR.
We detected 16.8% of the PCT>2 resorting to CRP>5 but only 8.7% resorting to NLR>3 or <1. Using both we increase the detection to 18%.
If only one indicator is positive, the probability of higher PCT increases with higher values of CRP.
If CRP<5 and normal NLR, we figure that the probability of PCT>2 is very low (0.3%). Therefore, 26.0% of the 8724 PCT was unnecessarily determined. Hence it is important to sensitize clinicians in the ED not request the PCT test by default. Only 13.3% of the 8724 tests had a PCT>0.5, and 6.5% a PCT>2.
Clinical evaluation together with assessment of parameters such as CRP, NRL and neutropenia avoids unnecessary PCT testing, leading to a more rational use of resources.

PO44
EFFECTS ON POPULATION IMMUNITY AFTER PANDEMIC: EVIDENCE FROM C3 AND C4 SERUM LEVELS
Luis Miguel Lopes Martinho1, Ana Cristina Salgado Silva1, Preciosa Maria Teixeira Sousa1, Mara Rodrigues1, Anabela Rodrigues1, Eliana Costa1
1 Centro Hospitalar de Trás-os-Montes e Alto Douro
Background: The complement system was discovered at the end of the XIXth century as a thermolabile plasma component, which “complemented” the effect of antibodies against microbes1. The role of the complement system and its contribution to the seriousness of infectious diseases are widely recognized2-4.
The activation of the complement system in COVID19 patients has been mostly monitored through the quantification of the C3 and C4 serum levels. This disease reached pandemic levels and strongly affected the immune system and impaired specific components of the complement system. The decrease of C3 and C4 decreased the immune responses to infection and vaccination resulting in increased risk of infections and severity of diseases5-7.
Objective: Evaluate the variation of populational serum C3 and C4 levels before, during and after the pandemic.
Materials and Methods: We carried out a retrospective study of C3 and C4 serum levels over the course of 5 years. The populational data was divided in pre-pandemic (2018 and 2019), during pandemic (2020 and 2021) and post-pandemic (2022). We analysed the serum levels of C3 and C4 in patients admitted to our Hospital. We analyzed a total of 19428 serum qualifications. The T-TEST was used to compare the significance of the results obtained. The analytical method used was immunoturbidimetric using the cobas c 702 module chemistry analyzer.
Results: Our analysis of the changes in C3 and C4 before, during and after the pandemic suggest that C3 serum levels remain constant throughout the studied period and whereas C4 levels reached a minimum mean value during the pandemic.
Discussion / Conclusion: The fluctuations in C4 serum levels suggest that the complement pathway may have been compromised more downstream of the activation cascade since C3 its main upstream activator doesn’t significantly change over the time of this study. We hypothesize that during the pandemic period the decreases in C4 serum levels were caused by the viral infection and/or vaccination and the possible result of isolation, which combined could affect the immune system. The C4 defect and deficiency that occurred during the pandemic period coursed in parallel with fulminant clinical cases of oncological, hematological, rheumatological and respiratory diseases. It is currently verified that the values of C4 are in a replacement phase. This study will enable clinicians to make earlier diagnoses and control pre-existing diseases.
PO45
PERSISTENCE OF ELEVATED PROCALCITONIN A PATIENT WITH A NEUROENDOCRINE TUMOUR – A CASE REPORT
José Pereira1, Mylene Costa1, Nuno Gonçalves1, Anabela Leão1
1 Serviço de Patologia Clínica, Instituto Português de Oncologia do Porto Francisco Gentil, EPE
Case Report: In this case we present a female patient, 74 years old, diagnosed with a well-differentiated rectum neuroendocrine tumour (NET) in 2022, that was hospitalized due to complicated pyelonephritis in the context of urosepsis with multiorgan dysfunction, with probable starting point on an extensive enterovaginal fistula.
During hospitalization, antibiotic therapy was provided, and a bilateral percutaneous nephrostomy was performed, with a favorable clinical response. Blood cultures were negative throughout the hospital stay, and urine culture became negative after directed antibiotic therapy. Analytically, it was observable a decrease on leucocyte count, a great decrease in C Reactive Protein value (from 191 mg/L to 13,5 mg/L) but procalcitonin levels were persistently increased, with a value of 30 ng/dL by the end of the hospitalization. With this, calcitonin was measured, revealing an increased value of 454 pg/mL. Thyroid parameters were normal, with T3 value slightly decreased, and thyroid echography was also normal.
Discussion: Neuroendocrine neoplasms range from indolent well-differentiated tumors to very aggressive poorly differentiated neuroendocrine carcinomas. NETs often express peptides or amines, among which insulin, gastrin, and serotonin are the most frequently encountered.
Procalcitonin is mainly expressed in thyroid C cells and is subsequently cleaved by a convertase enzyme to generate calcitonin. Calcitonin is most frequently reported as a highly sensitive biomarker for medullary thyroid carcinoma, but it lacks on specificity. Calcitonin can be increased due to hyperparathyroidism, hypergastrinemia, renal insufficiency, pharmacological causes or even calcitonin secreting NETs. Calcitonin secreting NETs are a rare entity. According to literature, high calcitonin NETs are mostly from foregut origin (pancreas and lung) and with high grades.
Further study is required to fully understand the cause of the increased calcitonin for this case, but our goal is to remind that high calcitonin levels are not pathognomonic for medullary thyroid carcinoma, and can be caused for various reasons. Besides this, it is of value to keep in mind that, although rarely, it is described that inappropriate calcitonin release may occur in NETs.
PO46
EXTERNAL QUALITY ASSESSMENT IN LABORATORY SAFETY AREA (PNAEQ-1S SEGURANÇA LABORATORIAL 2023)
Catarina Susana Gomes Ventura1, Ana Luísa Lopes Cardoso1, Ana Filipa Pires1, Ana Paula Faria1
1 Instituto Nacional de Saúde Doutor Ricardo Jorge
Introduction: The National External Quality Assessment Program (PNAEQ) provides tools for carrying out external quality assessment in Laboratory Safety area. These tools allow the identification of occurrences and/or critical points in the operation, installations or equipment, that could have impact on the safety of patients and workers, beyond prioritize the necessary improvement actions.
Objective: Presentation of the methodology implemented in PNAEQ in 2023, for the External Quality Assessment (EQA) in Laboratory Safety area.
Description: For 2023 PNAEQ catalogue includes a scheme of External Quality Assessment, named PNAEQ-1S Segurança Laboratorial, with 3 exercises:
1. Monitoring Indicators: The participants collect data to a response form, every six months, from safety indicators previously defined by the PNAEQ, related to: accidents/incidents with patients; accidents/incidents with staff; occurrences with equipment; prevention exercises and laboratory Bioprotection. In the end of each semester, the participants send the response form to PNAEQ, which analyse all data and prepare general and individual reports, for each participant.
2. Internal audit: PNAEQ distributes a checklist to the participants to be used in an audit that is carried out by the participants themselves. The areas included are: laboratory facilities and working conditions; storage, packaging and transport; risk identification; incidents, injuries, accidents and occupational diseases; workers health and safety; laboratory equipment; waste treatment; fire prevention and risk assessment in the context of biological safety.
After participants submit the results, PNAEQ analyse it and prepare general and individual reports, for each participant.
3. Case-Study: The participants are invited to answer multiple-choice questions, based on photographs that illustrate some laboratory situations, through an online questionnaire. After submitting results, PNAEQ analyse the results and prepare general and individual reports, for each participant.
Discussion: Participation in this AEQ scheme, when carried out periodically, allows the implementation of preventive and/or corrective actions to eliminate and/or reduce the causes of occurrences, sharing of knowledge, and establishing and maintaining a safe working environment for workers, patients and visitors.
PO47
MAGNESIUM AND PHOSPHOCALCIUM METABOLISM EVALUATION IN TYPE 2 DIABETIC PATIENTS BEFORE RENAL FAILURE; DOES IT HELP TO PREVENT BONE FRAGILITY?
Cristina de Mello-Sampayo1, Inês Stilwell2, Sandra Nóbrega2, Maria Cristina Marques3
1 1. Departamento Farmácia, Farmacologia e Tecnologias em Saúde da Faculdade de Farmácia da Universidade de Lisboa, 2 Research Institute for Medicines (iMed.ULisboa), Faculty of Pharmacy, Universidade de Lisboa
2 Clínica Cintramédica, Sintra, Portugal
3 1. Departamento Farmácia, Farmacologia e Tecnologias em Saúde da Faculdade de Farmácia da Universidade de Lisboa. 2. Clínica Cintramédica, Sintra, Portugal
Many type 2 diabetic patients (DM2) have hypercalciuria, which can worsen osteodystrophy and increase the risk of bone fractures. The pathophysiological mechanism leading to the hypercalciuria observed in DM has yet to be established. Aim: evaluate changes in magnesemia and phosphocalcic metabolism in DM2 patients with and without Renal Failure (RF).
Serum calcium, magnesium, phosphate, PTH, 25(OH)D, creatinine and calciurias, phosphaturias and creatinurias were evaluated by standardized biochemical methods in both genders, aged 71±10 years, with or without DM2. The GFR was calculated from serum creatinine and MDRD equation, and estimated the fraction of Ca excreted. Each DM/NDM group was further stratified according to GFR (60 ml/min/1.73 m2). Data were compared between groups, using parametric tests, considering p<0.05.
The results (n=261) reveal a higher Ca excretion fraction in DM associated to a decrease in phosphaturia and magnesemia compared to NDM patients (p<0.05). Following stratification according to GFR, the fraction of Ca excretion was lower in the RF groups (p<0.05) whereas in non-RF DM patients it was higher (p<0.05). In RF, phosphaturia decreases to identical values in both DM and NDM but is already reduced (p<0.05) in non-RF DM. Magnesemia in DM patients is reduced, being significant in the absence of RF (p<0.005). PTH is identical for DM and NDM. Phosphataemia is identical in all subgroups. The prevalence of vit-D scarcity is very high in non-RF DM.
These results confirm the existence of hypercalciuria in DM2 patients even before compromised renal function. The occurrence of hypercalciuria, hypomagnesemia and hypophosphaturia in DM2 patients without RF, and the high vit-D scarcity, may contribute to bone fragility in these patients. Considering the relevance of Mg ion in bone metabolism, these results signal the relevance of its monitorization, but also phosphate and Ca excretion in DM2 patients even before the occurrence of RF.
PO48
SPURIOUS HYPERPHOSPHATEMIA IN A PATIENT WITH MULTIPLE MYELOMA - A PHENOMENON TO REMEMBER.
Mylene Costa1, José Duarte Pereira1, Nuno Gonçalves1, Anabela Leão1, Gabriela Martins1
1 IPO Porto
Pseudo-hyperphosphatemia is a laboratory artifact characterized by falsely elevated serum phosphate, usually due to paraprotein interference on the conventional automated analyzer.
We present a case report of a 59-year-old female patient with history of thyroid papillary carcinoma (total thyroidectomy 7 years ago), cardiovascular risk factors and carpal tunnel syndrome. The patient was diagnosed with Multiple Myeloma (MM) IgG/Kappa, in 2022 and was treated with bortezomib + talidomide + dexamethasone followed by autologous stem cell transplantation and bortezomib maintenance, with good partial response. One year later, progression of the disease was documented out of a new onset of anemia and increased monoclonal peak on protein electrophoresis. A new cycle of treatment with daratumumab + bortezomib + dexamethasone was proposed. The patient remained asymptomatic, with normal physical and neurological examination. Laboratory results showed severe hyperphosphatemia (2,34mmol/L), with normal calcium and renal function. She had no history of laxative abuse, and her chronic medication include acyclovir, cotrimoxazole, insulin, pravastatin, indapamide, pregabalin, levothyroxine and folic acid supplementation. Since clinical manifestation of hyperphosphatemia (eg. seizure or tetany), renal impairment, cell lysis, hypoparathyroidism, excessive vitamin D or phosphate administration were absent, spurious laboratory result due to hyperproteinemia interference was hypothesized. To decrease the serum paraprotein concentrations, the original serum sample was diluted, and the serum phosphate then obtained was between the reference range (1,86mmol/L).
Precipitation of monoclonal immunoglobulin in an acidic reagent increases serum turbidity and optical density, leading to enhanced UV absorvance that can cause falsely high serum phosphate level. It is known that IgG/kappa monoclonal gammopathy is more associated to this spurious result, since IgG has a lower carbohydrate content so it can produce larger amounts of protein precipitation.
Clinicians should be aware of this phenomenon and take necessary actions to avoid misdiagnosis, including dilution or protein precipitation, that can prevent unnecessary therapy and potentially reveal the diagnosis of paraproteinemia, especially related to MM.
PO49
THE CLINICAL VALUE OF THE DOSAGE OF TUMOR MARKERS CA125 AND HE4
Cristiana Maria Queirós Teixeira da Silva Alves1, Mara Pitrez Ferreira1, Beatriz Ribeiro1, José António Carvalho1, Eliana Costa1
1 Centro Hospitalar de Trás-os-Montes e Alto Douro
Background: Ovarian cancer is the gynecological tumor with the highest associated mortality in developed countries1. It affects premenopausal and menopausal women, being about 54 years the average age at diagnosis2. Due to sensitivity and specificity limitations, there was a need to identify biochemical markers that would allow detecting this type of neoplasm still in its incipient phase3.The combined dosing of Ca125 and He4 can help in the differential diagnosis, benign vs. malignant, of a pelvic mass, either in the pre or postmenopausal stage4. The algorithm of these two tumor markers conjugated, is a more assertive indicator of probable malignant disease5.
Objective: To evaluate the clinical usefulness of serum Ca125 and He4 measurement. To correlate the values of Ca125 and He4 in postmenopausal women and in women with oncologic pathology.
Materials and Methods: Retrospective study, in the period from 2018 to 2022. It included 6019 samples from female patients aged 55 years or older. Ca125 and He4 were simultaneously assayed in all samples. The analytical method used was electrochemiluminescence immunoassay (ECLIA) in the Cobas E801 immunoensay Analyser Roche®.
Statistical analysis was performed with the T-TEST.
Results: There was a significant difference in the value of Ca125 and He4 in women of childbearing age and women with oncologic pathology (P=<0.05).
Discussion/conclusion: There is a significant difference in Ca125 values in women of childbearing age compared to menopausal women, and there is a strong probability that the high levels of Ca125 are a consequence of changes associated with menopause per se. We can also mention that high Ca125 levels in premenopausal women may be associated with uterine fibroids. Regarding the values of He4, there was a decrease with age and an increase was observed in women in the fertile period and in oncologic patients. With the study carried out at our Hospital Centre, we may conclude that both age and menopause are factors that influence He4 levels in healthy women.
PO50
INCIDENCE OF RESPIRATORY VIRUS IN A PEDIATRIC POPULATION, DURING AND POST PANDEMIC ALERT STATE
Sara Oliveira1, Carlos Gonçalves1, Jorge Vilaça1, Mariana Faísca1, Vera Martins1
1 Hospital de Braga
Objectives: To assess the incidence of respiratory viruses, with exception of SarsCov2, in a pediatric population, during and after the pandemic alert period, concerning the Hospital de Braga.
Material and methods: In this retrospective study were used samples of nasopharyngeal swabs, bronchoalveolar lavages and/or sputum, from patients within the ages of 0 to 18 years-old. These patients were admitted to Hospital de Braga with suggestive clinical condition of respiratory infection, for the period of March 2020 until February 2023. The results of this investigation were obtained through an immunometric antigen detection principle analysis or Real-time polymerase reaction (RT-PCR) analysis, and attained by consulting pre-existing records in the Maxdata software. The treatment and systematization of all the data obtained was carried out in the JASP software.
Results and conclusion: This investigation allowed to demonstrate that the incidence of respiratory infections of viral etiology, significantly increased throughout the subsequent months following the alert status period of the SarsCov2 pandemic. By a thorough analysis of the data obtained it was possible to verify an early growth of respiratory viral infections during the pandemic length of time, which coincided with periods of alleviation of the mitigation measures adopted to control the COVID19 infection spread. Nevertheless, in the period of time that followed the alert status decree due to the pandemic, it was possible to observe a further increase in respiratory viral infections, considerably higher and statistically relevant in comparison with the data previously obtained in this investigation, during and referring to the pandemic period. Therefore, the only viruses holding statistical relevance and value for both periods of time were the RSV, Parainfluenza 3, Coronavirus OC43 and Adenovirus. Henceforth, it is possible to verify that the results obtained are in consonance with other studies performed in identical populations which lead to conclude that these findings may be due to a relaxation in the restrictive measures used to control COVID19 infection spread, as well as a possible decrease in the overall population immunity deriving from periods of confinement in order to control the pandemic by SarsCov2.
PO51
CEREBRAL CREATINE DEFICIENCY SYNDROMES: CLINICAL APLICABILITY OF A LIQUID CROMATOGRAPHY TADEM MASS SPECTROMETRY ASSAY IN A 6 YEAR EVALUATION
Eulália Costa1, Cláudia Fernandes1, Andreia Major1, Tânia Cardoso1, Cristiana Lopes1, Fernando Rodrigues1
1 Centro Hospitalar e Universitário de Coimbra
Introduction: The diagnosis of inborn errors of Metabolism (IEM) is an extraordinary challenge to clinical laboratories in two fundamental aspects: the technological development of valid analytical assays and the diagnosis anticipation, particularly in metabolic diseases with treatment and capability to reverse symptoms in early stages. Cerebral creatine deficiency syndromes (CCDS) are one of these disorders that occur with global development delay, seizures, intellectually disability, movement and behavior disorders, in which early diagnosis and treatment are crucial to prevent clinical manifestations.
Previously, the author has presented an in-house, non-derivatized, method for liquid chromatography tandem mass spectrometry (LC-MS/MS) for the laboratory intervention in CCDC. The method showed good analytical sensitivity and reproductivity but the clinical utility was not evaluated. Here, the authors present a 6-year evaluation for the clinical performance of the assay for quantification of creatine (CR) and guanidinoacetate in urine (GAA).
Aim: To evaluate the diagnostic performance of an LC-MS/MS assay, in the context of CCDS, using a 6-year retrospective analysis. Acceptance criteria defined is sensibility and specificity above 90%.
Materials and Methods: Analysis of the results for CR and GAA quantification in urine, using data from the laboratory informatic system (Clinidata). Diagnostic information was used to verify the specificity (number of true negative) and sensitivity (number of true positive) of the assay. Results for the quality assurance in laboratory testing for IEM (ERNDIM), were also evaluated.
Results: A total of 583 requests were performed in 6 years, for 569 results. Only 9,6% were adults (>16 years), the majority (59,9%) were between 4-16 years old. About 15% (87) needed a second sample for pre-analytical cause exclusion, and were not considered in the evaluation of the performance criteria. 16 patients showed false positive results and 11 revealed true positive results, corresponding to 96,6% of specificity (true negative rate) and 100% of sensibility (true positives). ERNDIM results showed linearity >0.998.
Conclusions: The LC-MS/MS method for quantification CR and GAA in urine used in our laboratory, in the assessment of CCDS, exhibited a very acceptable performance for clinical sensibility and specificity, allowing best clinical management in the IEM approach.
PO52
EVALUATION OF ANTI-PHOSPHOLIPASE A2 RECEPTOR ANTIBODY DETECTION IN SERUM THROUGH ELISA AND IIF TESTING
Diogo Silva1, Teresa Almeida1, Maria João Cardoso1
1 Serviço de Patologia Clínica, Centro Hospitalar Universitário de São João
Introduction: Membranous nephropathy (MN) is the most common cause of primary nephrotic syndrome (NS) in White adults, accounting for up to one-third of biopsied cases of NS. However, serum detection of antibodies anti-Phospholipase A2 receptor (PLA2R) in patients with a compatible clinical presentation and normal kidney function does not require a biopsy to establish diagnosis. In fact, anti-PLA2R antibody measurement is also essential for treatment monitoring and pre-transplant evaluation.
Objective: The main objectives of this study were to compare the two EUROIMMUN commercially available methods of anti-PLA2R antibody detection: ELISA (IgG) and Indirect Immunofluorescence test (IIF) and to evaluate the possibility of combining both tests to develop an algorithm that saves resources and time.
Materials and Methods: All ELISA and IIF results from February 2021 to January 2023 were analysed. IIF results were compared with ELISA results using three cutoff values: 20 RU/ml (the commercially recommended value), 14 RU/ml (the suggested value of KDIGO guidelines) and 2 RU/ml (the detection limit).
Results: A total of 273 samples were analysed using both methods, with 66 positive results in IIF test. The global concordance between ELISA and IIF tests varied according to the cutoff value assumed for the ELISA test: 89,4% for 20 RU/ml, 91,6% for 14 RU/ml and 94,5% for 2 RU/ml. Therefore, the cutoff value that warrants the highest concordance is the detection limit of the ELISA test (2 RU/ml). Among the discordant samples, 7 were ELISA positive and IIF negative and 8 were ELISA negative and IIF positive. Nevertheless, from the latter group only one sample was collected with diagnostic purposes. Thus, a point could be made that an initial ELISA screening test complemented with IIF testing for samples between 2 and 14 RU/ml might be appropriate due to the automation of ELISA testing.
The diagnostic acuity of both tests was not evaluated as most positive samples (87%) were collected to monitor patients who already had a diagnosis.
Conclusion: Additional testing is needed to further evaluate the most appropriate ELISA cutoff and subsequent combination with the IIF to improve labour and cost effectiveness. Furthermore, prospective studies should be conducted to assess both anti-PLA2R antibody tests diagnostic acuity in our population.
PO53
NEW VERSIONS OF SIGMA STRONG REAGENTS INTRODUCED IN ABBOTT’S ALINITY C SYSTEM IN THE YEAR 2022
Ana Ribeiro; Cláudia Bastos; Helena Torres; Mónica Santos; Vera Moscoso; Eugénia Lobo 1
1 CHEDV
Objective: Evaluate the analytical performance of the different chemistry reagents introduced in the market by Abbott, the Sigma Strong (SS) reagents, carrying out comparative studies with those in use in the laboratory in the Alinity c system.
Materials and Methods: The Alinity c system, from Abbott Diagnostics, an automated multiparameter Chemistry analyzer recently launched on the market, uses photometric (endpoint and kinetic assays) and potentiometric methods.
The analytical performance of the Sigma Strong reagents (Uric Acid, Albumin, ALT, Amylase, AST, Total Bilirubin, Total Cholesterol, Creatinine, Lactic Dehydrogenase, Iron, Alkaline Phosphatase, GGT, Total Proteins and Triglycerides) was evaluated by the correlation between the reagent (Current) and the Sigma Strong reagent, in a period of 6 months of the year 2022.
The software used was the Microsoft Excel and the SPSS Statistics version 25.
Informed consent was waived because patients’ samples were used without personal information.
Results: The results of the reagents (Current) were correlated with those of the Sigma Strong reagents, on the Alinity CiC and Ci. There was no statistical difference between the two reagents. Deming’s linear regression was determined for a 95% CI, the correlation coefficient, R2, was calculated from 0.9907 to 0.9989, as well as Pearson’s coefficient from 0.991 to 0.999, for a significance level of 0.01.
Conclusions: The Sigma Strong reagents showed good analytical performance, being practically superimposable to the current reagents. As a result, the new version of Clinical Chemistry reagents released by Abbott® on the Alinity c system, by replacing the current reagent, are expected to improve analytical sensitivity and facilitate the laboratory’s daily routine.
PO54
BIOMARKER OF CHRONIC ALCOHOL ABUSE - CARBOHYDRATE-DEFICIENT TRANSFERRIN. METHODOLOGY VERIFICATION
Filomena Gomes1, Alcina Costa2, Lília Fernandes2, Ana Maria V. da Silva3, Miguel Vasconcelos4, Armandina Miranda2
1 Department of Health Promotion and NCD Prevention, National Institute of Health Dr. Ricardo Jorge, Lisbon, Portugal
2 Department of Health Promotion and NCD Prevention, Nacional Institute of Health Dr. Ricardo Jorge, Lisbon, Portugal
3 Lisbon Alcohol Unit, Ministery of Health
4 Taipas Addiction Center, Lisbon, Ministery of Health
Introduction: Transferrin is a glycoprotein synthesized in hepatocytes that can appear with different isomorphic forms in the plasma, acquiring different levels of sialization (1,2). In a healthy person, penta, tetra and trisial isoforms are detectible in plasma. However, in an alcohol abuse and/or dependence, asialo, monosialo and disialotransferrin isoforms are also present called carbohydrate-deficient transferrin (CDT) (3). This is considered a specific biomarker of alcohol abusive and/or dependence, being useful in the diagnosis and monitoring of this pathology (4).
Aim: Verify compliance with the requirements of the manufacturer of the capillary electrophoresis method in laboratory practice and its suitability in determining the CDT.
Materials and methods: The MiniCap System (Sebia) was used with calibrators traceable to the IFCC international reference procedure and normal and pathological internal control samples. Repeatability and intermediate precision tests were performed on control samples. From participation in External Quality Assessment (EQA) program (5 rounds - 2 samples each), Bias%, Deviation Index (DI) and Total Laboratory Error (TELab) were obtained. The Measurement Uncertainty was calculated by the Top Down Method (combined and expanded with a factor of 1.96), using the internal (CV%) and external (Bias%) quality control results.
Results: In the repeatability tests, normal control samples (n=22, mean = 1.4%) were obtained, CV = 5.7%; for the pathological sample (n=24, mean = 5.4%), CV = 2.2%. In intermediate precision tests for the normal control sample, (n= 12, mean = 1.4%), CV = 6.7%; for the pathological sample (n=12, mean = 5.3%), CV = 4.9%. In samples from EQA program, mean Bias = -1.0% and TELab = 11.5. In the evaluation of the method by DI, 1 satisfactory, 7 good and 2 excellent results were obtained. The obtained Expanded Uncertainty (1.3% ± 0.3) is consistent with that indicated by the manufacturer.
Conclusion: The TELab obtained meets Westgard`s desirable specifications (5), being considered an appropriate methodology for use in laboratory practise for diagnosis. However, it is considered important to monitor the method with Internal Control samples, and participate in EQA programs, as well as periodic evaluation of Quality Indicators.
References
(1) Kohler I, Augsburger M, Rudaz S, et al. - New insights in carbohydrate-deficient transferrin analysis with capillary electrophoresis-mass spectrometry. Forense Science International. 2014; 243: (14-22).
(2) Bean, P. et al. - Semiautomated procedures for evaluation of carbohydrate-deficient transferrin in the diagnosis of alcohol abuse. Clinical Chemistry. 1997; 43, 6: (983-989).
(3) F. Bortolotti; D. Sorio, A. Et al. – Analytical and Diagnostic aspects of Carbohydrate deficient Transferrin (CDT): a critical review over years, 2007 – 2017. Journal of Pharmaceutical and Biomedical Analysis, 2018; 147; (2-12).
(4) I. Jastrzebska, A. Zwolak, M. Szczyrek et al. – Biomarkers of alcohol misure: recent advances and future prospects. Gastroenterology. Rev 2016; 11(2): 78-89
(5) Desirable Specifications for Total Error, Imprecision, and Bias, derived from intra-and inter-individual biologic variation https://www.westgard.com/biodatabase1.htm
PO55
EVALUATION OF 25-HYDROXYVITAMIN D LEVELS IN DXI AND MAGLUMI EQUIPMENT: A COMPARATIVE ANALYSIS
Cristiana Isabel da Silva Oliveira1, Sandrine Mendes1, Ana Cristina Oliveira1, Ana Menezes1, Ana Guerra1, Catarina Lopes1, Martinha Anastácio1, Lina Santos1, Rita Cunha1, Rui Vieira1, Ricardo Castro1
1 Centro Hospitalar de Leiria
Vitamin D, known as the “sunshine vitamin”, has been widely studied and its importance both at bone level and in reducing the risk of cardiovascular diseases, cancerous processes or autoimmune diseases has been well documented.
When absorbed through the skin or ingested, this vitamin is in a biologically inert form and requires two successive hydroxylations to become its active form, 1,25-dihydroxyvitamin D [1,25-(OH)2D], also known as calcitriol. The first hydroxylation occurs in the liver giving rise to the 25-hydroxyvitamin D form [25-(OH)D], also known as calcidiol, and the second occurs in the kidneys to obtain the active form.
There are different methods to determine both forms: 25-(OH)D and 1,25-(OH)2D, however, the only way to know if a person has a vitamin D deficit is by measuring the levels of 25-(OH)D in serum samples.
In clinical practice, there are different instruments on the market for 25-(OH)D detection, including the Maglumi from Snibe® and the DxI from Beckman Coulter®. Both are based on competitive chemiluminescence immunoassay technology.
This study aimed to compare the results obtained between the two equipments using 85 serum samples and ng/mL as reference units.
The data were analysed with the GraphPad Prism 5.0 statistical software, using the student’s t test and obtaining a p value of 0.5516 (p < 0.05).
Based on the results obtained, it is possible to conclude that there are no significant differences between the two automated instruments using the same technology, revealing their efficacy in the determination of 25-(OH)D.
© 2024 Walter de Gruyter GmbH, Berlin/Boston
Articles in the same Issue
- Frontmatter
- Editorial
- SARS-CoV-2 is here to stay: do not lower our guard
- Reviews
- SARS-CoV-2 subgenomic RNA: formation process and rapid molecular diagnostic methods
- Prognostic value of anti-SARS-CoV-2 antibodies: a systematic review
- Presence of SARS-CoV-2 RNA in COVID-19 survivors with post-COVID symptoms: a systematic review of the literature
- Opinion Papers
- Harmonizing the post-analytical phase: focus on the laboratory report
- Blood-based biomarkers in Alzheimer’s disease – moving towards a new era of diagnostics
- A comprehensive review on PFAS including survey results from the EFLM Member Societies
- General Clinical Chemistry and Laboratory Medicine
- Report from the HarmoSter study: different LC-MS/MS androstenedione, DHEAS and testosterone methods compare well; however, unifying calibration is a double-edged sword
- An LC–MS/MS method for serum cystatin C quantification and its comparison with two commercial immunoassays
- CX3CL1/Fractalkine as a biomarker for early pregnancy prediction of preterm premature rupture of membranes
- Elevated S100B urine levels predict seizures in infants complicated by perinatal asphyxia and undergoing therapeutic hypothermia
- The correlation of urea and creatinine concentrations in sweat and saliva with plasma during hemodialysis: an observational cohort study
- Tubular phosphate transport: a comparison between different methods of urine sample collection in FGF23-dependent hypophosphatemic syndromes
- Reference Values and Biological Variations
- Monocyte distribution width (MDW): study of reference values in blood donors
- Data mining of reference intervals for serum creatinine: an improvement in glomerular filtration rate estimating equations based on Q-values
- Hematology and Coagulation
- MALDI-MS in first-line screening of newborns for sickle cell disease: results from a prospective study in comparison to HPLC
- Cardiovascular Diseases
- To rule-in, or not to falsely rule-out, that is the question: evaluation of hs-cTnT EQA performance in light of the ESC-2020 guideline
- Temporal biomarker concentration patterns during the early course of acute coronary syndrome
- Diabetes
- Proteomic analysis of diabetic retinopathy identifies potential plasma-protein biomarkers for diagnosis and prognosis
- Infectious Diseases
- Serum biomarkers of inflammation and vascular damage upon SARS-Cov-2 mRNA vaccine in patients with thymic epithelial tumors
- A high throughput immuno-affinity mass spectrometry method for detection and quantitation of SARS-CoV-2 nucleoprotein in human saliva and its comparison with RT-PCR, RT-LAMP, and lateral flow rapid antigen test
- Evaluation of inflammatory biomarkers and vitamins in hospitalized patients with SARS-CoV-2 infection and post-COVID syndrome
- The CoLab score is associated with SARS-CoV-2 viral load during admission in individuals admitted to the intensive care unit: the CoLaIC cohort study
- Development and evaluation of a CRISPR-Cas13a system-based diagnostic for hepatitis E virus
- Letters to the Editor
- Crioplast® is a reliable device to ensure pre-analytical stability of adrenocorticotrophin (ACTH)
- Falsely decreased Abbott Alinity-c gamma-glutamyl transferase-2 result from paraprotein and heparin interference: case report and subsequent laboratory experiments
- Impact of hemolysis on uracilemia in the context of dihydropyrimidine dehydrogenase deficiency testing
- Value of plasma neurofilament light chain for monitoring efficacy in children with later-onset spinal muscular atrophy under nusinersen treatment
- Analytical evaluation of the Snibe β-isomerized C-terminal telopeptide of type I collagen (β-CTX-I) automated method
- Acute myeloid leukemia with blue-green neutrophilic inclusions have different outcomes: two cases and review of the literature
- Congress Abstracts
- The 10+1 Santorini Conference
- 14th National Congress of the Portuguese Society of Clinical Chemistry, Genetics and Laboratory Medicine
- 15th National Congress of the Portuguese Society of Clinical Chemistry, Genetics and Laboratory Medicine
- ISMD2024 Thirteenth International Symposium on Molecular Diagnostics
Articles in the same Issue
- Frontmatter
- Editorial
- SARS-CoV-2 is here to stay: do not lower our guard
- Reviews
- SARS-CoV-2 subgenomic RNA: formation process and rapid molecular diagnostic methods
- Prognostic value of anti-SARS-CoV-2 antibodies: a systematic review
- Presence of SARS-CoV-2 RNA in COVID-19 survivors with post-COVID symptoms: a systematic review of the literature
- Opinion Papers
- Harmonizing the post-analytical phase: focus on the laboratory report
- Blood-based biomarkers in Alzheimer’s disease – moving towards a new era of diagnostics
- A comprehensive review on PFAS including survey results from the EFLM Member Societies
- General Clinical Chemistry and Laboratory Medicine
- Report from the HarmoSter study: different LC-MS/MS androstenedione, DHEAS and testosterone methods compare well; however, unifying calibration is a double-edged sword
- An LC–MS/MS method for serum cystatin C quantification and its comparison with two commercial immunoassays
- CX3CL1/Fractalkine as a biomarker for early pregnancy prediction of preterm premature rupture of membranes
- Elevated S100B urine levels predict seizures in infants complicated by perinatal asphyxia and undergoing therapeutic hypothermia
- The correlation of urea and creatinine concentrations in sweat and saliva with plasma during hemodialysis: an observational cohort study
- Tubular phosphate transport: a comparison between different methods of urine sample collection in FGF23-dependent hypophosphatemic syndromes
- Reference Values and Biological Variations
- Monocyte distribution width (MDW): study of reference values in blood donors
- Data mining of reference intervals for serum creatinine: an improvement in glomerular filtration rate estimating equations based on Q-values
- Hematology and Coagulation
- MALDI-MS in first-line screening of newborns for sickle cell disease: results from a prospective study in comparison to HPLC
- Cardiovascular Diseases
- To rule-in, or not to falsely rule-out, that is the question: evaluation of hs-cTnT EQA performance in light of the ESC-2020 guideline
- Temporal biomarker concentration patterns during the early course of acute coronary syndrome
- Diabetes
- Proteomic analysis of diabetic retinopathy identifies potential plasma-protein biomarkers for diagnosis and prognosis
- Infectious Diseases
- Serum biomarkers of inflammation and vascular damage upon SARS-Cov-2 mRNA vaccine in patients with thymic epithelial tumors
- A high throughput immuno-affinity mass spectrometry method for detection and quantitation of SARS-CoV-2 nucleoprotein in human saliva and its comparison with RT-PCR, RT-LAMP, and lateral flow rapid antigen test
- Evaluation of inflammatory biomarkers and vitamins in hospitalized patients with SARS-CoV-2 infection and post-COVID syndrome
- The CoLab score is associated with SARS-CoV-2 viral load during admission in individuals admitted to the intensive care unit: the CoLaIC cohort study
- Development and evaluation of a CRISPR-Cas13a system-based diagnostic for hepatitis E virus
- Letters to the Editor
- Crioplast® is a reliable device to ensure pre-analytical stability of adrenocorticotrophin (ACTH)
- Falsely decreased Abbott Alinity-c gamma-glutamyl transferase-2 result from paraprotein and heparin interference: case report and subsequent laboratory experiments
- Impact of hemolysis on uracilemia in the context of dihydropyrimidine dehydrogenase deficiency testing
- Value of plasma neurofilament light chain for monitoring efficacy in children with later-onset spinal muscular atrophy under nusinersen treatment
- Analytical evaluation of the Snibe β-isomerized C-terminal telopeptide of type I collagen (β-CTX-I) automated method
- Acute myeloid leukemia with blue-green neutrophilic inclusions have different outcomes: two cases and review of the literature
- Congress Abstracts
- The 10+1 Santorini Conference
- 14th National Congress of the Portuguese Society of Clinical Chemistry, Genetics and Laboratory Medicine
- 15th National Congress of the Portuguese Society of Clinical Chemistry, Genetics and Laboratory Medicine
- ISMD2024 Thirteenth International Symposium on Molecular Diagnostics


